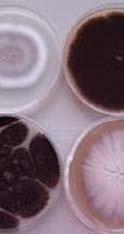
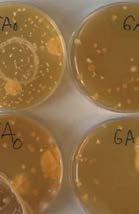
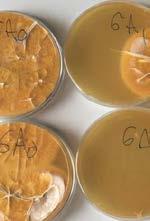
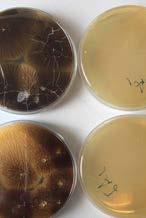
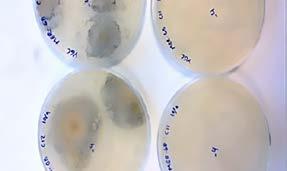

Protection et correction de la vendange
Clarification et extraction enzymatique
Bioprotection des moûts
Optimisation de la fermentation

Stabilisation et affinage
Prévention et correction vis-à-vis des micro-organismes d’altération
Tanins et Bois pour l’œnologie
Filtration
Maitrise de l’hygiène en cave
Vinextase® Œnologie, une marque de Soufflet Vigne
|
|
|
|
|
|
|
|
|
Collection ŒNOLOGIE
EDITORIAL
Nous sommes heureux de vous présenter la seconde édition de notre catalogue Vinextase® dédié à l’OEnologie.
Notre sélection est issue des travaux et essais orientés par notre Conseil Œnologique Vinextase®, constitué d’œnologues et chercheurs référents dans de nombreux vignobles français.
Ces dernières années, notre gamme s’est étoffée grâce à notre étroite collaboration avec Soufflet Biotechnologies, expert dans la Fermentation en Milieu Solide (FMS), qui produit plus de 20% des enzymes œnologiques mondiales, dont une partie est commercialisée par Soufflet Vigne sous sa marque Extasym-Vinextase®.
Grâce aussi aux partenariats que nous avons avec les deux producteurs de biotechnologies oenologiques : Chr. Hansen tout d’abord, leader dans la production de bactéries lactiques, expert dans les process de bioprotection pour vinifier des vins sans sulfite et Fermentis (groupe Lesaffre), 1er producteur mondial de levures et dérivés de levures.
Nos remerciements vont enfin à nos partenariats avec les laboratoires oenologiques, les châteaux, domaines, caves coopératives et négoces référents dans tous les vignobles, qui font confiance à notre expertise et expérimentent nos produits.
Nous avons la conviction que le marché de la consommation des vins s’oriente vers des profils respectueux de la diversité de vos terroirs, aromatiques et toujours plus élégants. Elaborer des vins de qualité nécessitent une maîtrise technique de la vigne jusqu’à la mise en bouteille.
Vinextase® Oenologie oriente, année après année, son sourcing vers des solutions toujours plus naturelles et pures, afin de répondre à vos attentes et celles des consommateurs.
Patrice Lagarde
Chef de marché gamme VIN
Guillaume Comte Responsable Œnologie/Hygiène
Sandrine Berty Œnologue Technico Commerciale Référente Qualité Œnologie et Hygiène
Penser vos vins
Le Conseil Oenologique Vinextase®
Composé de professionnels de la filière vinicole, le Conseil Oenologique Vinextase® est une instance consultative de réflexion, de proposition et d’évaluation en matière scientifique et technique.
Le Conseil Oenologique a pour but d’échanger, de faire des études et des évaluations sur les sujets suivants :
Veille de marché
• Veille réglementaire, mise en oeuvre des politiques nationales ou européennes pouvant avoir des conséquences sur la filière viti-vinicole,
• Veille technologique, démarches des laboratoires par rapport à la recherche et la présentation des nouveaux produits,
• Veille concurrentielle,
• Attentes du marché : problématiques rencontrées, besoins et attentes des oenologues et des vinificateurs, retours d’expériences, tendances du marché en matière d’ingrédients ou d’auxiliaires technologiques intervenant dans le procédé de vinification.
R&D
• Propositions de pistes de recherche, orientations R&D,
• Evaluations et validations de projets de R&D,
• Publications pouvant en découler.
Technique
• Projets de guides techniques et programmes d’actions propres à la Société, relatifs à l’oenologie, la viticulture, la vinification,
• Tout sujet de nature scientifique ou technique relatif à l’activité de la Société et à ses liens avec la filière viti-vinicole.
Gamme Vinextase®

Validation des nouveaux produits, évolutions de la gamme, orientations.
LE CONSEIL ŒNOLOGIQUE EST CONSTITUÉ DE :
Thierry BERGER, Directeur Général, Soufflet Vigne
Benoît BACH, Professeur d’OEnologie, Haute école de viticulture et oenologie à CHANGINS
Sandrine BERTY, Œnologue Responsable Qualité France, Soufflet Vigne

Emmanuel CHARPENTIER, Œnologue, Laboratoire Maison LORON
Bertrand CHATELET, Œnologue, SICAREX Beaujolais
Guillaume COMTE, Responsable OEnologie France, Soufflet Vigne
Yves COUTEL, Chef de Projet R&D OEnologie, Soufflet Biotechnologies
Pascal HENOT, Œnologue, Directeur Laboratoire Enosens
Depuis septembre 2018, j’ai l’honneur et le plaisir d’animer le nouveau Conseil Œnologique Vinextase® . Ce conseil présidé par Michel MOUTOUNET, composé de différents experts-chercheurs de la profession, a pour vocation d’échanger sur l’actualité œnologique, les besoins du terrain et de réfléchir ensemble à l’amélioration de la qualité des produits de la gamme Vinextase® à travers notamment à la mise en place d’expérimentations pilotées par le conseil.
«
Marina BELY
Maitre de Conférences, HDR, Institut des Sciences de la Vigne & du Vin Université de Bordeaux. Animatrice Scientifique du Conseil Œnologie Vinextase®
Patrice LAGARDE, Chef de Marché Vin, Soufflet Vigne
Michel MOUTOUNET, ex-Directeur de Recherche INRA, expert à l’OIV
Sébastien PARDAILLE, Œnologue, Laboratoire NATOLI & Associés
www.vinextase.fr
«
Une présence régionale, un acteur national
Vinextase® Oenologie, marque de Soufflet Vigne, s’appuie sur un maillage régional constitué de 24 magasins Vigne & Vin et 60 techniciens conseillers présents dans la plupart des grands vignobles français.
BOURGOGNE CENTRE LOIRE
CHABLIS
Les Perrières, Route de Lichères 89800 CHABLIS Tél. 03 86 42 12 72 Fax. 03 86 42 48 83 mag.chablis@soufflet.com
MEURSAULT
25, Rue de la gare 21190 MEURSAULT Tél. 03 80 22 17 71 Fax. 03 80 22 07 38 mag.meursault@soufflet.com
SAINT SATUR Chemin du Port 18300 SAINT SATUR Tél. 02 48 54 34 60 Fax. 02 48 54 38 31 mag.sancerre@soufflet.com
CHAMPAGNE
BAR-SUR-AUBE
Rue Louis Desprez, Zone industrielle 10200 BAR-SUR-AUBE
Tél. 03 25 27 10 69 Fax. 03 25 27 25 29 mag.bar-sur-aube@soufflet.com
MARDEUIL
Rue des Pressoirs, ZA La Cerisière 51530 MARDEUIL Tél. 03 26 55 04 29 Fax. 03 26 55 01 86 mag.mardeuil@soufflet.com
POLISOT 12,Rue des Herbues, Hameau de Bellevue 10110 POLISOT Tél. 03 25 29 71 00 Fax. 03 25 29 95 58 mag.polisot@soufflet.com
POILLY
Zone Artisanale - 51170 POILLY Tél. 03 26 61 80 84 Fax. 03 26 61 80 13 mag.poilly@soufflet.com
BORDEAUX
LESPARRE MEDOC 17, cours G. Mendel 33410 LESPARRE MEDOC Tél. 05 56 41 00 31 Fax. 05 56 41 21 42 mag.lesparre-medoc@soufflet.com
CADAUJAC
Chemin des Marguerites 33650 MARTILLAC mag.cadaujac@soufflet.com
MONTAGNE 65 Le Bourg 33570 MONTAGNE Tél. 05 57 74 57 87 Fax. 05 57 74 58 40 mag.montagne@soufflet.com
PAUILLAC ZI de Trompeloup 33250 PAUILLAC Tél. 05 56 59 11 04 Fax. 05 56 59 11 44 mag.pauillac@soufflet.com
GRAND BEAUJOLAIS
CERDON RN 84, Pont de Préau 01450 CERDON Tél. 04 74 39 95 97 Fax. 04 74 39 97 73 mag.cerdon@soufflet.com
VINZELLES 617 route de Juliénas 71680 VINZELLES mag.vinzelles@soufflet.com
REGNIE-DURETTE
Saint Vincent Régnié- Durette 69430 REGNIE-DURETTE Tél. 04 74 04 35 77 Fax. 04 74 69 01 11 mag.regnie-durette@soufflet.com
SAINT LAURENT D’OINGT
Les Plaines - 69620 SAINT LAURENT D’OINGT Tél. 04 74 71 24 30 Fax. 04 74 71 24 28 mag.saint-laurent-doingt@soufflet.com
VILLEFRANCHE-SUR-SAÔNE
Le pont Rouge, CS-20125 LIMAS 69654 VILLEFRANCHE Cedex Tél. 04 74 65 31 04 Fax. 04 74 60 36 27 mag.limas@soufflet.com
LANGUEDOC
PEZENAS
ZA Les Rodettes, Rue Lagarde 34121 PEZENAS Tél. 04 67 31 66 62 Fax. 04 67 31 67 79 mag.pezenas@soufflet.com
CÔTES DU RHÔNE / VAR
BEAUMES-DE-VENISE
129 impasse La Barcillonne, BP 22 84190 BEAUMES-DE VENISE
Tél. 04 90 12 44 12 Fax. 04 90 12 44 11 mag.beaumes-de-venise@soufflet.com
CARPENTRAS
Zone Carpensud, Quartier Terradou, 1730, chemin Saint Gens 84973 CARPENTRAS
Tél. 04 90 60 13 11 Fax. 04 90 60 19 20 mag.carpentras@soufflet.com
COURTHEZON
1801, route de Caderousse 84350 COURTHEZON
Tél. 04 90 70 27 99 Fax. 04 90 70 76 25 mag.courthezon@soufflet.com
PIGNANS
ZA La Lauve, quai Magranon 83790 PIGNANS
Tél. 04 94 00 43 69 Fax. 04 94 00 43 71 mag.pignans@soufflet.com
ROCHEGUDE
La Poterie, Route de Sainte Cécile 26790 ROCHEGUDE
Tél. 04 75 04 80 91 Fax. 04 75 49 16 56 mag.rochegude@soufflet.com
VAISON-LA-ROMAINE
ZA l’Ayguette, Route de Nyons 84110 VAISON-LA-ROMAINE
Tél. 04 90 28 76 52 Fax. 04 90 28 70 81 mag.vaison-la-romaine@soufflet.com
VALREAS
Les Dignerieux, Route d’Orange 84600 VALREAS Tél. 04 90 35 04 81 Fax. 04 90 35 63 07 mag.valreas@soufflet.com
51 10 52 55 88 54 57 689070 21 25 3971 03 87 24 40 33 64 65 09 82 11 66 81 34 12 30 13 83 04 05 06 84 26 07 43 46 15 63 19 42 69 01 38 73 74 32 47 5818 36 37 86 79 49 44 35 50 14 27 76 72 78 95 60 80 62 59 77 91 02 22 17 16 89 CHAMPAGNE Bar-sur-Aube / Mardeuil Polisot / Poilly GRAND BEAUJOLAIS Cerdon Régnié-Durette Saint-Laurent-d’Oingt Villefranche-sur-Saône Vinzelles BOURGOGNE CENTRE-LOIRE Chablis / Meursault Saint-Satur CÔTES DU RHÔNE / VAR Beaumes-de-Venise / Carpentras Courthézon / Pignans / Rochegude Vaison-la-Romaine / Valréas LANGUEDOC Pézenas BORDEAUX Cadaujac / Lesparre Médoc / Martillac / Montagne / Pauillac
SOMMAIRE
Diagnostics et Suivis en amont de la vinification
Protection et correction de la vendange
Produits sulfureux et alternatifs au SO2
Enzymes et solutions enzymatiques
Bioprotection des moûts
Fermentation alcoolique Fermentation malolactique
Produits de collage
Tanins et dérivés du bois
Correction et stabilisation des vins
Agents filtrants
Hygiène de cave
VINIFLORA® : BACTÉRIES LACTIQUES ET LEVURES PRÉ-FERMENTAIRES EXPERTISE EN BIO-PROTECTION
ACTEUR MONDIAL DE RÉFÉRENCE EN LEVURES ET SOLUTIONS DE FERMENTATION
UNIQUE PRODUCTEUR FRANÇAIS DE SOLUTIONS ENZYMATIQUES OENOLOGIQUES (ex-LYVEN)
LAISSEZ VOS CARACTÈRES
exprimer

Avec ses prestigieux partenaires, Vinextase Oenologie © , marque exclusive de Soufflet Vigne, renouvelle le marché des produits œnologiques en proposant une palette de solutions adaptées à toutes les couleurs du vin et mise résolument sur l’innovation pour accompagner votre créativité et révéler tous les potentiels de vos millésimes.

www.vinextase.fr
VINEXTASE ŒNOLOGIE, UNE MARQUE DE
s’
! Crédit photo Fotolia Cris 06-2018

DIAGNOSTICS ET SUIVIS EN AMONT DE LA VINIFICATION 6 | Ferti Oeno : Dès la vigne, travaillez l’œnologie de vos vins 7 | Bacchimeter : Mesurez la maturité à la parcelle et déterminez vos dates de vendanges 8 | Analyses spécifiques : L’analyse au service du produit 9 | Vitivalor© Solutions : Optimiser la qualité de vos vins en fonction des besoins du marché AMONT DE LA VINIFICATION | 5
TANINS & DÉRIVÉS DU BOIS
PRODUITS DE COLLAGE
FERM. MALO.
FERM. ALCOOL.
BIO-PROTECT. DES MOÛTS
ENZYMES
PRODUITS SULFUREUX
PROTECTION CORRECTION VENDANGES
CORRECT. ET STAB. DES VINS
FILTRATION
DES VINS HYGIÈNE
DIAGNOSTICS ET SUIVIS EN AMONT DE LA VINIFICATION

Itinéraire Ferti - Oeno
Dès la vigne, travailler l’œnologie de vos vins
Soufflet Vigne, fort de son expertise viticole et oenologique, met en oeuvre son savoir-faire technique pour travailler, dès la vigne, les vins sur le plan oenologique. Nos travaux sur l’application d’engrais foliaires à des stades clefs nous ont permis d’obtenir un moût de qualité et d’améliorer le potentiel organoleptique du raisin. Fertech ExpresSIon (utilisable en Agriculture Biologique) permet l’augmentation significative de l’azote assimilable dans les moûts, donc de favoriser leur fermentescibilité.
FERTECH EXPRESSION
Complexe d’oligo-éléments et d’extrait de prêle. Permet de favoriser la fermentation des moûts (augmentation de l’azote organique et de l’azote assimilable). Permet une meilleure expression du profil aromatique des vins. Contient un extrait d’algues pour un meilleur étalement de l’engrais.
Qu’est-ce que Fertech ExpresSIon ?
FERTECH ExpresSIon est un engrais foliaire, complexe d’oligo-éléments associé à des algues.
Son originalité repose sur l’incorporation d’extrait végétal de prêle des champs (Equisetum arvense)
La prêle est le plus souvent utilisée en viticulture pour son rôle constitutif, structurant, mais aussi pour la régulation du mécanisme de transpiration en situation de stress hydrique.
Les essais que nous avons conduits (cf. ci-contre) ont montré des effets œnologiques originaux induits par cet engrais foliaire : l’utilisation de FERTECH ExpresSIon permet une amélioration significative de l’azote organique des moûts et donc de l’azote assimilable, sans apport d’azote ou de soufre sur le feuillage. FERTECH ExpresSIon permet donc de favoriser la fermentation des moûts, et a priori la synthèse de précurseurs aromatiques, sans prendre de risque comme : - les brûlures liées à l’application d’azote et de soufre en conditions chaudes ; - le développement du Botrytis par une augmentation de la vigueur.
La prêle est une plante très riche en Silice. Ses extraits de matière sèche peuvent contenir jusqu’à 16% de Silice contre 1% en moyenne pour les autres plantes. Cependant cette proportion peut être variable (Hopkins, 2010). Très peu d’études scientifiques existent sur l’analyse des effets réels de la silice sur le comportement de la vigne. La silice peut avoir un impact sur la photosynthèse, car ses microcristaux aideraient à capter plus de lumière chez d’autres espèces, selon la littérature. Ainsi, la plante ne serait pas obligée de développer autant son système végétatif pour intercepter les rayons du soleil, bien que cette hypothèse reste à vérifier.
Consulter notre site internet www.engraisfertech.fr ou demander plus d’informations auprès de votre interlocuteur Soufflet Vigne.
AZOTE ASSIMILABLE - COEFFICIENT NORMALISÉ
- COEFFICIENT NORMALISÉ
ORGANIQUE - COEFFICIENT NORMALISÉ

une marque de CONTACT AGRICULTURE BIOLOGIQUE Dose conseillée 2 3 applications consécutives partirde la fermeture de grappe à la dose de 2 L/ha Conditionnement Bidon 5L FERTECH ExpresSIon Complexe d’oligo-éléments et d’extrait de prêle Engrais CE Engrais CE solution pour pulvérisation foliaire Densité 1,12 – pH 5,8 Fer [Fe] 7,84 g/L Manganèse [Mn] 5,72 g/L Zinc [Zn] 5,70 g/L Bore [B] 3,45 g/L 1,19 g/L Molybdène [Mo] 0.12 g/L Extraitsd’alguespourunmeilleurétalementdel’engrais COMPOSITION est en engrais constitué sur la base de Fertech Fruit, et complété par un extrait végétal de prêle des champs (Equisetum arvense). La prêle est le plus souvent utilisée en viticulture pour son rôle constitutif, structurant, mais aussi pour la régulation du mécanisme de transpiration en situation de stress hydrique. Au-delà de cela, les essais que nous avons conduit nous ont permis d’obtenir des résultats originaux : l’utilisation de FERTECH EXPRESSION permet une amélioration significative de l’azote organique des moûts et donc de l’azote assimilable, sans apport d’azote ou de soufre sur le feuillage. FERTECH EXPRESSION permet donc de favoriser la fermentation des moûts, et priori la synthèse de précuseurs aromatiques, sans prendre de risque comme les brûlures liées à l’application d’azote le développement du Botrytis par une augmentation de la vigueur. QU’EST-CE QUE FERTECH EXPRESSION ? AZOTE ORGANIQUE COEFFICIENT NORMALISÉ Fertech ExpresSIon NH4 COEFFICIENT NORMALISÉ Int.deconf.95% AZOTE ASSIMILABLE COEFFICIENT NORMALISÉ Azote Soufre de Silice contre 1% en moyenne pour les autres plantes. Cependant cette proportion peut être variable (Hopkins, 2010). Très peu d’études scientifiques existent sur l’analyse des effets réels de la silice sur aideraient capter plus de lumière chez d’autres espèces, selon littérature. Ainsi, la plante serait cette hypothèse reste vérifier. Permet de favoriser la fermentation des moûts (augmentation de l’azote organique et de l’azote assimilable). Permet une meilleure expression du profil aromatique des vins. Contient un extrait d’algues pour un meilleur étalement de l’engrais. Crédits Groupe Soufflet Thinkstock Fotolia 02/10/2018
AGRICULTURE BIOLOGIQUE Utilisable en conformément au règlement CE 834/2007 Int. de conf. 95% AZOTE
Fertech ExpresSIon Référence Azote - Soufre 0 0,2 0,4 0,6 0,8 -0,2 Int. de conf. 95% NH4
Fertech ExpresSIon Référence Azote - Soufre -0,2 0 0,2 0,4 0,6 -0,4 Int. de conf. 95%
Fertech ExpresSIon Référence Azote - Soufre -0,2 0 0,2 0,4 0,6 0,8
AMONT DE LA VINIFICATION 6 |
Bacchimeter


Mesurer la maturité à la parcelle et déterminer vos dates de vendanges
Exclusivité Soufflet Vigne lancée par Vinextase Oenologie lors du Vinitech de Bordeaux, lauréat des Trophées de l’Innovation 2018, le Bacchimeter est un capteur piéton connecté qui permet de mesurer les anthocyanes contenues dans la pellicule du raisin sur cépages rouges destinés à la vinification en vins rouges tranquilles, directement à la parcelle, de manière non destructive et géoréférencée. Les résultats sont consultables immédiatement sur un smartphone et via notre plateforme web.


Mesure des anthocyanes avec le BACCHIMETER Transmission et consultation des données sur l’application mobile FA en temps réel

Analyse et visualisation des données sur : analytics.force-a.com


UNE APPRÉCIATION IMMÉDIATE ET NON DESTRUCTIVE DE LA MATURITÉ DU RAISIN
L’analyse de la maturité phénolique par les anthocyanes, est le suivi de leur accumulation et de leur concentration dans la pellicule.
La variation spatiale du taux
d’anthocyanes dans les grappes d’une même parcelle traduit des différences de maturité et son évaluation permet l’identification de zones homogènes: cette connaissance est la base d’une
prise de décision immédiate. Le suivi temporel des anthocyanes permet d’aider à déterminer la date de vendange.
Découvrer le bacchimeter en vidéo
Télécharger la documentation commerciale
Trophées de l’Innovation 2018 LAURÉAT TROPHÉE DE BRONZE
http://bit.ly/bacchimeter-demo http://bit.ly/Bacchimeter-doc
AMONT DE LA VINIFICATION | 7
ET SUIVIS EN AMONT DE LA
Service analyses spécifiques
L’analyse au service du produit
Dans le cadre du suivi des fermentations (FA ou FML) réalisées avec nos produits œnologiques ou de nos prescriptions techniques à la vigne, nous pouvons vous proposer des analyses spécifiques avec la collaboration de nos partenaires laboratoire d’analyses / conseils. Votre interlocuteur régional est à votre disposition pour toute information à ce sujet.

Type d’analyses
CONTROLE DE MATURITE
Paramètres analysés
Glucose + Fructose, TAP, AT, pH, Acide Malique, Acide Tartrique, Acide Gluconique, Glycérol, Acide citrique, Acidité volatile, Azote Ammoniacal, Azote a-aminés, Azote assimilable total, Potassium, Masse volumique, Delta C13
ANALYSE DE MOÛT EN CUVE Glucose + Fructose, TAP, TAV, AT, pH, Acide Malique, Acide Tartrique, Acide Gluconique, Glycérol, Acide citrique, Acidité volatile, Azote Ammoniacal, Azote a-aminés, Azote assimilable total, Potassium, Masse volumique, Delta C13, SO2 Libre, SO2 Total
ANALYSE COMPLETE VIN Glucose + Fructose, TAV, Acidité volatile, AT, pH, Acide malique, Acide lactique, SO2 Libre, SO2 Total, SO2 Actif, CO2, IPT
Codes
188534
188535
188536
ANALYSE AZOTE ALPHA AMINE
Azote alpha aminé par colorimétrie (forme d’azote nécessaire aux bactéries lactiques)
NB : cette analyse ne se réalise que sur vin fini
188537 ANALYSE LEVURES - BACTERIES Viabilité des levure et bactérie acétique et lactique réf. 188538
réf.
réf.
réf.
réf.
DIAGNOSTICS
VINIFICATION AMONT DE LA VINIFICATION 8 |
vitivalor
Optimiser la qualité de vos vins en fonction des besoins du marché
VITIVALOR® SOLUTIONS propose à la filière une offre de plus de 40 solutions concrètes et éprouvées, couvrant l’ensemble des besoins stratégiques et opérationnels d’une exploitation.
Les experts de Vitivalor® Solutions interviennent sur les 6 piliers de la vie des exploitations et notamment sur les activités vinicoles : l’élaboration de nouveaux processus, de pratiques et d’installations de matériel qui répondent aux nouveaux besoins et ambitions de qualité de production de la profession.
• Définir vos itinéraires œnologiques ;
CAP VINICOLE
• Adapter vos infrastructures et vos matériels en conformité avec les cahiers des charges ;

• Harmoniser les process aux types de vin recherchés, dans le respect de vos terroirs.

Parce qu’élaborer un grand vin nécessite expertise et méthode, les consultantsoenologues Vitivalor® accompagnent leurs clients de manière technique et opérationnelle, pour définir et mettre en oeuvre l’ensemble des itinéraires de vinification sur toutes les étapes de l’élaboration du vin.

VITIVALOR® SOLUTIONS, une offre 360°
Audit technique vinicole Ingénierie du chai Conduite de vinification Gestion administrative vinicole Gestion du plan d’hygiène Démarche HACCP CAP Vinicole Audit technique du vignoble Conduite de projet de restructuration du vignoble Conduite des travaux viticoles et des chantiers de vendanges Observations, analyses et conseils techniques Gestion administrative viticole CAP Viticole Audit organisation et réglementation Gestion RH Administratif général Accompagnement à la certification des prestataires de services Formations des équipes internes/externes Gestion sécurité (Document Unique) CAP Organisation CAP Commercial Audit commercial Accompagnement marketing Création et design Accompagnement commercial Administration des ventes Projet d’oenotourisme CAP Stratégie CAP Régie CAP Viticole CAP Environnement CAP Vinicole CAP Commercial CAP Organisation Audit de l’exploitation Accompagnement stratégique Business Plan Plan d’investissements Définition d’itinéraires techniques Conseils de mise en marché CAP Stratégie Audit environnemental Accompagnement à la mise en conformité Accompagnement aux certifications environnementales Montage des dossiers de subventions CAP Environnement
SOLUTIONS WWW.VITIVALOR.COM
Nos clients témoignent : sur Youtube #vitivalor #cap #vinicole
AMONT DE LA VINIFICATION | 9
Révélons la personnalité de vos vins !
A l’heure où la personnalisation est un élément capital de la commercialisation de vos vins, Vinextase Packaging vous propose une vaste gamme de matières sèches assurant un positionnement cohérent de vos vins par rapport à vos marchés.

BOUTEILLES
Un choix de bouteilles et des gammes riches, du cœur de marché au haut-de-gamme, offrant des modèles traditionnels ou plus atypiques.
HABILLAGE
Une gamme complète de capsules de surbouchage, capsules à vis, coiffes, cire… L’habillage est l’un des points essentiels du conditionnement, de la communication et de la différenciation ; garants de l’inviolabilité du produit et qui véhiculent l’image d’un vin, à l’impact certain en linéaire.

ETIQUETTES

De nombreuses possibilités de personnalisation, sans quantités minimums grâce à l’impression numérique, avec de larges possibilités techniques de finition qui mettent en valeur vos vins : dorures à chaud, vernis gonflants… avec des formes et/ou découpes 100% sur mesure.
BOUCHONS
Une large gamme de bouchons, adaptée à chaque type de vin, tranquille ou effervescent : bouchons naturels, techniques, synthétiques…














Le choix d’un bouchon se fait en fonction des problématiques de bouchage, du rendu esthétique recherché, des caractéristiques techniques et de sa durée de vie.
EMBALLAGE
Du carton bouteille à l’étui en passant par la caisse bois ou l’outre à vin, découvrez les nombreux produits et possibilités d’impressions toujours plus abouties, avec des minimums de fabrication de plus en plus accessibles, notamment grâce à la technologie de l’impression numérique.
Contactez votre commercial habituel, il est à votre écoute pour réaliser des projets de matières sèches à votre image.Vinextase Packaging, une marque de Soufflet Vigne

PROTECTION ET CORRECTION DE LA VENDANGE
12 | Inertage à la glace carbonique
14 | Sucre et stabilité du vin
17 | Acidification et désacidification
La protection des vendanges est une étape importante dans l’élaboration d’un vin. Après de longs mois de soins à la vigne, le transport peut compromettre la qualité du vin. Les températures élevées de ces dernières années ont augmenté de façon notable les risques d’oxydation des jus (dégradation de la couleur et perte aromatique).
L’utilisation de neige carbonique ou glace carbonique, assure le transport de la vendange dans des conditions optimales. Sur certains millésimes, selon la maturité des raisins récoltés, des défauts d’acidité jouent fortement sur l’équilibre du vin. Pour y remédier, il est possible (selon la règlementation) d’acidifier ou de désacidifier le moût.
| 11
AMONT DE LA VINIFICATION
PROTECTION CORRECTION VENDANGES
TANINS & DÉRIVÉS DU BOIS
PRODUITS DE COLLAGE
FERM. MALO.
FERM. ALCOOL.
BIO-PROTECT. DES MOÛTS
ENZYMES
PRODUITS SULFUREUX
CORRECT. ET STAB. DES VINS FILTRATION DES VINS HYGIÈNE
Inertage des pressoirs et des cuves Glace Carbonique
GLACE CARBONIQUE
La détente rapide au contact de l’air du dioxyde de carbone liquide pressurisé génère de la neige carbonique. Comprimée, celle-ci devient alors de la glace carbonique, aussi appelée anhydride carbonique solide, dioxyde de carbone solide, ou encore glace sèche. La glace carbonique ainsi obtenue est solide et à une température de -78,5 °C et se sublime en ne laissant aucun résidu.
Les +
• Protection des raisins.
• Réduction de SO2
• Inertage
Conditionnement(s)
Pellets au kg réf. 127716 Sticks au kg réf. 166332
Applications et doses
Inertage : 2 kg dégage 1 m3 de CO2 Refroidissement du moût : 0,65 kg de glace pour refroidir 1 hl de moût de 1°C (selon conditions d’utilisation).


12 | PROTECTION ET CORRECTION DE LA VENDANGE INERTAGE
Contenants pour la glace carbonique
BOX FIXE 370 KG
BOX FIXE 600 KG

Les +
• 450 L et 80 kg à vide.
• Epaisseur 60 mm.
• 370 kg de bâtonnets. réf. HG500
Conditionnement(s)
BOX MOBILE AVEC
ROULETTES 350 KG
Les +
• 420 L et 90 kg à vide.
• Epaisseur 130 mm.
• 350 kg de bâtonnets. réf. Bac420

Conditionnement(s)
BOX MOBILE POUR CHARIOT ÉLÉVATEUR

Les +
• 800 L et 230 kg à vide.
• Epaisseur 130 mm.
• 600 kg de bâtonnets. réf. K800

Conditionnement(s)
Les +
Bacs compartimentés, réduit le ratio air/glace et limite la sublimation.
Conditionnement(s)
190 kg réf. EPS-Box1 300 kg réf. EPS-Box 2
AVEZ-VOUS PENSÉ À…
GANTS TRAVAUX FROID COLDPRO

• Taille 8 à 11
• Idéal pour la manipulation de la glace carbonique réf. 144188 + taille
LUNETTES MASQUE KEMILUX

Lunettes masque de sécurité pour protection des yeux contre les risques mécaniques, chimiques et la poussière.

- Monture en pvc souple, 3 aérateurs, anti projection.
- Maintien par élastique de serrage réglable.
- Ecran en polycarbonate incolore. réf. 164623
PELLE GLACE CARBONIQUE
Pelle a grain 1,5 L réf. 125111
DEMI-MASQUE 3M
- Contre les vapeurs organiques, inorganiques, gaz acides et ammoniac.
- Indispensable pour se protéger lors de l’utilisation d’anhydride sulfureux. réf. 133488

| 13 INERTAGE
Sucre et stabilité du vin
Le sucre résiduel peut être une source d’instabilité en bouteille. Si le vin est mal stabilisé microbiologiquement, il est possible qu’une refermentation se déclenche, ce qui entraîne un trouble dans la bouteille.
Le vin devient gazeux et perd ses arômes de fraîcheur, la pression fait ressortir totalement ou partiellement le bouchon, le vin devient inconsommable. Il est important d’assurer une bonne fermentation alcoolique pour avoir une bonne consommation des sucres du moût.
 Voir page 49 [Fermentation Alcoolique]
Voir page 49 [Fermentation Alcoolique]
AVEZ-VOUS PENSÉ À…
RÉFRACTOMÈTRE MASTER-TAL
Réfractomètre à main permettant de mesurer l’alcool probable d’un moût simplifié avec fiabilité et rapidité.
Gamme de mesure : 0-25° AP.
Précision : +/-0,2%, 0 à 40 % Brix +/-0,5 % réf. 116754
RÉFRACTOMÈTRE
HUMER HI96816

Permet la mesure rapide de l’alcool probable des moûts (étalonnage conforme au règlement CEE du 17/09/90). Etanche IP65, portable, il est muni d’une compensation automatique de température de 10 à 40°C. Résultat en moins de 2 secondes. Précision 0,2% Vol. Rinçage à l’eau potable. réf. 164667

RAPPEL DE LA RÈGLEMENTATION
Type de vins Teneur en sucre
Vins secs < 2 g/l
Vins demi-secs jusqu’à 20 g/l
Vins moelleux jusqu’à 40 g/l
Vins liquoreux > 40 g/l
Les préconisations de Vinextase® Œnologie : Assurer une bonne gestion de la fermentation alcoolique afin d’éviter tout risque de sucres résiduels et les défauts associés. Pour plus d’information, rendez-vous page 49 (Fermentation alcoolique).
RÉFRACTOMÈTRE NUM PEN WINE
Fonctionnant selon le principe de la mesure de l’indice de réfraction, il permet de mesurer avec rapidité, précision et une excellente reproductibilité l’alcool probable en % vol. des raisins. réf. 164344
RÉFRACTOMÈTRE
VIGNERON 0-25%
Réfractomètre, modèle vigneron, corps métal, livré en coffret avec pipette et tournevis de réglage. réf. 130052


14 | PROTECTION ET CORRECTION DE LA VENDANGE SUCRE
Chaptalisation
Sucre
Le sucre est extrait de la betterave sucrière ou de la canne à sucre par une succession d’étapes séparatives : lavage, découpage, diffusion, filtration, évaporation, cristallisation, essorage puis séchage. Il doit être stocké à l’abri de l’humidité et des variations thermiques.
SUCRE CRISTAL
Le SUCRE CRISTAL est un sucre blanc correspondant au standard de la qualité n°2 définie par la réglementation de l’Union Européenne. Le SUCRE CRISTAL est issu de la cristallisation de la molécule de Saccharose présente dans la betterave sucrière. Cette qualité constitue la référence internationalement reconnue pour du sucre à usage alimentaire. Issu de productions françaises (betteraves et sucreries), non issu d‘OGM, il ne contient aucun produit allergène.
Conditionnement(s)
SUCRE CRISTALLISE N1 25kg réf. 12639825
SUCRE CRISTALLISE N1 1000kg réf. 126398BA
SUCRE CRISTALLISE N2 25kg réf. 12639625
SUCRE CRISTALLISE N2 50kg réf. 12639650
SUCRE CRISTALLISE N2 1000kg réf. 126396BA
SUCRE DE CANNE
Le PURE CANNE est issu de la cristallisation de la molécule de Saccharose présente dans la canne à sucre. Le PURE CANNE est un sucre correspondant à un haut de gamme standard de la qualité n°2 définie par la réglementation de l’Union Européenne. Il répond à des normes sévères destinées à satisfaire des utilisateurs à la recherche d’un haut niveau qualitatif pour leurs approvisionnements, notamment en termes de couleur. Non issu d‘OGM, il ne contient aucun produit allergène.
Conditionnement(s)
SUCRE CANNE BLANC RAFFINE 25kg réf. 12639425
SUCRE CANNE BIO BLC 25kg réf. 14166425


SUCRE CANNE BIO BLC 1100kg réf. 141664LU
SUCRE CANNE ROUX 25kg réf. 12639725
SUCRE CANNE BIO ROUX 25kg réf. 12639225
SUCRE CANNE BIO ROUX 1100kg réf. 126392LU
AVEZ-VOUS PENSÉ À…
CUVE AGITATION (POUDRE ET LIQUIDE)
Bac mélangeur sur roues ou sur socle. Bac monté sur socle thermo formé avec passage pour transpalette, avec vidange totale 40 mâcon et vanne à boule, piquage pour mélangeur à 45° en 40 mâcon.
réf. 187555 - Cuve de 500 L réf. 187554 - Cuve de 300 L

Les +
• Permet une préparation rapide des produits solides (sucres, bentonites, colles) à ajouter au vin sans grumeaux.
• Stockage et manipulation plus aisée qu’avec une baste.

| 15 CHAPTALISATION
Moût Concentré Rectifié (MCR)
Le Moût Concentré Rectifié (MCR) est un sirop de sucres de raisin obtenu à partir de jus de raisin dont on a extrait tous les composants « non sucres » (acides, polyphénols, arômes, minéraux, vitamines). Après clarification par filtration, les jus sont décolorés par passage sur résines absorbantes. L’élution du jus clair décoloré, sur résines échangeuses d’ions (anioniques et cationiques) permet ensuite d’éliminer tous les constituants du raisin, excepté les sucres, l’eau et le fruit.
La dernière étape réside dans la concentration de la solution sucrée obtenue, sous pression réduite, à une température de 70°C maximum conformément aux exigences de la réglementation bio. Le MCR est par conséquent inodore, incolore et pur ; sa composition est de 50 % de glucose et 50 % de fructose.
MCR 65° BRIX BIO
Les préconisations de Vinextase® Œnologie :
Enrichissement des moûts :
• Environ 2.5 litres sont nécessaires pour augmenter de 1 degré 100 litres de moût.
• Se conformer à la réglementation en vigueur (portant sur l’organisation commune du marché vitivinicole) pour connaître les limites d’enrichissement de l’aire d’appellation concernée.
• Edulcoration des vins biologiques.
• Elaboration de liqueurs de tirage et/ou d’expédition biologique.
Degré Brix = g de sucre pour 100g de liquide
MCR PASTEURISÉ
La forme liquide du MCR bio garantit une meilleure rationalisation des différentes étapes du processus d’élaboration des produits : • facilité de pompage, de transfert et de stockage, • réduction des aires de stockage, • allègement de la manutention,
suppression de la fonte des sucres cristallisés, • solubilité supérieure à celle du saccharose,
amélioration du contrôle de fabrication, • possibilité de travailler en continu, • qualité et standardisation des produits
En édulcoration et en enrichissement, son origine endogène de la vigne en fait un agent idéal. Il améliore la qualité gustative des produits tout en permettant de conserver le caractère propre et la stabilité du vin. En agroalimentaire, il permet de garantir l’image fruit et le côté naturel.
Exhausteur d’arômes, il amplifie la saveur des produits. 52.25 degré AP, 879.8 g de sucre par litre.

Conditionnement(s)
Bidon de 20L réf. 19583420
Container de 1000L réf. 195834U1
MCR RECTIFIÉ 65° BRIX 52.25 degré AP, 879.8 g de sucre par litre.
Conditionnement(s)
Citerne vrac complète de 190/200 hl réf. 195832
63° BRIX
A la différence du MCR traditionnel 65°Brix, le moût concentré rectifié, MCR 63° Brix pasteurisé est dilué avant d’être pasteurisé. Ces deux étapes permettent de garantir des critères microbiologiques et d’allonger la DLUO en limitant les risques de cristallisation. 50.12 degré AP, 843.8 g de sucre par litre.
Conditionnement(s)
Bidon de 20L réf. 19583320
Container de 1000L réf. 195833U1
•
•
16 | PROTECTION ET CORRECTION DE LA VENDANGE MCR
Acidification et désacification des moûts
ACIDE TARTRIQUE
L’acide tartrique est un correcteur d’acidité sur moût et vin. Augmentation de l’acidité de titration et de l’acidité réelle (diminution du pH).
Les +
• Correcteur d’acidité sur moûts et vins.
• Issu de co-produit de vinification.
• Made in France
ACIDE MALIQUE
L’acide malique est un acidifiant utilisé pour corriger l’acidité des moûts et des vins. Il s’agit de l’acide malique D/L. Il apporte des sensations de fraîcheur et contribue à l’équilibre gustatif du vin. Il renforce également les caractéristiques aromatiques fruitées.
Les +
• Correcteur d’acidité sur moûts et vins.
Applications et doses
Moûts ou vins : 0,5 - 2,5 g/l
Conditionnement(s)
1 kg réf. 13733301
25 kg réf. 13733325
ACIDE LACTIQUE
L’acide lactique est un acidifiant utilisé pour corriger l’acidité des moûts et des vins. Il constitue une alternative à l’acide tartrique, mais son ajout provoque une légère baisse du pH. L’acide lactique qui est ajouté aux moûts et aux vins se maintient après la stabilisation par le froid et peut même être ajouté avant la mise en bouteille sans provoquer de problèmes de précipitation.
Les +
• Correcteur d’acidité sur moûts et vins.
Applications et doses
Moûts ou vins : 0,5 - 2,5 g/l
Conditionnement(s)
25 kg réf. 16328925
BICARBONATE DE POTASSIUM
Applications et doses
1,26 ml d’acide lactique augmente l’acidité d’un vin de 1 g/l exprimé en acide tartrique.
Conditionnement(s)
25 kg réf. 16461825
Le bicarbonate de potassium est un produit désacidifiant qui modifie le pH et baisse l’acidité. Ajouté au moût ou au vin, il réagit avec l’acide tartrique et produit du bitartrate de potassium qui est insolubilisé de façon efficace.
Applications et doses
Moûts ou vins : 0,2 - 1 g/l
Les +
• Correcteur d’acidité sur moûts et vins.
Conditionnement(s)
1 kg réf. 16329101 5 kg réf. 16329105 25 kg réf. 16329125
AVEZ-VOUS PENSÉ À…
PH MÈTRE

- Boîtier étanche
- Affichage simultané du pH et de la température
- Étalonnage en 2 points au clavier avec reconnaissance automatique des tampons
- Indicateur de stabilité pour une mesure et une lecture sûre
- Fonction HOLD pour figer une mesure à l’écran
- Guide permanent des fonctions essentielles à l’écran
- Indicateur de charge de piles et alerte en cas de piles trop faibles pour une mesure précise
- Remplacement des piles simple et rapide réf. 192487
Déclaration obligatoire aux autorités compétentes au plus tard 48h après la première opération de la campagne
L’acidification et l’enrichissement s’excluent mutuellement sur le même produit.
L’acidification et la désacidification s’excluent mutuellement sur le même produit sauf dans les cas cités dans l’annexe VIII Partie I du règlement (CE) n°1308/2013
| 17 ACIDIFICATION DÉCACIDIFICATION

PRODUITS SULFUREUX ET ALTERNATIFS AU
| 19 Vinextase® Oenologie propose une gamme de produits sulfureux destinés à assurer la bonne conservation des vins, à l’abri de l’oxydation et des altérations microbiennes. Vinextase® Oenologie propose aussi une gamme de produits permettant de réduire vos apports en sulfites, pour répondre aux nouvelles attentes des consommateurs. 20 | Les formulations liquides 21 | Les formulations poudres 22 | L’anhydride sulfureux gazeux 24 | Les alternatives aux produits sulfureux
SO2
AMONT DE LA VINIFICATION
PRODUITS SULFUREUX
PROTECTION CORRECTION VENDANGES
TANINS & DÉRIVÉS DU BOIS
PRODUITS DE COLLAGE
FERM. MALO.
FERM. ALCOOL.
BIO-PROTECT. DES MOÛTS
ENZYMES
CORRECT. ET STAB. DES VINS
FILTRATION DES VINS HYGIÈNE
Les formulations liquides
BISULFITE DE POTASSIUM
Bisulfite de potassium en solution aqueuse à différentes concentrations. Les densités du SO2 et du vin étant différentes, le sulfitage en cuve nécessite un remontage d’homogénéisation ou un brassage au gaz inerte.

Les +
• Antioxydant : possède des propriétés réductrices, neutralise l’oxygène et empêche l’oxydation.
• Antioxydasique : détruit les oxydases et donc permet d´éviter les casses oxydasiques.
• Antimicrobien : exerce une activité inhibitrice sur les levures, les bactéries lactiques et les bactéries acétiques.
Applications et doses
Bisulfite de K à 6% titrant 60g/litre de So2
Bisulfite de K à 10% titrant 100g/litre de So2
Bisulfite de K à 18% titrant 180g/litre de So2
Conditionnement(s)
Bisulfite 6% : 5 kg réf. 16457605 22 kg réf. 16457622
Bisulfite 10% :
5 kg réf. 13751905
24 kg réf. 13751924
1 100kg réf. 137519DV
Bisulfite 18% : 5 kg réf. 13751805
25 kg réf. 13751825
1 200kg réf. 137518DL
BISULFITE D’AMMONIUM
Bisulfite d’ammonium en solution aqueuse à différentes concentrations.
Les +
• Apporte au moût ou à la vendange non seulement du SO2, mais aussi de l’azote ammoniacal indispensable au bon déroulement de la fermentation.
Applications et doses
Bisulfite d’ammonium 150 titrant 150 g/litre de So2
Bisulfite d’ammonium 200 titrant 200 g/litre de So2
Conditionnement(s)
Bisulfite d’ammonium 150 : 24 kg réf. 16458124

Bisulfite d’ammonium 200 : 24 kg réf. 16458024
AVEZ-VOUS PENSÉ À…
IODOLYSER
Détermination du SO2 libre et total.
Entièrement automatique, il permet d’enchaîner facilement les analyses avec une précision et une reproductabilité remarquables.
S’adapte à tout type d’échantillon. réf. 176875
20 | PRODUITS SULFUREUX ET ALTERNATIFS AU SO2 LIQUIDES
Les formulations poudres
METABISULFITE DE POTASSIUM
En tant qu’antioxydant, il possède des propriétés réductrices, neutralise l’oxygène et empêche l’oxydation.
Les +
La formulation poudre du métabisulfite est pratique pour un sulfitage :
• sur vendange à la parcelle ;
• asepsie des cheminées de cuves ;
SOUFRE PROTECT 2G
Comprimés effervescents de métabisulfite de potassium et de bicarbonate de potassium pour le sulfitage des vins.

Les +
• Pas de dépôt au fond de la barrique.
• Dosage précis et homogénéisation efficace.
Applications et doses 2 g pour ajouter environ 1 g de SO2
• pour réajustement des petits contenants (barriques). 1 kg réf. 16327701 25 kg réf. 16327725
Conditionnement(s)
Applications et doses
Chaque comprimé libère 2 g de SO2 pur
Conditionnement(s)
Boîte de 48 comprimés réf. 18325248
| 21 POUDRES
L’anhydride sulfureux GAZ
Vinextase® Oenologie propose le concept MILANE GAZ TP : du SO2 pur comprimé dans des bouteilles en acier alimentaire, de différentes capacités, équipées de tubes plongeurs (TP).


PETITES BOUTEILLES MILANE OENO AVEC TUBE PLONGEUR
Bouteilles équipées d’un robinet doseur avec dégazage continu facilitant le remplissage des jauges en polypropylène spécifiques au SO2, de différentes capacités (30g, 70g, 450g et 800g) éprouvées aux chocs (pression d’éclatement 31 bar).


Diffusion rapide et homogène : le SO2 en passant de son état gazeux à liquide « se détend » : son volume est multiplié par 300. Ne nécessite pas d’homogénéisation comme dans le cas des solutions de Bisulfite.
Applications et doses
Dosage en grammes lecture directe (jauge graduée ou par pesée avec une balance)
Conditionnement(s)
Milane S2 - 2kg de SO2 pur réf. 126102 Milane S5 - 5kg de SO2 pur réf. 131667

Milane S11 - 11kg de SO2 réf. 181361

Les +
• Pureté≥ 99.99
• Origine : Soufre naturel E220.
• Sécuritaire : tube plongeur permettant le remplissage de la jauge sans retourner la bouteille.
• DLU (des bouteilles) > 3 ans.
• Bouteilles recyclées.

• Conformes aux normes (EN 13322, EN 12862, EN 9936).
• Traçabilité des bouteilles.
DOSEUR ET DOSEUR/ DÉGAZEUR
Doseur/dégazeur continu universel pour tous types de
PACK DOSEUR
Kit de démarrage anhydride sulfureux en bouteilles.
Contient deux jauges (70 et 500g), équipées d’une vanne-robinet et dégazeur, ainsi que tuyaux norprène 3M avec diffuseur-lesteur et un masque de protection. réf. 183299
Milane S2 réf. 126102 Milane S5 réf. 131667 Milane S11 réf. 181361 Vanne inox à boisseau régulatrice Zapette de contrôle avec lecture écran (Kilogramme) Tuyau de diffusion GAZ SO2 souple à plonger dans la cuve, longueur 5 m OPTION POSSIBILITÉ DE TRAVAILLER AVEC CANNE D’INJECTION Diffuseur/lesteur inox Grand modèle Balance Valise PACK COMPLET BALANCE MILANE S11
bouteilles. Utilisation seulement pour bouteilles sans tube plongeur.
22 | PRODUITS SULFUREUX ET ALTERNATIFS AU SO2 GAZ
GRANDES BOUTEILLES MILANE OENO AVEC TUBE PLONGEUR
Bouteilles équipées d’un robinet double phase, gaz et liquide, à transfert sécurisé grâce au système ClipsavTM équipé d’un clapet anti-retour. Le process de notre fabricant inclut une surpression des bouteilles à l’azote à 7-8 bar afin de faciliter leur utilisation.

Applications et doses
Par pesée négative avec balance (valise ou chariot)
Conditionnement(s)
Milane S24 24kg de So2 pur réf. 126086
Milane S63 63kg de So2 pur réf. 126087
Milane S500 500kg de So2 pur réf. 133660
Les + • SO2 pur. • Sécuritaire : tube plongeur ; - raccord ClipSavetm ; - auto-obturant.


- Cadres de stockage de 8 à 16 bouteilles de 63kg. Adaptation complète à l’outil de travail existant : par le haut avec un diffuseur lesteur, par le bas canne de remontage avec embout perforé ou flexible (vanne coudée).
SYSTÈME CLIPSAVTM
CHARIOT DOSEUR INOX AVEC MILANE S24
ATTENTION : plus la température de stockage des bouteilles est basse, plus la pression dans la bouteille baisse ce qui peut engendrer des difficultés de remplissage des siphons-doseurs ou des jauges. Le stockage des bouteilles entre 15 et 25°C est optimal.
AVEZ-VOUS PENSÉ À…
KIT BONDE À BRETT
Un nouveau procédé physique et oenologique simple et efficace pour protéger vos vins des dérives phénoliques et pour assurer une pérennité de vos barriques et foudres. Les protocoles d’utilisation seront différents suivant le niveau de pollution de vos barriques en Brettanomyces :
• Pour un traitement d’entretien de vos barriques avant l’entonnage du vin nouveau : après détartrage à l’eau chaude ou à la vapeur, apport de 5 g/barrique et maintien 1 à 3 mn.

• Pour un traitement curatif sur une barrique très fortement polluée en Brettanomyces : après détartrage à l’eau chaude ou à la vapeur, apport de 10 g/barrique et maintien 10 mn.
KIT BARRIQUE réf. 177406 KIT FOUDRE réf. 192090
DOSEURS ET JAUGES POUR BOUTEILLES SO2 70g ref : 131668 30 g réf. : 136551 800g ref : 191188 450g ref : 131669
| 23 GAZ
Alternatives aux produits sulfureux
Le SO2 a une action à la fois antioxydante et antimicrobienne précieuse pour le vinificateur tout au long de la vinification. Avec le progrès et la maîtrise, nombreux sont ceux qui vinifient sans SO2 pour baisser le taux de sulfite total du vin. D’autres vont même jusqu’à s’en passer pour produire des vins sans sulfites ajoutés. Cela demande de la technique en affinant le suivi des vins (analyses, dégustations) tout en utilisant des alternatives soit antioxydantes soit antimicrobiennes pour éviter toute oxydation ou déviation préjudiciables à la qualité finale pour le consommateur. Ces alternatives (liste non exhaustive) peuvent être répertoriées :
Actions (directes ou indirectes)
Physique
Chimique
Biologique
Antioxydantes
Désoxygénation, Inertage, carbonication, hyperoxygénation des moûts)
Tanins, acide ascorbique
Bioprotection, LSI riches en glutathion
ACIDE SORBIQUE OU SORBATE DE POTASSIUM
Le sorbate de potassium est un adjuvant qui, lorsqu’il est utilisé dans les vins en association avec le SO2, permet d’en réduire les doses.
Il permet également d’éviter les problèmes de refermentation. Dose max légale 200mg/l
Applications et doses
10 - 25 g/hl
Les +
• Inhibiteur levurien utilisé pour éviter le développement des refermentations des vins contenant des sucres fermentescibles.
Antimicrobiennes
Filtration stérile, Flash-pasteurisation, thermorégulation (le froid limite la croissance de certaines flores), traitement UV
DMDC, sorbate de potassium, chitosane, acides (effet indirect SO2 plus actif, et limite la croissance de certaines flores selon pH)
Lyzozyme, Bioprotection
Conditionnement(s)
1 kg réf. 16327601
LYZOSYME
Extrait de blanc d’oeuf de poule.
Applications et doses
Retardement de la F.M.L :
- 5 à 15 g/hL sur volume final en macération carbonique : Traiter à l’encuvage.
- 15 à 30 g/hL sur volume final en vendange éraflée : Traiter en cours de FA (Densité voisine de 1030).
Blocage de la F.M.L : 30 à 50 g/hL
Blocage de la piqûre lactique : 20 à 30 g/hL de vin Stabilisation après F.M.L : 15 à 30 g/hL de vin
Les + Sur moût et sur vin : - contrôle de la croissance et de l’activité des bactéries responsables de la fermentation malolactique dans le moût (bloquer ou décaler la fermentation malolactique, éviter la piqure lactique) ; - réduction des doses de dioxyde de soufre.
Conditionnement(s)
NOUS CONSULTER
Actions antimicrobiennes MICROSAN Pour plus d’informations, rendez-vous page 114 100g réf.194358T1 Conditionnement(s) AGENTS FILTRANTS >> rendez-vous page 117 BIOPROTECTION DES MOÛTS >> rendez-vous page 33 24 | PRODUITS SULFUREUX ET ALTERNATIFS AU SO2 ALTERNATIVES
Actions antioxydantes
ACIDE ASCORBIQUE
Puissant antioxydant autorisé en ajout sur vin, réservé principalement à la mise en bouteilles et sur vin de consommation rapide. En effet, il doit être utilisé en synergie avec le SO2 et le vin ne doit plus avoir d’oxydation forte après l’ajout d’acide ascorbique.
Dose max légale : 150 mg/l
Applications et doses 10 - 25 g/hL
Les +
• Il assure la préservation des arômes et des composés phénoliques.
VINIFLORATM
FROOTZEN
Pour plus d’informations, rendez-vous page 37
SPRINGAROM
Conditionnement(s)
Dose pour 50 hL réf. 183330
Dose pour 100 hL réf. 140817
AVEZ-VOUS PENSÉ À…
Conditionnement(s)
1 kg réf. 16327501 25 kg réf. 16327525
Pour plus d’informations, rendez-vous page 59 1 kg réf. 14075101
GLACE CARBONIQUE
Pour plus d’informations, rendez-vous page 12
TANEX ANTI-OX
Pour plus d’informations, rendez-vous page 103
Conditionnement(s)
Conditionnement(s)
Pellets au kg réf. 127716
Sticks au kg réf. 166332
Conditionnement(s)
1L (blanc) réf. 19307201
1L (rouge) réf. 19307301
APPAREIL DE DÉSOXYGÉNATION
Dosage en ligne du CO2 et de l’azote dans les vins. Supervise en temps réel la température et le débit du produit, ainsi que la pression du gaz injecté. Garantit la précision du dosage en toutes circonstances : en circuit fermé, durant un soutirage ou durant la mise en bouteillles.

NOUS CONSULTER

| 25 ALTERNATIVES
Rappel de réglementation : SO2 DANS LES VINS : LES TENEURS LIMITES

LE SO2 OU DIOXYDE DE SOUFRE OU ANHYDRIDE SULFUREUX reste un intrant essentiel dans le vin, puisqu’à l’heure actuelle aucun additif œnologique ne peut se substituer complètement à son usage. Il demeure un produit toxique et dangereux pour les utilisateurs qu’il convient de manipuler avec précaution.
Types de vin Teneur en sucres Couleurs Teneur maximale en SO2 total dans le vin en mg/l
Vins tranquilles sucres < 5g/L
sucrs > 5g/L
Vins de liqueurs sucres < 5g/L
sucres > 5g/L
Vins effervescents qualité
Exceptions :
Vins spéciaux à 300, 350 et 400 mg/L voir règlement 606/2009
Etiquetage obligatoire : « CONTIENT DES SULFITES » à partir d’une teneur en SO2 total de 10 mg/L
LABEL BIO :

Réduction des doses de SO2 total maximales autorisées :
50 mg/L sur les vins secs < 2g/L (glucose + fructose)
30 mg/L sur les autres vins
LABEL NOP :
Maximum 100 mg/L de SO2 total dans le produit fini
Source : IFV (MAJ 21/03/2019)
200 150
250 200
150
200
185 235
•
•
26 | PRODUITS SULFUREUX ET ALTERNATIFS AU SO2 SO 2 : TENEURS LIMITES
ENZYMES
29 | Clarification et débourbage
30 | Macération pelliculaire en blanc et rosé et extraction de la couleur et des tanins lors de la macération en rouge
31 | Process spécifique de thermovinification et flash-détente
32 | Élevage sur lie des grands vins et amélioration de la filtrabilité des vins issus de vendange botrytisée
Le Groupe Soufflet, par l’intermédiaire de sa Division Soufflet Biotechnologies (ex-Lyven), développe en France des préparations enzymatiques à partir de cultures de microorganismes non OGM destinées à l’œnologie, la transformation des fruits, la brasserie et la distillerie. Ses programmes de recherche, développés dans le Centre de Recherche et d’Innovation Soufflet, permettent le développement de préparations de haute technicité adaptées aux exigences de qualité des produits.
| 27
AMONT DE LA VINIFICATION
ENZYMES
PRODUITS SULFUREUX
PROTECTION CORRECTION VENDANGES
TANINS & DÉRIVÉS DU BOIS
PRODUITS DE COLLAGE
FERM. MALO.
FERM. ALCOOL.
BIO-PROTECT. DES MOÛTS CORRECT. ET STAB. DES VINS FILTRATION DES VINS HYGIÈNE
Enzymes
Soufflet Biotechnologies développe des formulations enzymatiques spécifiques afin d’optimiser les process oenologiques, en adéquation avec les attentes du terrain. Elles sont produites en fermentation en milieu solide (FMS) sur substrat de son de blé ou de pulpe de betterave. La FMS offre un spectre plus large d’activités secondaires en lien avec la structure plus complexe des milieux de fermentation.


Ce procédé naturel est moins énergivore que la fermentation en milieu liquide permettant notamment une consommation d’eau moindre dans son procédé de fabrication.
Propagation de souche
Fermentation en milieu solide

Extraction/ Purification
Formulation
FERMENTATION

Les préconisations de Vinextase® Œnologie :
Bentonite : les enzymes sont inactivées de manière irréversible par la bentonite. Un traitement éventuel à la bentonite doit toujours être effectué après l’ajout d’enzymes ou bien une fois la bentonite éliminée.

SO2 : les enzymes ne sont pas sensibles aux doses usuelles de SO2 (<300mg/l) Toutefois, il est recommandé de ne pas mettre en contact direct les enzymes et les solutions sulfureuses
Température et pH : les préparations sont actives à des températures de 0°C à 65°C et au pH du vin de 2,9 à 4.
EN SAVOIR PLUS SUR LA
EN MILIEU SOLIDE : Solutions pour la clarification des jus : Sur YouTube : #groupesoufflet #clarification #jus 28 | ENZYMES ENZYMES
Clarification et débourbage
EXTASYM CLARIFICATION POUDRE
Dépectinisation des moûts de blanc ou rosé difficiles et la clarification des vins rouges de presse.
Applications et doses
Très concentrée même à faible dose
1 à 2 g/hl en débourbage
2 à 3 g/hl sur vins de presses
Conditionnement(s)
100g ref. 115137T1 500g ref .115137T5
Les +
• Excellente tolérance à l’acidité du moût.
• Forte réduction du volume des bourbes chargées en pectines.
• Permet une réduction notable des traitements physiques tels que la centrifugation, la filtration et de la température des systèmes de refroidissement.
• Active même à basses températures : entre 0 et 5°C – Son activité augmente avec la température jusqu’à 65°C max. Activité optimale au pH du vin.
• Ne contient aucune activité cellulase ajoutée.
EXTASYM CRYSTAL
Dépectinisation rapide des moûts de blanc ou rosé.
Les +
Applications et doses
Poudre : très purifiée 1 à 2,5 g/hl en débourbage
EXTASYM CLARIFICATION LIQUIDE
Dépectinisation des moûts de blanc ou rosé difficiles et la clarification des vins rouges de presse.

Applications et doses
Très concentrée même à faible dose 0,5 à 1ml/hl en débourbage 2 à 3 ml/hl sur vins de presse ou en flottation
Conditionnement(s)
1kg ref. 14145801 5kg ref. 14145805 20kg ref. 14145820
Les +
• Excellente tolérance à l’acidité du moût.
• Forte réduction du volume des bourbes chargées en pectines.
• Permet une réduction notable des traitements physiques tels que la centrifugation, la filtration et de la température des systèmes de refroidissement.
• Active même à basses températures : entre 0 et 5°C – Son activité augmente avec la température jusqu’à 65°C max. Activité optimale au pH du vin.
• Ne contient aucune activité cellulase ajoutée.
EXTASYM CLARIF ACTIV PLUS
Les +
• Purifiée en activité cinnamyl esterase, elle préserve des risques de déviations aromatiques. 100g ref.129215T1 500g ref 129215T5
EXTASYM FLOTTATION
Dépectinisation des moûts de flottation.
Conditionnement(s)
Améliore la rapidité du débourbage et de la filtrabilité des vins de façon générale.
Applications et doses
Liquide : 1 à 2,5 ml/hl en débourbage 2 à 3 ml/gl sur vins de presse
Applications et doses
Liquide : 1 à 3 ml/hl selon :
- température du moût (1ml/hl si moût <10°C)
- richesse en pectine (test de dépectinisation) Temps d’action 1 h à 1h30
Les +
• Préparation d’enzymes pectolytiques sélectionnée pour diminuer rapidement la viscosité des moûts et améliorer le rendement de la flottation.
• Activité optimale entre 10 et 50°C.
• Active avant flottation ou centrifugation. 1kg ref.18323101
Conditionnement(s)
Conditionnement(s)
• Rendement en jus et tassement des bourbes optimisées. 250g ref. 181176MC 1kg ref.
5kg ref.
AGRICULTURE BIOLOGIQUE Utilisable en conformément au règlement CE 834/2007
AGRICULTURE BIOLOGIQUE Utilisable en conformément au règlement CE 834/2007
AGRICULTURE BIOLOGIQUE Utilisable en conformément au règlement CE 834/2007
18117601
18117605
AGRICULTURE BIOLOGIQUE Utilisable en conformément au règlement CE 834/2007
| 29 ENZYMES
Macération pelliculaire en blanc et rosé et extraction de la couleur et des tanins lors de la macération en rouge
EXTASYM MP POUDRE
Pressurage des raisins pour la production des blanc et rosés aromatiques.
Les +
• Accroit l’intensité aromatique, notamment les notes fruitées.
• Des rendements en jus de goutte plus élevés et plus efficaces à basse pression.
• Purifiée en activité Cinnamyl esterase, elle préserve des risques de déviations aromatiques.
Applications et doses
Poudre : très concentrée même à faible dose 2 à 3 g/100kg de vendange
EXTASYM MACÉRATION
POUDRE
Extraction des matières colorantes et des tanins, spécifique de la vinification en rouge.
Applications et doses
Poudre : très concentrée 2 à 5 g/100kg de vendange
Conditionnement(s)
100g ref. 115138T1 500g ref. 115138T5
Conditionnement(s)
100g ref. 129216T1 500g ref. 129216T5
EXTASYM MP LIQUIDE
Pressurage des raisins pour la production des blanc et rosés aromatiques.
Les +
• Accroit l’intensité aromatique, notamment les notes fruitées.
• Des rendements en jus de goutte plus élevés et plus efficaces à basse pression.
• Purifiée en activité Cinnamyl esterase, elle préserve des risques de déviations aromatiques.
Applications et doses
Liquide : 2 à 3 ml/100kg de vendange
EXTASYM MACÉRATION LIQUIDE
Conditionnement(s)
20 kg ref. 17806320
Les +
• Optimise la macération et augmente le rendement en jus.
• Extraction sélective des tanins les moins astringents.
• Purifiée en activité Cinnamyl esterase, elle préserve des risques de déviations aromatiques.
Extraction des matières colorantes et des tanins, spécifique de la vinification en rouge.
Applications et doses
Liquide : 1 à 3 ml/100kg de vendange
Les +
• Optimise la macération et augmente le rendement en jus.
• Extraction sélective des tanins les moins astringents.
• Purifiée en activité Cinnamyl esterase, elle préserve des risques de déviations aromatiques.5kg ref. 17408205
Conditionnement(s)
Les atouts d’Extasym Macération
Nous utilisons Extasym Macération pour 11 000 hectolitres de vendange saine.
Notre choix s’est porté sur cette enzyme pour diverses raisons :
- c’est un produit épuré en cinnamyl estérase.
- elle favorise l’extraction de couleurs au même niveau que les références du marché.
- cette enzyme a un bon rapport qualité/prix.
- la production (fermentation) de l’enzyme est réalisée en milieu solide, favorise son action, avec des activités secondaires.
- sa formulation liquide est plus simple à utiliser, pas de risque pour l’opérateur lors de la préparation.
Par ailleurs, Extasym Macération, de part son process de fabrication, est plus écologique et plus économique. Nous utilisons Extasym Clarification Active + pour les vins de presse car elle permet une plus grande filtrabilité.

AGRICULTURE BIOLOGIQUE Utilisable en
AGRICULTURE
BIOLOGIQUE Utilisable en conformément au règlement CE 834/2007
AGRICULTURE
BIOLOGIQUE Utilisable en conformément au règlement CE 834/2007
AGRICULTURE BIOLOGIQUE Utilisable en
« Extasym Macération, un produit répondant aux attentes du marché : sécurité pour l’opérateur, facilité d’utilisation, production locale (France), production valorisant des sous-produits agricoles.»
Vignobles de Larose, St-Estèphe et Haut-Médoc - Benjamin Bruneau, Responsable du pôle Vin des Vignobles de Larose
ENZYMES30 | MACÉRATION PELLICULAIRE
Process spécifique de thermovinification et flash-détente
EXTASYM THERMO POUDRE
Clarification des moûts issus de Thermovinification et de Flash-Détente.
Les +
• Réduction de la viscosité et de la turbidité du moût.
• Augmente le rendement en jus et facilite le pressurage.
Applications et doses
Poudre : temp <65°C
2 à 3 g/100kg de vendange
Conditionnement(s)
100g ref. 115139T1 500g ref. 115139T5
EXTASYM
THERMO ACTIV +
Très stable, à la chaleur elle reste active plus longtemps dans le processus de thermovinification.
Une extraction des jus plus importante et plus rapide.
Applications et doses
Liquide :
1 à 3 ml / hl temp <65°C
Les +
• Temps de contact 10 minutes avant filtration ou pressurage.
• Dépectinisation complète dès 20 minutes de contact.
Conditionnement(s)
250g ref. 187662TD 1kg ref. 18766201 20Kg ref. 18766220
EXTASYM THERMO LIQUIDE
Clarification des moûts issus de Thermovinification et de Flash-Détente.
Les +
• Réduction de la viscosité et de la turbidité du moût.
• Augmente le rendement en jus et facilite le pressurage.
Applications et doses
Liquide :
1 à 3 ml / hl temp <65°C
Conditionnement(s)
5kg ref. 13756805
Les préconisations de Vinextase® Œnologie :
Double enzymage lors des macérations préfermentaires à chaud :
Si les premières études sur les conséquences du changement climatique montrent que le réchauffement a globalement favorisé la qualité du vin dans certaines régions, la poursuite de ce réchauffement peut devenir problématique, avec des soucis d’accès à l’eau en cas de sécheresse, le développement de maladies émergentes, ou encore l’érosion des sols du fait d’évènements orageux violents… Découvrez les résultats d’essai d’un double enzymage permettant d’agir plus rapidement sur la qualité des moûts.
Lire la suite : https://www.vinextase.com/Services/Les-conseils-de-nosexperts/Impact-d-un-double-enzymage-en-vinification-prefermentaire-a-chaud

AGRICULTURE BIOLOGIQUE Utilisable en conformément au règlement CE 834/2007
AGRICULTURE BIOLOGIQUE Utilisable en conformément au règlement CE 834/2007
AGRICULTURE BIOLOGIQUE Utilisable en conformément au règlement CE 834/2007
| 31 THERMOVINIFICATION ET FLASH-DÉTENTE
ÉLEVAGE SUR LIE AMÉLIORATION FILTRABILITÉ
Élevage sur lie des grands vins et amélioration de la filtrabilité des vins issus de vendange botrytisée

EXTASYM ELEVAGE
Préparation enzymatique issue de culture pure de bétaglucanases issue de Trichoderma harzianum
Accélération du phénomène de lyse des levures : favorise la libération des glucanes de la paroi lors de l’élevage sur lies.
Applications et doses
Elevage sur vins blancs 2 à 3 g/hl
Elevage sur vins rouges 3 à 5 g/hl
Remise en suspension des lies nécessaires quotidiennement la première semaine, puis 2 à 3 fois par semaine.
Conditionnement(s)
Dégradation des glucanes sécrétés par Botrytis Cinerea.
Applications et doses
Vendange altérée : 2 à 3 g/hl
RAPPEL
Gestion du SO2 de la vendange botrytisée :
Les +
• Enrichissement en polysaccharides et mannoprotéines apportant rondeur et volume en bouche.
• Accélération de l’autolyse des levures.
• Diminution de la durée de l’élevage.
• Amélioration de la filtrabilité.
Les +
• En hydrolysant les longues chaînes de glucanes β1-3 et β1-6 glucanases elle améliore considérablement la filtrabilité du vin.
• Elle diminue le taux de micro-organismes.
• Un test Glucane auprès de votre laboratoire permet de s’assurer de l’efficacité du traitement enzymatique.
- Trier les lots sains de ceux qui sont altérés, soit par la sélection parcellaire, soit sur table de tri.
- SO2 : fractionner le sulfitage et inerter régulièrement les raisins, le jus et la couverture du jus par du CO2, en complément du SO2

- Un enzymage approprié au pressoir, sur blanc et rosé, permet de maintenir le même rendement d’extraction en baissant la pression, le but étant de diminuer le contact entre le jus et la pellicule. Débourber à moins de 100NTU.
- Le chauffage de la vendange à partir de 65°C détruit la laccase.
- Utiliser des systèmes de transfert de la vendange évitant la trituration du raisin afin de limiter l’apparition du glucane.
100g ref 140653T1 500g ref 140653T5
ENZYMES32 |
BIOPROTECTION DES MOÛTS
| 33 Vinextase® Oenologie avec son partenaire Chr.Hansen, leader mondial dans la production de levures non-Saccharomyces et bactéries lactiques pour l’œnologie, répond aux besoins du marché en solutions innovantes : - pour produire des vins plus respectueux de l’environnement et du consommateur ; - pour préserver et/ou augmenter le potentiel organoleptique ; - pour s’adapter aux nouveaux procédés œnologiques. 34 | Bioprotection 35 | Les levures non-Saccharomyces 47 | Les bactéries lactiques
AMONT DE LA VINIFICATION
BIO-PROTECT. DES MOÛTS
ENZYMES
PRODUITS SULFUREUX
PROTECTION CORRECTION VENDANGES
TANINS & DÉRIVÉS DU BOIS
PRODUITS DE COLLAGE
FERM. MALO.
FERM. ALCOOL. CORRECT. ET STAB. DES VINS FILTRATION DES VINS HYGIÈNE
Bioprotection et traitement des moûts
La bioprotection est l’utilisation de ferments de spécialité dans l’agroalimentaire pour lutter contre l’altération des aliments.
En œnologie, la bioprotection se fait selon deux principes liés à l’activité des espèces sélectionnées.
EXCLUSION COMPÉTITIVE
La souche sélectionnée peut contrôler le développement d’autres espèces/souches de micro-organismes dans certaines conditions qui sont liées :
1. A la sélection de la souche (physiologie et méthode de production)
2. A la concentration de cellules actives après inoculation (jusqu’à une limite spécifique d’action en UFC/ml)
3. A la capacité de croissance de la souche
Les populations minoritaires ralentissent quand la population dominante atteint son maximum (compétition pour des ressources communes limitées ou par l’espace).
PRODUCTION DE COMPOSÉS
La souche sélectionnée est capable de produire des composés spécifiques qui limitent le développement d’espèces d’altération (ex : Acetobacter sp.).
Cet effet est « souche dépendant », il peut être par exemple :
1. Production d’éthanol (cas des levures Saccharomyces cerevisiae)
2. Production d’acides organiques (variation du pH du milieu)
3. Production de peptides : mycocines, bactériocines, facteur killer…
De nombreuses bactéries, si elles sont bien adaptées, inhibent la croissance d’autres par des interactions physiques.

Ces micro-organismes ont en plus de leur effet bioprotecteur un impact positif sur le moût à différents niveaux. Selon la souche utilisée, le vinificateur peut trouver un intérêt dans ces produits pour traiter son moût avant la traditionnelle fermentation alcoolique.
• Organoleptiques :
- Révélation variétale à partir de précurseurs aromatiques (thiols, terpènes) ;
- Production de composés aromatiques fermentaires (esters) ;
- Diminution de production de composés négatifs (acide acétique, etc).
• Hédoniques
- Equilibre acidité/alcool par production d’acides organiques à partir de sucres fermentescibles ;
- Production et libération de composés impactant la structure en bouche (mannoprotéines, polysaccharides).
Vinextase® Oenologie a sélectionné pour vous les produits de notre partenaire Chr. Hansen spécialiste de la bioprotection. Dans notre collection vous retrouverez différents micro-organismes (levures et bactéries) pour la bioprotection et le traitement de vos moûts.
inhibiteur
micro-organismes
(moisissures,
Effet
Population en
Temps
Culture protectrice Contaminants Contaminants
levures, bactéries) + Culture protectrice Décélération simultanée : la culture bioprotectrice à haute concentration limite la prolifération en contaminants
34 | BIOPROTECTION ET TRAITEMENT DES MOÛTS BIOPROTECTION
Les Levures non-Saccharomyces
La fermentation alcoolique est la première étape biologique de la vinification. Saccharomyces cerevisiae est l’espèce de levure majoritaire responsable de ce procédé biochimique.
Il existe cependant lors de fermentations naturelles des espèces dites non‑Saccharomyces appartenant par exemple aux genres Torulaspora, Candida, Lachancea, Hanseniaspora, Metschnikowia, Pichia qui initient la FA (dans l’encadré vert) et qui vont être supplantées progressivement par l’espèce S.cerevisiae (différentes souches, encadré orange).
Ces souches non Saccharomyces selon le genre et l’espèce peuvent être souvent positives organoleptiquement pour le vin (Torulaspora, Lachancea, Pichia, Metschnikowia) ou négatives (Candida, Hanseniaspora).

Dans la pratique il est indispensable de les associer avec une levure de type Saccharomyces cerevisiae pour assurer la fermentation alcoolique.
Dynamique des espèces présentes lors d’une fermentation alcoolique spontanée Goddard MR. 2008. Ecology : 2077-2082
0 5 10 15 20 25 30 35 Millions of cfu 0 2 4 10 6 12 8 14 16 18 20 22 24 Ethanol (%) and temperature (°C) 1 4 7 10 13 16 192 5 8 11 14 17 203 6 9 12 15 18 Jours | 35 LES LEVURES NONSACCHAROMYCES
ET TRAITEMENT DES MOÛTS
LES LEVURES NONSACCHAROMYCES
Viniflora®
Levures spécifiques pour l’oenologie
Notre gamme de levures de spécialités repose sur des souches naturellement présentes dans les moûts et spécifiquement sélectionnées pour apporter une touche différente aux vins. Elle donne la possibilité au vinificateur de travailler les fermentations alcooliques de manière radicalement différente de ce qui se faisait jusqu´alors grâce : • à une collection de souches de levures non-Saccharomyces, développées pour leurs activités spécifiques, • à une technologie d´ensemencement direct (FrootZen™) qui permet de s´affranchir de la production de levains, afin d’éviter toutes les erreurs commises lors des étapes de réhydratation et d´acclimatation des levures sèches actives (erreurs sur les conditions de stockage, les températures de réhydratation, la composition de l´eau utilisée pour réhydrater, les chocs thermiques lorsque la température du levain et celle du moût à ensemencer diffèrent de plus de 10°C …).
techniques Applications suggérées Résumé
LEVURES NON-SACCHAROMYCES
CONCERTO™
` Compétition forte, vis-àvis des souches du milieu
` Intensité et complexité aromatique
` Pour éviter un départ trop rapide en fermentation alcoolique
` Peu ou pas d’acidité volatile produite pendant la fermentation
` Bio-protection naturelle contre les levures sauvages, les bactéries et moisissures lorsqu’utilisé au dosage recommandé
` Production d’acides gras à chaîne moyenne qui apportent des notes de ferments sauvages, d’une façon maîtrisée
` Souche de levure Lachancea thermotolerans
` Production d’acide lactique
` Arômes spécifiques de fruits noirs
` Réduction d’alcool
` Souche de levure Pichia kluyveri
` Idéal pour les vins méditerrannéens/ climats chauds
` Acidification naturelle, meilleur équilibre en bouche
` Maximise l’extraction de “précurseurs d’arômes”
FROOTZEN™
` Forte production de thiols volatiles
` Inoculation directe
` Souche de levure Torulaspora delbrueckii
` Réduit l’astringence, arrondit la sensation en bouche
` Pas de réhydratation nécessaire, permet de gagner du temps
` Idéal durant les macérations préfermentaires à froid (MPF)
PRELUDE™
` Production de mannoprotéines et des polysaccharides
` Arômes spécifiques de caramel / pâtisserie
` Plus de rondeur en bouche
` Parfait avec les rouges/blancs fermentés ou vieillis en fût
MÉLANGE DE LEVURES SACCHAROMYCES ET NON-SACCHAROMYCES
` Mélange prêt à l’emploi de S. Cerevisiae, T. delbrueckii, K. thermotolerans
MELODY™
` Ampleur en bouche, équilibre, complexité
` Résistance aux hauts degrés alcooliques (jusqu’à 16% vol)
` Permet de gagner du temps et de simplifier les étapes d’ensemencement (all in one concept)
` Parfait avec les vins blancs fermentés ou vieillis en chêne (chips ou fût)
` S. Cerevisiae intégrée complètera la fermentation
AGRICULTURE BIOLOGIQUE Utilisable en conformément au règlement CE 834/2007
1ère partie FA 2e partie FA Produit Caractéristiques Conséquences
FA : Fermentation Alcoolique Arômes Longueur Fraîcheur / Acidité Ampleur en bouche Arômes Longueur Fraîcheur / Acidité Ampleur en bouche Arômes Longueur Fraîcheur / Acidité Ampleur en bouche Arômes Longueur Fraîcheur / Acidité Ampleur en bouche 36 | BIOPROTECTION
VINIFLORA FROOTZENTM
Souche pure de Pichia kluyverii, la formulation est à ensemencement direct, le pain de levures est congelé et stocké à -45°C dans un surgélateur. C’est une levure de voile très peu ou pas fermentaire qui possède des activités enzymatiques intéressantes pour la révélation ou production de composés aromatiques (thiols, esters).

Les +
• Bioprotection du moût (transport des raisins, macération pelliculaire, stabulation de bourbes à froid).
• Consommation rapide de l’oxygène des moûts.
• Impact organoleptique (thiols et esters).
• Diminue l’acétate d’éthyle et l’AV .
Cela inhibe les micro-organismes aérobies et limite leur prolifération et la production de sous-composés défavorables.
disponibles
Frootzen
FrootZenTM diminue les quantités d’acétate d’éthyle & l’acidité volatile
FrootzenTM permet une consommation rapide de l’O2 des moûts : Après 2h de fermentation, plus de détection d’oxygène dissous dans le moût donc des conditions d’anaérobie.
Ci-dessous la consommation de l’oxygène de Frootzen seule comparée à une S.cerevisiae et un co-ensemencement Frootzen + S.cerevisiae. Cela inhibe les micro-organismes aérobies et limite leur prolifération et la production de sous composés défavorables.
cerevisiae
cerevisiae + Frootzen
FrootZenTM augmente la conversion des thiols (exemple : 3 MHA (fuit de la passion) et Sauvignon Blanc)
Augmentation du niveau de thiols lors de fermentation sur Sauvignon blanc où FrootZen a été ensemencé (T° fermentation 14°C)
0 20 40 60 80 100 120 140 160 180 0 20 40 60 80 100 120 140 160 180 200
S.
S.
µmol -1L
S. cerevisiae S. cerevisiae + Frootzen 87 88 89 90 91 92 93 94 95 96 97 98 mg/L S. cerevisiae S. cerevisiae + Frootzen 0 100 200 300 400 500 600 700 800 900 1000 3MHA mg/L 100%+
Dose pour 50hL réf. 183330 Dose pour 100hL réf. 140817 Conditionnements
| 37 LES LEVURES NONSACCHAROMYCES
MOÛTS
LES LEVURES
SACCHAROMYCES

VINIFLORA FROOTZENTM
FrootZenTM augmente la production d’esters d’acides gras à chaine moyenne ce qui augmente la longévité des arômes du vin
Un moyen naturel d’augmenter et de conserver le fruité des vins dans le temps.
S. cerevisiae
S. cerevisiae + Frootzen
C’est une levure peu consommatrice de nutriments, quelle que soit la souche de levure S. cerevisiae utilisée il n’y aura pas d’effet de compétition.
FrootZenTM consomme peu d’azote Bonne synergie avec S.cerevisiae
S. cerevisiae 1
Frootzen S. cerevisiae 2
S. cerevisiae 1 + Frootzen
S. cerevisiae 2 + Frootzen
Témoin non ensemencé
VINIFLORA FROOTZENTM POUR LA PROTECTION CONTRE L’OXYDATION
La capacité de Frootzen a consommer rapidement l’oxygène du moût en fait une alternative à l’utilisation de produits antioxydants traditionnellement utilisés en vendange (transport, réception et encuvage) tels que le métabisulfite de potassium, la neige carbonique ou encore le SO2. Dans le cadre d’une vinification sans SO2, FrootZen permet de maintenir la qualité sans sulfite :
• Évite l’oxydation des raisins ou du moût et inhibe la croissance des premiers contaminants • Active la croissance de Saccharomyces au bon moment • Protège les raisins durant le transport sur de longues distances
FrootZen™ est destinée à l’inoculation directe (DVS®), elle peut être répandue sur le raisin (voir Biospray) ou dans le moût.

Décongélation et Transfert
Sans décongélation
Utilisation du “glaçon” en cuve (vitesse de décongélation selon température du moût).
Ethy octanote Ethy decanoate Ethy dodecanoate 0 1 2 3 4 5 6 g/L 50%+ X 11 X 5 Ethyl octanote : Ananas, poire Ethyl decanoate : Abricot Ethyl dodecanoate : Floral jours Azote en mg/l début 2 4 6 8 10 12 14 16 18 0 50 100 150 200 250 300
38 | BIOPROTECTION ET TRAITEMENT DES
NON-
FrootZen™ produit plus de vins cristallins avec une couleur plus claire et évite les brunissements.
Couleur plus claire
Moins vive
Couleur plus beige


L-value (0=darkest, 100=lightest)
C-value (0=least intence, 100=most intense)
Control FrootZen
H-value (color shade in chromatic circle)
Analyse spectrophotométrique d’un rosé sans SO2 traité avec FrootZen comparé à une autre levure non-Saccharomyces de pré-fermentation. Rosé après débourbage. Celui de droite est traité avec FrootZen, celui de gauche avec une autre levure de pré-fermentation. La protection oxydante est visible physiquement sur les moûts, FrootZen peut former un voile protecteur faisant barrière entre le ciel gazeux et le jus comme il peut être vu ci-contre.
STABULATION DES MOÛTS À FROID ROSÉ VINIFLORA FROOTZENTM
La stabulation des bourbes à froid est un procédé très utilisé lors de la vinfication en rosé. Par un maintien au froid des bourbes sur plusieurs jours à basses températures les vins obtenus par la suite sont plus gras, plus aromatiques.
Cette étape même à basse température est à risques au niveau microbiologique. En effet il a été démontré ci-dessous que des contaminants ont la capacité de se développer pendant ce procédé.
L’utilisation de ferments bioprotecteurs permet d’éviter cette croissance avant la fermentation alcoolique. Ci-dessous les souches NOVA(bactéries) ou FROOTZEN (Non-Saccharomyces) ont la capacité de se développer dans ces conditions à basses températures et dès les premiers jours d’avoir un niveau de populations très élevé permettant de diminuer les populations de microorganismes d’altérations.




0 20 30 40 50 60 70 80 90 100 10
Jour 0 (jus avec pellicules) Jour + 5 (jus avec pellicules) Jour + 12 (jus avec pellicules)
| 39 LES LEVURES NONSACCHAROMYCES
ET TRAITEMENT DES MOÛTS
LES LEVURES NONSACCHAROMYCES
Souche pure de Lanchancea thermotolerans, cette levure de pré fermentation est très adaptée aux pressions osmotiques élevées du début de process. Sa spécificité : elle convertit une partie des sucres en acide lactique. On peut ainsi obtenir 0.5 à 0.8g/l d’acide lactique, ce qui correspond à une baisse de 0.1 unité pH et à un effet sensoriel très significatif.
de 500g réf. 164399T5
Kg
16439905
Fraîcheur avec Viniflora CONCERTO™

Exemple : augmentation de l’acidité totale et diminution du pH avec Viniflora® ConcertoTM. Une acidité précoce plus élevée assure une protection contre les flores indésirables.
Acide lactique
0,10 0,20 0,30 0,40 0,50 0,60
g/L
Acide lactique pH 3,6 pH 3,7 0,0 1 2 3 4 5 6 7 8
0,0
g/L Initial must Final wine
S. cerevisiae S. cerevisiae + Concerto
Fermentation (jours)
Concerto est à associer avec une levure S. cerevisiae pour assurer la fin de fermentation alcoolique en inoculation séquentielle. Le métabolisme de production d’acide lactique peut être modulé en jouant sur le timing d’inoculation de la S. cerevisiae
de l’effet
la
Les +
Acidification naturelle sans intrant des vins ;
Réduction possible du TAV naturelle ;
Bioprotection du moût (effet Jameson), diminution du pH limite la croissance de certains micro-organismes ;
Utilisable sur tout type de vin (blanc, rosé, rouge) ;
Amélioration du profil organoleptique des vins.

Sachet
5
réf.
Conditionnement(s) VINIFLORA CONCERTOTM Impact de Viniflora CONCERTO™ selon la durée de pré-fermentation Ensemencement de Concerto Inoculation de Saccharomyces Inoculation de Saccharomyces Inoculation de Saccharomyces TO 24h 48h Intensité
CONCERTOTM selon
durée de pré-fermentation 72h ++ +++ ++++
•
•
•
•
•
Populations Pré-fermentation Lachancea thermotolerans Saccharomyces cerevisae Fermentation alcoolique
0,2 0,4 0,6 0,8 1,0 1,2 1,4 1,6
40 | BIOPROTECTION
Les populations en Hanseniaspora uvarum (ou Kloeckera apiculata) sont supérieures sur le vin témoin = production possible d’acétate d’éthyle.
Les populations en bactéries acétiques sont plus élevées dans le vin témoin (possibilité d’une AV plus élevée)
UNE LEVURE POLYVALENTE POUR TOUT TYPE DE VIN

• Bioprotection par acidification du milieu


• Fraîcheur aromatique
• Production d’esters
•
• Amélioration de l’équilibre acide (moins d’agressivité)
• Intensification des notes de fruits rouges
• Spécificité vins moelleux : meilleur équilibre de la sucrosité et de l’acidité
• Amélioration de l’équilibre acide (moins d’agressivité)
• Réduction de la sécheresse en bouche finale
Un vin rosé fruité, sans sulfite
Produire un vin rosé sans sulfite est très technique et nécessite l’emploi de levures et bactéries spécifiques pour éviter le développement de micro-organismes d’altération.
Pour ce process, de nombreux clients des Côtes du Rhône utilisent, depuis 2016, la levure Lachancea thermotolerans Viniflora CONCERTO™. Elle est adaptée au moût et se développe durant la première phase de la fermentation alcoolique, jusqu’à ce que 10% vol. d’éthanol soient produits.
Puis ils ensemencent, en séquentiel 48h après, la levure SafŒno BCS 103 ou SafŒno HD
A54 pour achever la FA : elles ne produisent pas de SO2 et sont résistantes à l’alcool.
CONCERTO™ produit différents arômes de fruits et des acides organiques comme l’acide lactique, apportant rondeur et équilibre au vin.
Vinaflora® CONCERTOTM réduit les populations de levures de contamination
Vinaflora® CONCERTOTM réduit les populations de bactéries de contamination
« La FML sur blanc et rosé réalisée avec la bactérie CiNE permet de stabiliser microbiologiquement le vin et de conserver le profil fruité.»
Sandrine Berty, Œnologue-commerciale Rosé et Responsable Qualité Vinextase® Oenologie
Bactéries dans le moût en fermentation
S. Cerevisiae
S. Cerevisiae
ConcertoTM + S. Cerevisiae
ConcertoTM + S. Cerevisiae
| 41 LES LEVURES NONSACCHAROMYCES
• Réduction des notes de fruits cuits compotés (notes amyliques…)
Augmentation des notes de fruits frais
ROUGE TRADITIONNEL
ROSÉ
BLANCROUGE THERMOVINIFIÉ
LES
Dosage et application

25g/hl avec
CHR. HANSEN : L’ENTREPRISE LA PLUS DURABLE AU MONDE POUR 2019
Qu’avons nous gagné?
Chr. Hansen a été classée comme la société la plus durable au monde, une réalisation annoncée le 22 janvier 2019 lors du Forum économique mondial de Davos, en Suisse.
Pourquoi #1?
Nous avons été classés n ° 1 parce que nos produits présentent des avantages environnementaux et sociaux évidents, et nous sommes en mesure de certifier que 82% de nos revenus ont un impact sur les objectifs mondiaux de l’ONU.


Qui a décidé?
Corporate Knights est une société spécialisée dans les recherches sur les médias et les investissements basée à Toronto. Elle comprend une division de recherche qui produit des classements et des évaluations de produits financiers en fonction du rendement de la durabilité des entreprises. Corporate Knights, l’un des plus grands magazines au monde axé sur le carrefour des affaires et de la société, est la marque la plus en vue dans l’espace médiatique propre au capitalisme.
Merlot 2013 issu de thermoflash pasteurisation. Données In Senso Veritas panels de dégustateurs. différence significative à un niveau de confiance de 99% différence significative à un niveau de confiance de 95%

mg/l Acétate d’éthyle Acétate d’isoamyl Alcool d’isoamlyl Merlot control 42 4,13 222 Merlot concerto 39 3,15 286
réhydratation à 25°C sur eau non-chlorée suivie d’une activation et acclimatation similaire aux autres LSA. Viniflora CONCERTO™ est validé par ECOCERT pour une utilisation en bio. (Voir intrants validés sur site Ecocert) AGRICULTURE BIOLOGIQUE Utilisable en conformément au règlement CE 834/2007
ConcertoTMConcertoTM TémoinTémoin Acide Moelleux Brulant 2 1,5 0,5 1 Fruits confiturés Fruits rouges Intensité aromatique Sous bois Épicés 0 0,5 1 1,5 2 2,5 3 3,5 POUR LES VINS ISSUS DE THERMOVINIFICATION : UN NEZ PLUS NET AVEC PLUS DE COMPLEXITÉ 42 | BIOPROTECTION ET TRAITEMENT DES MOÛTS
LEVURES NONSACCHAROMYCES
VINIFLORA PRELUDETM
PRELUDETM est une souche de Torulaspora delbrueckii Cette levure de pré fermentation est très adaptée aux pressions osmotiques élevées du début de process. Sa spécificité : cryophilie. Cette souche est bien adaptée aux macérations préfermentaires à froid. PRELUDETM est à associer avec une levure S. cerevisiae pour assurer la fin de fermentation alcoolique lors d’une inoculation séquentielle.
Applications et doses
25g/hl avec réhydratation à 25°C avec de l’eau non chlorée suivie d’une activation et acclimatation similaire aux autres LSA. PRELUDE™ est validés par ECOCERT pour une utilisation en bio.
Les +
• Produit peu de sous-produits défavorables tels que l’acétaldéhyde (noix, pommes mâchées, oxydation), l’acétoïne (beurre), l’acide acétique (vinaigre) ou encore l’acétate d’éthyle (dissolvant).
• Apporte gras et volume en bouche : libération importante de polysaccharides et mannoprotéines.
• Complexité aromatique en bouche : production d’esters, révélation terpénique (forte activité β-glucosidase).
• Facilite le départ en FML : apport d’azote organique pour les bactéries lors de son autolyse.
Conditionnement(s)
Sachet de 500g ref. 133805T5
AGRICULTURE BIOLOGIQUE Utilisable en
Fruit Fleur Epices Patisserie 12 10 8 6 4 2 0 Citron / Pamplemousse Pêche Abricot Ananas Mangue Fruits secs Fruits secs (abrcitot, raisin) Orange Violette Canelle Clou de girofle Grillé / Toasté Caramel Lait 12 10 8 6 4 2 0 Framboise Mûres FleursFruits Autre Cerise Citron Banane Pomme Pomme verte Rose Toasté Profils aromatiques développés par Viniflora PRELUDETM fruité+ fruité+ complexité+ complexité+ Résultats comparaison S. cerevisiae et PRELUDETM + S. cerevisiae Acide acétique g/l Glycerol g/l Esters mg/l Acides gras (C6,8,10,12) mg/l S. cerevisiæ (EC1118) 0,21 6,7 6,3 14,5 T. delbrueckii (PRELUDETM) + S. cerevisiæ (EC1118) 0,06 6,9 7,3 3,5 S. cerevisiaePRELUDETM + S. cerevisiae Capacité de Viniflora PRELUDETM à produire des polysaccharides et résistance au stress osmotique Assemblage Syrah/Marselan Control (S.c. MERIT) PRELUDE (96h avant S.c. MERIT) PRELUDE (48h avant S.c. MERIT) Polysaccharides (mg/L) 0 100 200 300 400 + de souplesse - d’astringence | 43 LES LEVURES NONSACCHAROMYCES
MOÛTS
LES LEVURES
SACCHAROMYCES
La MPF est une technique naturelle et efficace d’extraction aqueuse de certains composés aromatiques du raisin à température très basse, trop basse pour un enclenchement de la fermentation alcoolique (FA).
Cette pratique est particulièrement efficace pour extraire des anthocyanes, pour l’extraction sélective de tanins de qualité ainsi que pour l’augmentation de l´intensité aromatique fruité et/ou florale du vin. Cependant, des activités microbiologiques indésirables peuvent être observées pendant la MPF.

Durant la macération initiale, la production d’acide acétique et d’acétate d’éthyle par des micro-organismes de contaminations tels que Kloeckera apiculata doit être contrôlée. Brettanomyces est aussi concernée puisque sa croissance durant la MPF peut causer de graves dommages plus tard, lors de la fermentation alcoolique ou de l´élevage des vins.
Pour prévenir la croissance des flores d´altération il est recommandé de conserver le moût entre 4 et 10°C. Pour assurer un haut niveau de bioprotection du moût, PRELUDE™ utilisée à 25g/hL est la levure de spécialité idéale pour plusieurs raisons :
• une concentration élevée de Torulaspora delbrueckii inhibe la croissance des micro-organismes indésirables par compétition,
> PRELUDE™ a un excellent potentiel de survie à très basse température,

> PRELUDE™ produit très peu d’acide acétique dans des conditions élevées en sucres
> PRELUDE™ a une cinétique de fermentation lente. Ce dernier point est particulièrement important, et différencie PRELUDE™ des levures Saccharomyces classiquement utilisées en MPF.
Lorsque le raisin se réchauffe après la MPF, si le vin contient des populations élevées en Saccharomyces présentes spontanément ou ensemencées sous forme de LSA, leur croissance en milieu favorable sera extrêmement rapide, il en résultera une FA très rapide. En contraste la cinétique de PRELUDE™ est beaucoup plus modérée, le départ en FA se fera beaucoup plus progressivement.
Saccharomyces pourra ensuite être inoculée après que le moût ait été réchauffé et après une chute de densité de 15 à 25 points (au choix du vinificateur) : ce procédé est appelé ‘inoculation séquentielle’ et vise à mimer la succession de populations levuriennes observées lors des fermentations alcooliques spontanées et réussies.
Vendange-SO2 total<30 mg/l ; Température (T) : 4°C - 10°C (enzymage classique, si pratiqué).
Ensemencer avec PRELUDE™ (pure Torulaspora delbrueckii) à 25 g/hL Maintenir T entre 4-10°C pendant 4-7 jours (Acclimater la préparation de levure aux basses températures avant inoculation).
Augmenter la température 20-25°C pour initialiser la fermentation primaire.
Après 15 à 25 points de chute de densité (24-36 heures), inoculer avec une souche Saccharomyces cerevisiae de votre choix en respectant la réhydratation et les apports azotés spécifiques précisés par le fabricant.
VINIFLORA PRELUDETM : POUR MACÉRATION PRÉFERMENTAIRE À FROID (MPF)
44 | BIOPROTECTION ET TRAITEMENT DES
NON-
VINIFLORA PRELUDETM : UNE SOLUTION POUR LES RAISINS RÉCOLTÉS EN SOUS-MATURITÉ
PRELUDETM est une solution pour faire face à la vinification de raisins récoltés en sous-maturité, présentant des caractères végétaux (pyrazines, etc) pouvant être exacerbés, et des tanins durs renforçant l’astringence et l’amertume en bouche préjudiciables à la recherche d’un vin de qualité. PRELUDETM permet ainsi de gommer ces défauts.
PRELUDE
SpontanéeSaccharomyces JAZZ
NOTES DE DÉGUSTATION
Cuve PRELUDE : Fruits noirs (par ex. prunes)
Cuve Saccharomyces JAZZ : Fruits noirs (par ex. épices)
Cuve spontanées : Dur et alcooleux
research
of
Saint-Emilion Merlot 2014
Les valeurs dans le graphique sont données en odor activity value (OAV) - concentration/seuil
Arômes végétaux
- Composés aromatiques associés au végétal dans un vin mesurés par GC-MS
- La modalité PRELUDETM obtient le plus petit score
2-isopropyl-3 -methoxypyrazine2-isobutyl-3-methaxypyrazine
Arômes végétaux
- La modalité PRELUDETM produit le moins de composés herbacés
0 Hexanal EucalyptolTrans-2-nonenal
2 4 6 8 10 12 14 16 PRELUDETM Control PRELUDETM Control Trans-2-hexenal Hexanol 0 200 400 600 800 1000 1200 1400 | 45 LES LEVURES NONSACCHAROMYCES
:
Banane Isoamyl acétate Fruit Ethyl hexanoate Fruit Ethyl isovalerate Smoke Guaiacol Clou de girofle 4-vinylguiacol Floral ß-phenylethanol Pomme de terre Metionel Fraise Ethyl butyrate Fraise Ethyl isobutyrate 0,0 2,0 4,0 6,0 8,0 10,0 12,0 14,0 Determining wine aroma from compositional data, Francis I.L. & Newton J.L., Australian Journal
grape and wine
11, 2005
MelodyTM est un mélange unique de souches Saccharomyces cerevisiae, Lachancea thermotolerans et de Torulaspora delbrueckii dans une proportion de 60:20:20.
Les +
• Assure la réalisation d’une fermentation alcoolique sûre et fiable à la fois dans les rouges, les blancs et les rosés.
• Révélation aromatique et gras en bouche.
• Ce mélange est l’un des meilleurs au monde pour produire des Chardonnay complexes avec un potentiel de garde important.
Conditionnement(s)Applications et doses 25 g/hl
Sachet de 500 g réf. 130907T5

Les préconisations de Vinextase® Œnologie : Une solution simple pour démarrer la bioprotection avec un seul ensemencement.
N’hésitez pas à consulter votre interlocuteur Vinextase® Oenologie ou votre œnologue conseil pour davantage d’informations.
Sur Chardonnay : impact sur le profil aromatique Notes de fruits

MELODYTM 8 7 6 5 4 3 2 1 0 bg cassis citron ananas mangue banane pomme poire coing peche abricot pruneaux kirsch figue raisin sec
Chardonnay MelodyTM Chardonnay témoin
46 | BIOPROTECTION ET TRAITEMENT DES MOÛTS LES LEVURES NONSACCHAROMYCES
Les bactéries lactiques
VINIFLORA NOVATM
NOVATM est une bactérie de type Lactobacillus plantarum, homofermentaire, elle dégrade uniquement l’acide malique du moût :
aucun risque de piqûre lactique (NOVA = NO Volatil Acidity) contrairement à Oenococcus oeni
sa sensibilité au SO2 et à l’alcool oblige le vinificateur à ensemencer avant l’ajout de LSA pour la fermentation alcoolique et vinifier sans SO2
inoculation inversée. L’ajout de LSA est recommandé lorsque la moitié de l’acide malique du moût est consommée.
Applications et doses
Conditionnement(s)
Les +
• Bioprotection du moût contre des bactéries indésirables par compétition.
• Bioprotection du moût sur le long terme contre des contaminations en bactéries acétiques.
• Production de composés aromatiques.
• Gain de temps pour la fermentation malolactique.

• Stabilisation plus rapide du vin.
VINIFLORA NOVATM : LA BIOPROTECTION PAR DES BACTÉRIES LACTIQUES

Une bioprotection bactérienne précoce est possible, si elles sont de l’espèce Lactobacillus plantarum, bactéries homofermentaires. Pour une bioprotection plus tardive et une maîtrise de la FML l’espèce Oenoccocus oeni, bactérie hétérofermentaire, permet de réduire les contaminations entre FA et FML.
CHR Hansen produit 5 souches adaptées à toutes les vinifications.
Dans les essais réalisés sur NoVA, il apparait un effet bioprotecteur antagoniste aux bactéries acétiques que l’on suppose par production de composés.
Viniflora® NoVA™ (Lactobacillus plantarum) permet d’inhiber les bactéries acétiques responsables de l’acidité volatile lors de la fermentation et l’élevage du vin.
•
•
•
Dose pour 50hl à ensemencement direct. Produit conservé à -45°C Conditions d’ensemencement à respecter Température TAV Ph min. SO2 total max. 20-30°C <5% <3,5 15mg/L Viniflora Frozen Nova 50Hl réf. 178133
AGRICULTURE BIOLOGIQUE Utilisable en
| 47 BACTÉRIES LACTIQUES
ET TRAITEMENT DES MOÛTS
BACTÉRIES LACTIQUES



Le graphe ci-dessous montre le développement des bactéries acétique sur Syrah jusqu’au pressurage (en jaune) lors d’une fermentation alcoolique spontanée, vinification sans sulfite.
Sur le même moût de Syrah la cartographie est totalement différente si l’on utilise Viniflora® NoVA™ dès la récolte du raisin. Son implantation se visualise par les rectangles bleus. La croissance des bactéries acétiques est totalement inhibée.

Absorbance relative (flore bactérienne) par métagénomique. Témoin FA spontanée Syrah

Absorbance relative (flore bactérienne) par métagénomique. Syrah ensemencée avec NoVA™ à l’éraflage
Sur un autre essai il est possible de voir qu’avec un ajout de NOVATM il n’y a pas de contamination par des micro-organismes indésirables à long terme sur un vin en élevage.

AVEZ-VOUS PENSÉ À…
SPRAYPROTECT

Vinextase® Matériel de Cave innove avec le développement d’un appareil d’application des micro-organismes de traitement du moût. Avec une buse et un débit adapté pour la diffusion homogène de la solution bioprotectrice, l’appareil peut être placé tout au long de votre réception (conquet, tapis, trémie de pompe, table de tri).
193109
Sans L. plantarum
Sans L. plantarum
Avec L. plantarum
Avec L. plantarum
réf.
La bioprotection visible par analyse métagénomiques
La bioprotection visible par analyse microbiologique
48 | BIOPROTECTION
FERMENTATION ALCOOLIQUE
| 49 Vinextase® Oenologie fort de son partenariat avec Fermentis, filiale du groupe Lesaffre leader mondial de la production de levures et dérivés de levures, propose des solutions innovantes pour gérer sa fermentation alcoolique. La bonne gestion de la fermentation passe par : - des souches de levures répondant aux besoins du vinificateur ; - des nutriments assurant une bonne fermentation sans défauts organoleptiques ; - des produits fonctionnels issus de la levure préservant ou exhaussant les caractéristiques intrinsèques du vin. 04 | Les nutriments 53 | Activateurs simples minéraux 54 | Activateurs complexes riches en levures inertées 56 | Autolysats de levures 100% organiques 58 | Ecorces de levures détoxifiantes 59 | Dérivés de levures pour optimiser la FA 04 | Les levures Saccharomyces sp. 65 | Aide au choix à la levure 66 | Gamme SafOEnoTM 76 | Gamme SafSpiritTM 77 | Gamme Vinextase®
AMONT DE LA VINIFICATION
FERM. ALCOOL.
BIO-PROTECT. DES MOÛTS
ENZYMES
PRODUITS SULFUREUX
PROTECTION CORRECTION VENDANGES
TANINS & DÉRIVÉS DU BOIS
PRODUITS DE COLLAGE
FERM. MALO. CORRECT. ET STAB. DES VINS FILTRATION DES VINS HYGIÈNE
Les nutriments pour la fermentation alcoolique
La fermentation alcoolique est la première étape biologique de la vinification. Saccharomyces cerevisiae est l’espèce de levure majoritaire responsable de ce procédé biochimique.

MICRO ET MACRO NUTRIMENTS DU MOÛT – EFFETS ASSOCIÉS
Types Catégories Nature Effets
Carbone Glu/Fru, Sucrose
Source d’énergie (glycolyse)
Azote Acides aminés, ammonium, nucléotides, peptides Synthèse des protéines : production de biomasse, cinétique-temps-arômes de fermentation
Macronutriments (renouvellement du matériel cellulaire)
Phosphate*/ soufre Composé P/S organiques et inorganiques
Facteur de survie Oxygène Acides gras Stérols (ergostérol)
Croissance cellulaire (biomasse), cinétique de fermentation
Arômes soufrés volatils
Croissance cellulaire : énergie, cinétique de fermentation Maintien d’un taux de glycogène et thréalose élevé (facteurs protecteurs de stress)
Stimule la biosynthèse des lipides, renforce la membrane plasmique (intégrité, perméabilité), viabilité
Diminue la production d’acides gras moyenne chaîne toxique
Micronutriments (catalyseur de réactions biochimiques)
Vitamines* Plus importantes : biotine, thiamine, pantothénate
Minéraux* Plus importants : Mg, K, Mn, Zn, Fe, Cu
Facteurs de croissance, co-facteurs dans les conversions enzymatiques
Co-facteurs de la glycolyse et d’autres réactions enzymatiques
* Généralement suffisant dans les moûts.
50 | FERMENTATION ALCOOLIQUE NUTRIMENTS
AZOTE ET FERMENTATION ALCOOLIQUE
Sa teneur dans le raisin, généralement comprise entre 0,1 et 1g/L, est fortement reliée au terroir (cépages, porte-greffes, sols, mode de conduite, travail du sol et fertilisation). Le climat, la date de vendanges sont des facteurs extérieurs qui peuvent influencer sa concentration. Il peut se retrouver sous différentes formes : minérale (sel d’ammonium NH4+) ou organique (acides aminés, peptides et protéines).
L’azote présent dans le moût est un élément indispensable au métabolisme des levures réalisant la fermentation alcoolique (Saccharomyces sp. et non-Saccharomyces sp.).
Les sources d’azotes disponibles dans les moûts pour les levures sont l’ion ammonium (NH4+), les acides aminés (sauf la proline) et les petits peptides pour synthétiser leurs protéines. Ces composés constituent l’azote assimilable ou Yeast Assimilable Nitrogen (YAN), ce taux est mesurable par IRTF ou méthode enzymatique.
Le moût de raisin est généralement dit carencé en azote pour un YAN inférieur à 140 mg/L. Cette teneur peut néanmoins varier selon le degré d’alcool
Nutrition azotée de la levure
2. Changements métaboliques importants Ajout de l’O2 Viabilité
max
potentiel la température, l’oxygène, la turbidité du moût et les besoins nutritifs de la levure obligeant alors au vinificateur à apporter de l’azote pour le bon déroulement de la fermentation alcoolique. Ces apports (1 ou 2) peuvent être répartis au cours de la fermentation alcoolique.
3,35 g/l de CO2 : meilleur moment d’ajout d’Nass - Peu ou pas de recroissance cellulaire - Augmentation de l’activité fermentaire - Efficacité constante
Activité fermentaire
Densité Vitesse de fermentation Population levurienne Cumul de CO2

Inhibition de l’éthanol
1. Inoculation de la levure : milieu complet pour une bonne croissance
- en début de fermentation un apport d’azote surtout minéral, facilement assimilable par la levure, permettra un excellent départ en fermentation en favorisant la multiplication cellulaire.
- au tiers de la fermentation alcoolique l’apport d’azote favorisera le métabolisme de consommation des sucres. Une origine organique sera consommée de façon plus
Mortalité
Viabilité
Temps
lente et régulière, ce qui donnera une meilleure viabilité en fin de FA.
Ces apports sont nécessaires en cas de carence afin d’éviter un arrêt de fermentation alcoolique qui peut être préjudiciable pour la qualité du vin et favoriser la contamination par des micro-organismes indésirables.
V
Latence
Phase stationnaire = survie des levures Phase exponentielle de croissance
| 51 NUTRIMENTS
AZOTE ET IMPACT ORGANOLEPTIQUE
L’azote peut avoir un impact direct négatif ou positif sur le profil aromatique des vins, étant à l’origine des molécules synthétisées par le métabolisme levurien (alcools supérieurs, esters).
Son absence peut conduire à la production de notes de réduction, par exemple la production de H2S (œufs pourris) par les levures.
L’azote minéral, en excès peut avoir un effet négatif sur l’expression des thiols en vinification. La levure choisira de façon préférentielle l’ion ammonium très rapide à assimiler et bloquera le transport au travers de sa membrane des précurseurs de thiols (liés à des acides aminés source plus lente d’azote). Ce qui conduira à une diminution de leur révélation au cours de la FA. C’est une répression catabolique.
Les formulations en azote organique favorisent une fermentation plus harmonieuse et régulière et augmente l’expression aromatique : production d’esters ou réduction de certaines dyméthylsulfure (moins de dégradation).
Les préconisations de Vinextase® Œnologie :
La recherche constante d’une meilleure qualité des vins peut engendrer des sources de stress importantes pour les levures, telles que des carences nutritionnelles et des concentrations élevées en alcool et en polyphénols.

Ces conditions défavorables peuvent être à l’origine de la formation de composés indésirables ou d’arrêts de fermentation avec pour conséquence des profils aromatiques moins nets et de possibles contaminations microbiologiques des vins. La nutrition des levures sousentend un apport exogène de différents éléments dont l’azote, qui peut prendre différentes formes selon son origine.
Vinextase® Oenologie vous propose une gamme complète d’activateurs consacrés aux différents moûts et aux différentes fermentations : - inorganiques ; - organiques ; - complexes.

Les activateurs et produits fonctionnels de notre partenaire Fermentis vous apportent des solutions performantes pour : - améliorer/sécuriser le processus fermentaire - caractériser et stabiliser vos vins dans le temps - donner du caractère à vos vins et révéler leurs profils aromatiques spécifiques
La gamme Fermentis est élaborée exclusivement à partir de produits de levure, en conformité avec le codex œnologique OIV afin de répondre aux exigences des pratiques œnologiques modernes.
52 | FERMENTATION ALCOOLIQUE NUTRIMENTS
Activateurs simples minéraux
VIT’AZOTE
Activateur minéral de la fermentation alcoolique à base de sulfate d’ammonium et de thiamine.
Les +
• En remplacement du sulfate, dans le cas d’un raisin altéré qui peut être carencé en vitamine B1.
• Permet d’augmenter la biomasse des levures et la vitesse de fermentation.
Applications et doses
Moût : 20 à 50 g/hl selon carence
Apport à d-30 : fractionner les apports en cas de forte carence (<140mg/l N ass)
Dose max légale : 60g/hl
VIT’AZOTE P
Activateur minéral de la fermentation alcoolique à base de phosphate d’ammonium et de thiamine.
• L’ajout de thiamine pendant la FA permet de diminuer le taux de combinaison du SO2
Conditionnement(s)
1 kg réf. 13748101 25 kg réf. 13748125
PHOSPHATE D’AMMONIUM
Activateur minéral de la fermentation alcoolique.
Les +
• Augmente la biomasse levurienne.
• Très riche en N ass : 20 g/hl de DAP apporte 42 mg / litre d’ N ass.
Applications et doses
Moût : 20 à 50 g/hl selon carence
Apport à d-30 : fractionner les apports en cas de forte carence (<140mg/l N ass)
Dose max légale : 100 g/hl
Conditionnement(s)
1 kg réf. 13733201
25 kg réf. 13733225
Applications et doses
Moût : 20 à 50 g/hl selon carence Apport à d-30 : fractionner les apports en cas de forte carence (<140mg/l N ass)
Dose max légale : 60g/hl
Les +
• En remplacement du DAP, dans le cas d’un raisin altéré qui peut être carencé en vitamine B1.
• Permet d’augmenter la biomasse des levures et la vitesse de fermentation .

• L’ajout de thiamine pendant la FA permet de diminuer le taux de combinaison du SO2
Conditionnement(s)
1 kg réf. 17376501 25 kg réf. 17376525
SULFATE D’AMMONIUM
Activateur minéral de la fermentation alcoolique.
Attention:pourcertaineslevures, l’ajoutdesulfated’ammoniumpeut entraîneruneaugmentationdela concentrationfinaleensulfite.
Applications et doses
Moût : 20 à 50 g/hl selon carence
Apport à d-30 : fractionner les apports en cas de forte carence (<140mg/l N ass) Dose max légale : 100 g/hl
Les +
• Economique.
• Augmente la biomasse levurienne.
• Très riche en N ass : 20 g/hl de DAP apporte 42 mg / litre d’ N ass.
Conditionnement(s)
1 kg réf. 13732801 25 kg réf. 13732825
AGRICULTURE BIOLOGIQUE Utilisable en conformément au règlement CE 834/2007
AGRICULTURE BIOLOGIQUE Utilisable en conformément au règlement CE 834/2007 | 53 NUTRIMENTS
Activateurs complexes riches en levures inertées
NUTRIMAX
Activateur de la FA à base de sulfate d’ammonium, de levures inertées et de thiamine.
Applications et doses
En début de FA 20 g/hl apporte 30 mg / litre d’ N assimilable
Conditionnement(s)
1 kg réf. 16329401
25 kg réf. 13748225
NUTRIMAX ACTIV
Activateur complexe de fermentation alcoolique à base d’autolysats de levures, thiamine, phosphate diammonique et cellulose.
Les +
• Apport en une fois de 3 éléments complémentaires.
• Les levures inertées riches en protéines insolubles permettent de corriger les effets d’un débourbage trop poussé (<50 NTU) et adsorbent les résidus de pesticides, qui peuvent être, dans certains cas, un frein au bon déroulement de la fermentation et elles sont riches en vitamines et minéraux.
NUTRIMAX P
Activateur de la FA à base de phosphate d’ammonium, de levures inertées et de thiamine.

Applications et doses
Les +
• Apport en une fois de 3 éléments complémentaires.
Applications et doses
10g/hL apporte 10 mg/L d’azote
Les +
• Sa formulation granulée permet une utilisation simple avec un seul ajout d’azote (sous deux formes : minérale et organique) et sécuritaire (non pulvérulente) avec les mêmes bénéfices que nos autres produits Nutrimax.
Conditionnement(s)
5 kg réf. 18687905
Conditionnement(s)
• Les levures inertées riches en protéines insolubles permettent de corriger les effets d’un débourbage trop poussé (<50 NTU) et adsorbent les résidus de pesticides, qui peuvent être, dans certains cas, un frein au bon déroulement de la fermentation et elles sont riches en vitamines et minéraux.1 kg réf. 17376701 20 kg réf. 17376720
AGRICULTURE BIOLOGIQUE Utilisable en conformément au règlement CE 834/2007
En début de FA 20 g/hl apporte 30 mg / litre d’ N assimilable AGRICULTURE BIOLOGIQUE Utilisable en 20 g/hl (poudre) DAP Nutriment complexe Levures inertées Nutriments Organiques Autolysat partiel Nutriments Organiques Autolysat total Ecorces de levures Nom commercial VIT’AZOTE VIT’AZOTE P DAP NUTRIMAX NUTRIMAX P NUTRIMAX ACTIV + SPRINGFERM NUTRIMAX O VINILIQUID SPRINGFERM XTREM SPRINGCELL SPRINGCELL BIO YAN 42 mg/litre 30 mg/litre 10 mg/litre 18 mg/l à 20 mg/l 0 Azote minéral +++ ++ 0 0 0 Acides aminés 0 + ++ +++ 0 Vitamines 0 ++ +++ +++ 0 Minéraux 0 ++ ++ ++ 0 Stérols 0 + ++ ++ +++ Moment Apport Privilégier l’apport au 1/3 de la FA -Sur moût blancs et rosés en conditions difficiles : SPRINGFERM en début de FA - FA languissante - Arrêt de FA Impact Sensoriel H2S, AV ! Positif Très Positif Très Positif 0 54 | FERMENTATION ALCOOLIQUE NUTRIMENTS
Levure
Plasmolyse
Levure
Autolysat
Centrifugation
Ecorces
SpringcellTM
Centrifugation

Extrait Protéique
SpringfinerTM
Nutrition / Détoxification
active Gamme SafŒnoTM
de Levure
Stérols, polysaccharides Souches spécifiques Mannoprotéines Springcell MannoTM Acides aminés, peptides, vitamines Protéines, peptides, glutathion,… SpringaromTM SpringcellTM Color
inactivée SpringfermTM Autolysat de levure Springferm XtremTM ViniLiquidTM
total de levure
Procédé d’autolyse (pH, T) Fermentation Caractérisation
| 55 NUTRIMENTS
Les autolysats de levures 100% organiques
Bénéfice des levures autolysées
Riches en acides aminés essentiels pour la levure (Glutamine, Asparagine, Leucine, Lysine, Sérine…)
Adaptés aux moûts difficiles :
- très mûrs et carencés en azote (<150 mg/L) ;
- riches en sucres fermentescibles (alcool potentiel > 13 %) ;

- riches en polyphénols ;
- fermentations languissantes et arrêts de fermentation alcoolique ;


- nutriment pour les bactéries lactiques.
SPRINGFERM™
Autolysat
« partiel » de levures 100% organique
3 fois plus riches en azote assimilable que les levures inertées.
Les +
• Moût fortement débourbé en Blanc et Rosé : à apporter au levurage.
• Sa richesse en protéines insolubles fait effet support pour la levure et absorbe les résidus de pesticides.
• Naturellement plus riche vitamines, minéraux et stérols que les levures inertées.
SPRINGFERM™
XTREM
Autolysat
« total » de levures 100% organique.
Les +
• Produit le plus riche de notre gamme en N ass.
• Evite les notes réductives.
• Très riche en Acide Folique, Biotine, Pantothénate de Calcium et Niacine.
• La biotine favorise la production d’esters et une meilleure viabilité cellulaire pour la fermentation.
Applications et doses
20 g/hl apporte au minimum 10 mg / litre d’ N ass.
NUTRIMAX O
Autolysat
« total » de levures 100% organique.
Applications et doses
20 g/hl apporte 18 mg / litre d’ N assimilable
Entre le 1/3 et milieu de la FA 25 à 30g/hl en cas de FA languissante
Conditionnement(s)
1 kg réf. 14074701 10 kg réf. 14074710
Les +
• Evite les carences en acides aminés.
• Prévient la production de notes réductives type H2S et d’acidité volatile, par la levure.
Conditionnement(s)
20kg réf. 19119820
Applications et doses
20 g/hl apporte 20 mg / litre d’ N assimilable
Entre le 1/3 et milieu de la FA 25 à 30g/hl en cas de FA languissante
Conditionnement(s)
1 kg réf. 14074801
AGRICULTURE BIOLOGIQUE Utilisable en
AGRICULTURE
BIOLOGIQUE Utilisable en conformément au règlement CE 834/2007
AGRICULTURE
BIOLOGIQUE Utilisable en conformément au règlement CE 834/2007
56 | FERMENTATION ALCOOLIQUE NUTRIMENTS
VINILIQUID™
Autolysat « total » de levures 100% organique LIQUIDE originel, stabilisé avant l’étape de séchage.
Les +
• Utilisation directe dans le moût sans dissolution préalable.
• Dispersibilité totale dans le moût sans problème d’homogénéisation.
Applications et doses
1 Bidon
Conditionnement(s)
• Pompable et homogène, prêt à être injecté manuellement ou via des systèmes automatisés.

Elimine les risques d’inhalation associés à la manipulation de produits hautement pulvérulents.
La nutrition et la protection de la levure sont au cœur de la bonne gestion de la cinétique fermentaire.
La région Languedoc subit de forts changements pédo-climatologiques, qui ont un réel impact sur la composition des moûts (degrés élevés, carences azotées notamment). Les conditions sont de plus en plus contraignantes pour les levures.
« Dans le cas de fortes carences azotées, Springferm Xtrem limite le stress de la levure, formant alors des composés réducteurs. »
Cela oblige l’œnologue à appréhender de façon plus fine sa stratégie de nutrition de la levure. Au-delà des formulations simples d’azote minéral (sulfate d’ammonium, DAP), le Springferm Xtrem fait partie de nos préconisations. Il s’adapte bien à cette problématique. Dans le cas de fortes carences azotées, il limite le stress de la levure qui forme alors des composés réducteurs. En effet, l’azote minéral joue davantage sur la biomasse de la levure, sans régler complétement la carence azotée, mais en la déplaçant dans le temps.
Nous le conseillons aussi parfois, sur des cépages «thiolés» comme le Sauvignon, pour favoriser la formation de composés aromatiques variétaux. En effet, le seul ajout d’azote minéral n’est dans ce cas pas préconisé (phénomène de répression catabolique).
Laboratoire Natoli (34) - Sébastien Pardaillé, Œnologue, membre du Conseil Scientifique Vinextase®

•
6kg ref. 17342606 12 kg réf. 17342612 BB 210kg réf. 173426Z7
Utilisation directe dans le moût 50 ml/hl apporte 20 mg / litre d’azote assimilable Soit
de 12kg pour 200 hl Entre 1/3 et milieu de la FA En cas de FA languissante Formulation et pouvoir fermentaire Gain de performance / autolysat sec équivalent Sucres résiduels 25,5 18,0 2,5 0,5 Témoin O2 O2 + SpringFerm Durée de fermentation (h) 0 0 0,2 0,4 0,6 0,8 1 1,2 1,4 Débit de CO 2 (g/l/h) 50 100 150 200 250 300 350 - 42% - 31% - 10% 400 450 10mg/l O2 à Vmax 20ppm Nass et 13,4 g/hl d’écorce de levure O2 + ViniLiquid Poussière générée par la formulation poudre Absence de poussière Autolysat sec de levure ViniLiquid | 57 NUTRIMENTS
Ecorces de levures détoxifiantes
SPRINGELL™ ET SPRINCELL™ BIO

Ecorces de levures pures naturellement très riches en stérols.
Springcell : écorces de levures pures originelles (procédé breveté par la faculté d’œnologie de Bordeaux).
Agriculture
Biologique : vous êtes dans l’obligation d’utiliser la version BIO du SpringCell.
Applications et doses
- pour les moûts très clarifiés
- pour les moûts à forte teneur en résidus de produits phytosanitaires : 30g/hl après débourbage (avant le levurage) - 30g/hl si arrêt de FA, directement dans le vin au préalablement soutiré et sulfité Consultez notre protocole de reprise de FA.
Les +
• Action détoxifiante par adsorption :
- résidus des traitements phytosanitaires ;
- acide gras à moyenne chaine (inhibiteur de fermentation) ;
• Activateurs :
- richesse en stérols et facteurs de survie (forts degrés alcooliques) ;
- effet support de fermentation en cas de débourbage trop prononcée (substitut des bourbes).

Conditionnement(s)
500 g réf. 140749T5
10 kg réf. 14074910 Bio 500 g réf. 184312T5
de produit
pouvoir détoxifiant
Activité technologique
d’acide décanoïque adsorbé] par
99,10 98,70 50 80 70 60 100 90 110 Springcell BIO Springcell Même
[%
g
AGRICULTURE BIOLOGIQUE Utilisable en
58 | FERMENTATION ALCOOLIQUE NUTRIMENTS
Dérivés de levures pour optimiser la FA : caractériser les vins
Produits fonctionnels : mettre à profit le bénéfice des lies de façon maîtrisée
• Augmentation de la rondeur : addition (polysaccharides) et/ou soustraction (tanins astringents)
• Action clarifiante : soustraction des tanins instables mais aussi de particules insolubles (protéines instables)
• Stabilisation de la couleur : enrobage et combinaison avec les polyphénols (polysaccharides)
• Protection contre l’oxydation : addition (composé antioxydant comme le glutathion) et/ou soustraction (polyphénols oxydables)
SPRINGAROMTM
Levure inactivée à fort pouvoir réducteur, grâce à sa forte teneur en glutathion équivalent naturel (3%) : un tripeptide antioxydant présent dans la levure, qui prévient la formation de radicaux libres et évite ainsi le vieillissement organoleptique.
Intéressant en Blanc et Rosé, sur les cépages riches en précurseurs de thiols (Sauvignon, Cabernet Sauvignon, Merlot)
Applications et doses
g / hl avant inoculation des levures
Conditionnement(s)
kg réf.
Témoin
SpringArom
Levure inertée A sans glutathion
Levure inertée B sans glutathion
Les +
• Gain en fraîcheur, apport de gras en bouche et diminution de l’astringence.

• Préserve les arômes de type « thiols » des vins blancs et rosés et prévient contre le brunissement des moûts.

1
14075101
30
AGRICULTURE BIOLOGIQUE Utilisable en Grenache Rosé 2016 6 mois après fin FA JMH Consommation en mg/l 0 200 800 600 400 1000 1200
Champs d’utilisation du produit Action clarifiante Préservation des arômes Protection contre l’oxydation Stabilisation de la couleur Augmentation de la rondeur 0.56 0.54 0.52 0.5 0.48 10.00 0.58 0.6 0.62 25 20 15 10 5 30 35 45 1 Merlot Rosé 2011 5 mois après fin FA SpringAromSpringArom Rosé 2012 4 mois après fin FA TémoinTémoin Teinte jaune Teinte étalon Teinte rouge Effet sur les arômes sensibles à l’oxydation Effet sur la couleur | 59 NUTRIMENTS
SPRINGCELLTM COLOR G2
NOUVEAUTÉ
Les +
• Stabilise la couleur les complexes tanins-anthocyanes. En combinaison avec une extraction forte (addition d’enzymes, pigeages, remontages…).
• Augmente le potentiel de garde des vins rouges.

• Apport de rondeur et diminution de l’astringence.
• E2U™
Applications et doses 20 à 30 g/hl avant inoculation des levures
Conditionnement(s)
Levure inactivée spécifique issue de Saccharomyces cerevisiae. Particulièrement riche en polysaccharides, il impacte le profil polyphénolique des vins rouges pour une couleur à la fois plus stable et plus intense ainsi qu’une structure tannique plus souple. SpringCell™ Color G2 améliore le profil organoleptique des vins rouges et se révèle particulièrement intéressant pour des vins premiums destinés à la garde. 500 g réf. 195592T5
La formulation micro-granulée de SpringCell™ Color G2 permet une dissolution facilité et une plus grande sécurité d’utilisation.
SpringCell Color G2 poudre fine 1minute et 20 secondes Oui Non
SpringCell Color G2 poudre microgranulée 25 secondes Non Oui

Champs d’utilisation du produit
Protection contre l’oxydation
Action clarifiante
Préservation des arômes
Effet sur le profil phénolique
Stabilisation de la couleur
Augmentation de la rondeur
SPRINGCELLTM COLOR
Levure inactivée conçue pour agir durablement sur l’intensité et la stabilité de la couleur, ainsi que sur la rondeur des vins rouges. Elle contient 2 fois plus de polysaccharides qu’une simple levure inactivée.
Son impact qualitatif est largement démontré aussi bien sur les vins rouges à boire jeunes que sur les grands vins rouges de garde.
et
Temps de dispersibilité à 15°C
Pulvérulence E2U à 15°C
AGRICULTURE BIOLOGIQUE Utilisable en conformément au règlement CE 834/2007
Analyse en composantes principales Effet sur 3 millésimes de l’ajout de levure inactivé SpringCell Color G2 Intensité et stabilisation de la couleur Cabernet Sauvignon - 2012 Après 5 mois Malbec 2015 Après 5 mois Malbec 2013 Après 6,5 moisSensation en bouche 70 75 80 80 82 84 86 88 90 92 94 85 90 95 Springcell Color G2 Springcell Color
Effets moyens de l’ajout de levure inactivée SpringCell Color G2 après 6,5 mois d’élevage Stabilisation des polyphénols Augmentation de la concentration en polyphénols Gain efficacité G2Effet SpringCell Color DP Tanins PM moyen Tanins Indice de Polyphénols Totaux Intensité colorante -15% -10% -5% 0% 5% 10% 15% Tanins Anthocyanes libres Complexes T-A Indice DMACH
500 g réf. 140750T5 1 kg réf. 14075101 Conditionnement(s)Applications
doses 20 à 30 g/hl avant inoculation des levures AGRICULTURE BIOLOGIQUE Utilisable en 60 | FERMENTATION ALCOOLIQUE NUTRIMENTS
SPRINGCELL MANNOTM
Les +
Applications et doses
L’addition de SpringCell Manno est recommandée au début de la phase d’élevage.
Vins rouges : 20-40 g/hl
Vins blancs : 10-30 g/hl
Dissoudre SpringCell Manno dans un minimum d’eau.
Attention : ce produit n’est pas totalement soluble. L’usage des écorces de levure SpringCell Manno est limité à 40 g/hL par la législation européenne.

Conditionnement(s)
Produit constitué à 100% de polysaccharides levuriens (glucanes et mannoprotéines solubles) représentant la partie noble des lies. SpringCell MannoTM contient des mannoprotéines hautement solubles non liées aux ß-glucanes dont l’efficacité est immédiate dans le vin. 500 g réf. 140752T5
• Apport de rondeur et de volume - mannoprotéines hautement solubles non liées aux ß-glucanes dont l’efficacité est immédiate dans le vin. Ces polysaccharides agissent tout en finesse sur la sensation de volume et de gras apportée usuellement par l’élevage sur lies.
• Diminution de l’astringence - les polysaccharides se combinent avec les tanins les plus astringents pour atténuer la dureté et donner de la rondeur au vin.
• Stabilisation de la couleur des vins rouges - les polysaccharides de levure permettent une stabilisation durable des complexes tanins anthocyanes.

• Stabilisation des vins - plus grande richesse en colloïdes protecteurs (mannoprotéines). Aux concentrations présentes dans le vin, ces polysaccharides gênent la cristallisation des sels d’acide tartrique.
• Prévention des déviations organoleptiques - substitution aux lies fines, évitant ainsi la formation de notes réductrices générées par ces dernières (H2S) durant la période d’élevage. Cette substitution empêche également tout développement d’éventuels micro-organismes indésirables contenus dans les lies naturelles.
• Effet sur la mousse des effervescents - riche en polysaccharides partiellement solubles qui améliorent la tenue de mousse. Addition avant ou après FML sur vins de base.
AGRICULTURE
BIOLOGIQUE Utilisable en Champs d’utilisation du produit Protection contre l’oxydation Stabilisation de la couleur Augmentation de la rondeur Préservation des arômes Action clarifiante Effet de Springcell Manno après 5 mois d’élevage Effet sur la perception en bouche Alcool Indice d’éthanol Pouvoir tannant Intensité colorante Teinte Anthocyanes totales IPT Tanis TEST SPRINGCELL MANNO 120 100 80 60 40 100 98 96 94 92 90 88 Perception en bouche Intensité et stabilisation de la couleur 75 80 85 90 95 100 TEST Springcell Manno Springcell Manno 5MTEST 5M | 61 NUTRIMENTS
MÉNAGEZ VOTRE TEMPS, GAGNEZ EN CONFORT ET AGISSEZ POUR LA PLANÈTE
Les produits E2UTM de Fermentis facilitent la vie. C’est leur vocation première (ils sont « EASY 2 USE ») : plus faciles à manipuler, plus simples à utiliser, ils font gagner du temps. Une qualité qui séduit de nombreux producteurs, partout dans le monde. Mais les solutions E2UTM sont aussi vertueuses pour l’écologie, l’économie et la santé. C’est notre façon à nous d’innover dans le bon sens et de jouer notre rôle, humblement, dans le combat pour préserver notre planète.
AVANTAGE N°1
La fermentation devient plus simple La première caractéristique des levures sèches actives certifiées E2UTM, c’est qu’elles n’ont plus besoin d’être réhydratées. Vous pouvez les inoculer directement dans le moût, la qualité de votre fermentation ne variera pas. Nous avons fait des tests pendant un an sur chaque souche pour bien valider que, sans réhydratation, tous les attendus étaient au rendez-vous : la cinétique de fermentation, le profil aromatique, la teinte, le degré d’alcool souhaité…
Réhydrater ou pas n’est plus une question d’efficacité, c’est désormais une question de préférence. Certains vignerons se sont empressés de choisir l’inoculation directe afin de simplifier leur quotidien et de gagner du temps. D’autres, attachés à leurs habitudes, préfèrent encore passer par cette étape de réhydratation. Avec E2UTM, vous avez désormais le choix
AVANTAGE N°2
d’eau économisés par an.
de détergent non-utilisées.
d’émissions de CO2 en moins.
Zéro risque d’inhalation de produit.
Gain de temps 45 minutes en moyenne par préparation de starter.
Moins d’investissement en CAPEX Amélioration de la productivité
Réduction des riques de non conformité
On consomme moins d’eau et d’énergie. Si tous ceux qui utilisent de la levure sèche active (soit 75% des producteurs de vin) faisaient le choix de ne plus réhydrater, 600 000 hl d’eau pourraient être économisés chaque année. De quoi alimenter en eau une famille de 4 personnes pendant 162 ans aux Etats-Unis, 274 ans en France, et 548 ans en Amérique Latine. Ce choix entrainerait aussi des économies d’énergie puisqu’il ne serait plus nécessaire de chauffer l’eau de réhydratation, comme c’est habituellement le cas. Sur ce plan, l’adoption d’E2UTM reviendrait à consommer moins d’électricité ou de gaz et à éviter l’émission d’environ 240 tonnes de CO2 chaque année. Avec ce même souci de réduire la consommation d’énergie, Fermentis a fait du stockage de ses produits à température ambiante l’une de ses trois priorités pour les années à venir.
AVANTAGE N°3
On réduit la pollution. Chaque année, on utilise dix tonnes de détergent pur pour nettoyer le matériel nécessaire à la préparation des 2,15 millions de levains œnologiques. Or, les détergents restent longtemps actifs. Rejetés dans les égouts, ils peuvent finir par contaminer l’eau des nappes phréatiques et des rivières, ainsi que les végétaux et animaux aquatiques. Tout ce qui peut limiter leur usage est donc bon à prendre.
AVANTAGE N°4
On gagne en confort et en sécurité. Ces dernières années, et en partenariat avec plusieurs laboratoires, Fermentis a pris à bras le corps le problème de l’inhalation des levures lors de leur manipulation.
D’abord pour ses propres équipes, sur les sites de production, mais aussi, bien sûr, pour ses clients. Plusieurs solutions sont nées de ces recherches et de notre volonté de garantir une sécurité maximale aux femmes et aux hommes qui utilisent nos produits : des solutions microgranulées, comme l’agent de collage Spring’FinerTM, ou bien liquides, comme notre activateur de fermentation ViniLiquidTM. Nous avons également engagé un vaste travail de R&D pour tester la pulvérulence de nos dérivés de levures afin, là encore, d’en limiter les effets (inhalation et pertes de produit).
NOS SOLUTIONS E2U
LEVURES
• SafOEno™ HD S62 Pour les vins rouges colorés et charpentés
• SafOEno™ HD S135 Pour des vins rouges alliant concentration et souplesse
• SafOEno™ STG S101 Pour les vins rouges et rosés fruités
• SafOEno™ GV S107 Idéalement adaptée aux vins blancs premiums
• SafOEno™ CK S102 La souche idéale pour les vins blancs et rosés aromatiques
• SafOEno™ SC 22 LA levure starter
• SafOEno™ BC S103 Le choix idéal pour les fermentations extrêmes
• SafOEno™ NDA 21 Le choix idéal pour les vins rouges fruités et élégants
DÉRIVÉS DE LEVURES
• ViniLiquid™ L’unique activateur organique de fermentation sous forme liquide
• SpringCell™ Color G2 La nouvelle génération de SpringCell™ Color
• Spring’Finer™ Le 1er agent de collage d’origine levurienne
> 600 000 hectolitres
> 1 500 tonnes
> 240 tonnes
62 | FERMENTATION ALCOOLIQUE NUTRIMENTS
Les levures pour la fermentation alcoolique

Expert dans l’art de la fermentation, notre partenaire Fermentis collabore avec l’ensemble des acteurs du monde de la bière, du vin, des spiritueux et des autres boissons fermentées. Notre gamme de produits et de services couvre la majorité des besoins des professionnels : de la sécurisation de la production à l’expression des caractéristiques sensorielles.
S’appuyant sur le savoir-faire et les connaissances du groupe Lesaffre, un des premiers producteurs de levures au monde, Fermentis a mis au point un procédé spécifique de production et de séchage des levures permettant de les rendre résistantes à des conditions très diverses de mise en oeuvre tout en préservant leur efficacité fermentaire et leurs caractéristiques aromatiques.
Méthode de validation exemple BCS103 : SafŒno™ BC S103 testée dans 2 micro vinifications de type méditerranéennes combinant un TAP très élevé et un niveau d’azote assimilable (Nass) très faible sans ajout de nutriment pendant la FA.
• la 1re sur Clairette blanche vinifiée à 17°C avec un TAP de 15% v/v, 98ppm de Nass et avec une turbidité initiale de 5 NTU
• la 2e avec du Grenache noir vinifié à 20 28°C avec un TAP de 16% v/v et 120ppm de Nass.
 Densité trait plein ; Températures pointillés
Densité trait plein ; Températures pointillés
0 0980 1000 1020 1040 1080 1100 1120 1140 Densité (g/L) Jours BC S103 Habituel BC S103 Eau froide BC S103 Moût 5 10 15 20 25 30 5 10 15 20 25 30 35 1060 Température (°C) | 63 LEVURES
Test de viabilité
Conditions d’agitation : W = sans, M = modérée, V = violente
Protocole : la levure safŒnoTM BC S103 Easy 2 Use a été réhydratée dans une solution d’eau distillée à 10% de saccharose pendant 45 min., dans des conditions variées de température et d’agitation. Résultats : pas de variation significative de la viabilité de la levure.
Profil aromatique
Dégustations triangulaires

Protocole : tests triangulaires professionnels. Vin de Clairette dégusté après soutirage et sulfitage sans FML.

Vin de grenache soutiré et sulfité après FA-FML.
Résultats : l’inoculation directe de la levure safŒnoTM BC S103 Easy 2 Use n’a pas d’impact significatif sur le profil organoleptique global du vin comparé à la réhydratation classique. Cela valide donc l’alternative permettant un gain de temps important. La réhydratation à froid a montré de faibles différences par rapport aux autres modalités pour le vin blanc.
L’ensemencement direct : une tranquilité d’esprit, tant sur le contrôle des départs de fermentation que dans la mise en œuvre, pour un gain de temps non négligeable !
J’utilise la BC S103 en ensemencement direct Easy 2 Use sur les rouges depuis plusieurs années (dès que la température de la vendange dépasse 17°C).
Les procédés de fabrication optimisés du fabricant boostent la nutrition des levures et leur pouvoir de réactivation. Chaque cuve reçoit entre 25 et 80 tonnes de vendange ; on levure chaque cuve au début du remplissage, en une fois par saupoudrage.
Cet ensemencement direct ne pose aucune difficulté de fermentation, les FA démarrent le lendemain du levurage. Je ne fais pas de contrôle d’implantation, mais si des levures indigènes se développaient, le temps de latence serait beaucoup plus important, ou j’aurais des montées en volatile ce qui n’est pas le cas.
Par ailleurs, grâce à l’ensemencement direct, j’économise 20 min par cuve (le temps de réhydratation).
Je n’ai plus besoin de former le personnel, qui n’a plus à transporter d’eau chaude, ni à nettoyer de récipients.
C’est un énorme gain de temps.
« Grâce à l’ensemencement direct, nous économisons 20 minutes par cuve. »
Cave Coopérative LA GAILLARDE (Valréas 84) - Thierry Bonnet, Directeur
Conditions de réhydratation
S : différences Significatives (seuil) NS : différences Non-Significatives 10°C 17°C 24°C 30°C 37°C 43°C % viabilité après réhydratation 64 | FERMENTATION ALCOOLIQUE LEVURES
par
résultats
de vinification
Par besoin en azote assimilable
(minimum conseillé en intervalle en ppm)
sucre (présent en début FA)
180
SafOEnoTM
SafOEnoTM
Ratio azote
à 220
SafOEnoTM
SafOEnoTM
S135
SafOEnoTM
SafOEnoTM
Vinextase
à 220 ppm)
SafOEnoTM
S102
SafOEnoTM
SafOEnoTM
S62
SafOEnoTM
S135
SafOEnoTM
T18
Vinextase
Vinextase
Vinextase
SafSpirit
ppm)
0,9
SafOEnoTM
S102
SafOEnoTM
S325
SafOEnoTM
S377
+
assimilable/
en mg/g
Très faible : (160 à
ppm) ratio 0,7-0,8 •
BC S103 •
VR 44 • Vinextase Cassandra Faible : (160
ppm) ratio 0,7-0,8 •
SC 22 •
HD
•
HD 62 •
HD A54 •
Cassiopae Modéré : (180
ratio 0,8-0,9 •
CK
•
VR 44 •
HD
•
HD
•
HD
•
Aquilae •
Rosetta •
Cassiopae •
CO16 Fort : (>220
ratio >
•
CK
•
UCLM
•
UCLM
Choix
paramètres
Lente : • SafOEnoTM GV S107 • SafOEnoTM STG S101 • SafOEnoTM UCLM S377 • SafOEnoTM UCLM S325 Moyenne : • SafOEnoTM SC 22 • SafOEnoTM NDA 21 • SafOEnoTM HD A54 • SafOEnoTM CO16 Rapide : • SafOEnoTM VR 44 • SafOEnoTM HD S62 • SafOEnoTM HD S135 • SafOEnoTM HD T18 • Vinextase Aquilae • Vinextase Rosetta • Vinextase Cassiopae Très rapide : • SafOEnoTM BC S103 • SafOEnoTM CK S102 Par température de fermentation 10 à 30°C • SafOEnoTM VR 44 • SafOEnoTM BC S103 • SafOEnoTM CKS102 • SafOEnoTM GVS107 • SafOEnoTM HD A54 • SafOEnoTM HD T18 • Vinextase Cassiopae • Vinextase Rosetta • SafOEnoTM HD S135 • SafOEnoTM HD S62 • SafOEnoTM NDA 21 • SafOEnoTM SC 22 • SafOEnoTM UCLM S377 • SafOEnoTM UCLM S325 • SafOEnoTM STGS101 • SafSpiritTM CO16 • Vinextase Aquilae 14 à 30°C 17 à 30°C Pratique : Aide au choix de levures Température 20°C 28°C Haute Moyenne Faible HD S62 SC 22 STG S101 BC S103 VR 44 HD S135 NDA 21 Rondeur / SucrositéEvolution du Fruit Mûr Frais Structure HauteMoyenneFaible UCLM S377 Vinification en rouge Température 14°C Esters Arômes variétauxArômes variétaux Promotion Respect Faible Moyenne Haute Sucrosité/ rondeur 20°C BC S103A *Thiols/Terpènes VR 44F *C13 S325AF *C13/Terpènes CK S102A *Thiols/Terpènes GV S107F *Terpènes/C13 STG S101AF SC 22AF HD T18F *Terpènes/C13 HD A54A A/F : fermentation principale promotion des arômes (A : Amylique, F : Fruité) Vinification en blanc & rosé Basé sur les
des dernières recherches, voici les levures et dérivés classés selon les principaux critères de vinification, pour vous permettre un choix plus aisé en fonction de vos attentes. | 65 LEVURES
SafOEnoTM BC S103
Elle possède une grande résistance aux conditions extrêmes de vinification et d’excellentes caractéristiques fermentaires. Elle est adaptée à tout type de moût. Supplémentée en DAP, elle renforce la production d’esters. Idéale pour des prises de mousse en cuve.

Applications et doses
Les +
• Résistance aux conditions extrêmes de vinifications (hauts degrés, azote faible, fort taux de SO2, etc ).
• Cinétique Rapide.
• Polyvalente.
• Fructophile idéale en cas d’arrêt de FA (voir protocole).
• Sa très faible production de SO2 et ses besoins très faibles en Nass font de la SafOEno BC S103 la levure idéale pour les vins biologiques ou les vinification sans SO2

Impact Organoleptique Paramètres de fermentation
Intensité aromatique
Faible Moyenne Forte Très forte
Promotion des thiols et terpènes moyenne, notes amyliques à basse température.
Rondeur
Faible Moyenne Forte
Structure (rouges)
ND Légère Equil. Struct. Très struct.
Production/combinaison SO2
Faible moyenne
Production
Implantation & Facteur killer
La BC S103 rime avec efficacité et quiétude d’utilisations.
Je travaille comme consultant sur une cinquantaine de structures en Europe, qui vont de la cave coopérative régionale aux grands Châteaux. Je conseille souvent la SafOEnoTM BC S103 à mes clients, parce que c’est une bonne finisseuse qui s’implante rapidement.
Elle fonctionne très bien après les phases de bioprotection.
On peut l’ensemencer rapidement, dans les 24 à 72h et nous ne sommes pas obligé d’enchaîner deux levurages avec réhydratation et acclimatation. C’est aussi une très bonne solution pour les vendanges sur des parcelles éloignées du chai. Dès que les raisins ont été vendangés, il suffit de saupoudrer la levure et l’implantation commence pendant le transport. C’est très efficace et nous gagnons du temps. Et puis, je la conseille aussi en injection par raccord venturi parce qu’elle supporte très bien d’être directement aspirée lors du pompage de la vendange refroidie après thermovinification.
Pour moi, c’est une valeur sûre.
Moyenne Haute Forte
d’acidité volatile Très faible Faible Moyenne Forte Alcool 10 11 12 13 14 15 16 17 18 19 20 Besoins en azote 140 160 180 200 220 240 Ratio N ass/ Sucre (mg/g) 0,6 0,7 0,8 0,9 1 en ppm T°C conseillée de FA 5 10 15 20 25 30 35 en °C
Sensible mais bonne implantation
Vins tranquilles blancs/rosés et rouges : 10 - 20 g/hl Reprise de fermentation : 30 - 40 g/hl Prise de mousse : 15 - 40 g/hl Conditionnement(s) 500 g réf. 140702T5 10 kg réf. 14070210 Gamme SafOEnoTM
« Je conseille aussi la BC S103 en injection lors du pompage de la vendange refroidie, après la thermovinification. »
Stéphane Yerle - Ingénieur agronome et Œnologue consultant France, Espagne, Portugal & Europe de l’est
66 | FERMENTATION ALCOOLIQUE LEVURES
Elle dispose d’excellentes caractéristiques fermentaires et résiste aux conditions de vinification difficiles ! Elle est idéale pour les vins effervescents vinifiés en méthode traditionnelle.
Elle apporte une belle rondeur au vin et convient également à de nombreux vins rouges et blancs premiums.
Applications et doses
Les +
Résistance aux conditions extrêmes de vinifications (haut degrés, azote faible, fort taux de SO2,, etc).
Bonne prise de mousse.
Polyvalente.
Impact Organoleptique Paramètres de fermentation
Conditionnement(s)
Intensité aromatique


Moyenne Forte
valeur la complexité du fruit à
Rondeur
(rouges)
Implantation & Facteur killer
Cette souche respecte la typicité variétale des cépages avec une fermentation sûre et régulière qui s’adapte bien aux cépages Bordelais. Elle est idéale pour les fermentations en barrique car sa température ne nécessite pas d’être contrôlée. Elle est également particulièrement adaptée pour réhausser l’expression fruitée et la rondeur des vins blancs et des rosés à basse température.
Applications et doses
Les +
Départ rapide en fermentation.
Fermentation régulière.
Très faible production d’acidité volatile.
Impact Organoleptique
Paramètres de fermentation
Conditionnement(s)
SafOEnoTM
VR 44
•
•
•
Faible
Très forte Met en
basses températures.
Faible Moyenne Forte Structure
ND Légère Equil. Struct. Très struct. Production/combinaison SO2 Faible moyenne Moyenne Haute Forte Production d’acidité volatile Très faible Faible Moyenne Forte Alcool 10 11 12 13 14 15 16 17 18 19 20 Besoins en azote 140 160 180 200 220 240 Ratio N ass/ Sucre (mg/g) 0,6 0,7 0,8 0,9 1 en ppm T°C conseillée de FA 5 10 15 20 25 30 35 en °C
Caractère killer et excellente implantation.
Vins tranquilles blancs/rosés et rouges : 20 g/hl Reprise de fermentation : 30 - 40 g/hl Prise de mousse : 15 - 40 g/hl
500 g réf. 140699T5 10 kg réf. 14069910 SafOEnoTM SC 22
•
•
•
Intensité aromatique Faible Moyenne Forte Très forte Notes fruitées. Rondeur Faible Moyenne Forte Structure (rouges) ND Légère Equil. Struct. Très struct. Production/combinaison SO2 Faible Moyenne Moyenne Haute Forte Production d’acidité volatile Très faible Faible Moyenne Forte Alcool 10 11 12 13 14 15 16 17 18 19 20 Besoins en azote 140 160 180 200 220 240 Ratio N ass/ Sucre (mg/g) 0,6 0,7 0,8 0,9 1 en ppm T°C conseillée de FA 5 10 15 20 25 30 35 en °C Implantation & Facteur killer Sensible mais implantation rapide.
Vins tranquilles blancs/rosés et rouges : 20 g/hl
500 g réf. 140700T5 10 kg réf. 14070010 | 67 LEVURES
Pour des vins rouges premiums amples et fruités. Souplesse et sucrosité pour des vins équilibrés à fort degré alcoolique. Idéale pour les vins rouges fruités rapidement prêts à boire tels que le Merlot, le Cabernet Sauvignon, le Cabernet Franc, la Syrah, le Grenache, etc.

Applications et doses
Vins
Les +
• Résistance aux conditions extrêmes de vinifications (haut degrés, azote faible, fort taux de SO2, etc ).
• Apport de volume en bouche.
• En cas de sous maturité peut atténuer les notes végétales.
Impact Organoleptique Paramètres de fermentation
Conditionnement(s)
Intensité aromatique

de fruits rouges et noirs
Rondeur
Structure (rouges)
Production/combinaison SO2
Alcool
Implantation & Facteur killer
SafOEnoTM HD
S135
Faible Moyenne Forte Très forte Arômes
mûrs.
Faible Moyenne Forte
ND Légère Equil. Struct. Très struct.
Faible moyenne Moyenne Haute Forte Production d’acidité volatile Très faible Faible Moyenne Forte
10 11 12 13 14 15 16 17 18 19 20 Besoins en azote 140 160 180 200 220 240 Ratio N ass/ Sucre (mg/g) 0,6 0,7 0,8 0,9 1 en ppm T°C conseillée de FA 5 10 15 20 25 30 35 en °C
Sensible mais bonne implantation.
rouges : 20 g/hl Reprise de fermentation : 30 - 40 g/hl
500 g réf. 183496T5 10 kg réf. 18349610 68 | FERMENTATION ALCOOLIQUE LEVURES
Excellente extraction des polyphénols qui favorise l’élégance des vins rouges premium et exprime tout leur potentiel sur des gardes longues. Elle apporte également de la structure, de la couleur et des notes intenses et fruitées aux vins jeunes.
Applications et doses
Vins rouges : 20 g/hl
Reprise de fermentation : 30 - 40 g/hl
Prise de mousse : 15 - 40 g/hl
Les +
• Résistance aux conditions extrêmes de vinifications (haut degrés, azote faible, fort taux de SO2, etc).
• Forte extraction de polyphénols.

• Respect variétal.
Impact Organoleptique
Paramètres de fermentation
Conditionnement(s)
500 g réf. 187594T5 10 kg réf. 18759410
Intensité aromatique
d’esters moyennes, arômes fruités et épicés.
Rondeur
Structure (rouges)
Production/combinaison SO2
d’acidité
Implantation & Facteur killer
Pour des vins rouges premiums, structurés et de longue garde : Cabernet Sauvignon, Syrah, Zinfandel, etc. Elle convient aux vins subissant une longue macération (>10 jrs) à cause d’une cinétique lente permettant d’élaborer des vins finement structurés.
Également adaptée aux cépages de type méditerranéen : Malbec, Grenache.
Applications et doses
Les +
Cinétique fermentaire lente permettant des extractions poussées.

• Forte production de polysaccharides.
Forte production de glycérol (10g/L).
Impact Organoleptique Paramètres de fermentation
Bonne gestion et suivi de la FA nécessaires
Intensité aromatique
SafOEnoTM
HD S62
Faible Moyenne Forte Très forte Production
Faible Moyenne Forte
ND Légère Equil. Struct. Très struct.
Faible moyenne Moyenne Haute Forte Production
volatile Très faible Faible Moyenne Forte Alcool 10 11 12 13 14 15 16 17 18 19 20 Besoins en azote 140 160 180 200 220 240 Ratio N ass/ Sucre (mg/g) 0,6 0,7 0,8 0,9 1 en ppm T°C conseillée de FA 5 10 15 20 25 30 35 en °C
Sensible mais bonne implantation à T°C > 17°C.
SafOEnoTM UCLM S377
•
•
!
Faible Moyenne Forte Très forte Production d’esters élevées, arômes de fruits mûrs confiturés. Rondeur Faible Moyenne Forte Structure (rouges) ND Légère Equil. Struct. Très struct. Production/combinaison SO2 Faible moyenne Moyenne Haute Forte Production d’acidité volatile Très faible Faible Moyenne Forte Alcool 10 11 12 13 14 15 16 17 18 19 20 Besoins en azote 140 160 180 200 220 240 Ratio N ass/ Sucre (mg/g) 0,6 0,7 0,8 0,9 1 en ppm T°C conseillée de FA 5 10 15 20 25 30 35 en °C Implantation & Facteur killer Sensible mais bonne implantation .
Vins rouges : 20 g/hl Conditionnement(s) 500 g réf. 140705T5 10 kg réf. 14070510 Sur commande uniquement | 69 LEVURES
Cette souche donne des vins rouges intenses, harmonieux, fruités et épicés de garde courte. Elle apporte rondeur et équilibre aux Syrah et Merlot. Elle est également appréciée sur des cépages méditerranéens tel que le Mourvèdre.
Applications et doses
Les +
• Augmente la complexité aromatique.
• Apport de rondeur et d’équilibre en bouche.
• Peu productrice de soufre.
• Faible absorption de couleur.
Impact Organoleptique Paramètres de fermentation
Intensité aromatique
Rondeur
Structure (rouges)
Alcool
Implantation & Facteur killer
Conditionnement(s)
Sélectionnée pour sa forte production d’esters, elle convient parfaitement aux vins rouges fruités et légers. Recommandée pour les moûts ayant subi une macération préfermentaire à froid, pour les vins rouges primeurs issus d’une macération carbonique ou d’une thermovinification et pour les rosés (température à contrôler). Pinot noir, Gamay, Grenache.
et
Les +
• Cryophile (fermentation à partir de 8°C).

• Forte production d’esters.
• Excellente capacité. d’autolyse favorisant la FML.
Impact Organoleptique
Paramètres de fermentation
Intensité aromatique

Rondeur
(rouges)
SafOEnoTM
NDA 21
Faible Moyenne Forte Très forte Notes fruitées et épicées.
Faible Moyenne Forte
ND Légère Equil. Struct. Très struct. Production/combinaison SO2 Faible moyenne Moyenne Haute Forte Production d’acidité volatile Très faible Faible Moyenne Forte
10 11 12 13 14 15 16 17 18 19 20 Besoins en azote 140 160 180 200 220 240 Ratio N ass/ Sucre (mg/g) 0,6 0,7 0,8 0,9 1 en ppm T°C conseillée de FA 5 10 15 20 25 30 35 en °C
Sensible mais bonne implantation.
Vins rouges : 20 g/hl
500 g réf. 140704T5
SafOEnoTM STG S101
Faible Moyenne Forte Très forte Production d’esters élevée, arômes fermentaires et fruités.
Faible Moyenne Forte Structure
ND Légère Equil. Struct. Très struct. Production/combinaison SO2 Faible Moyenne Moyenne Haute Forte Production d’acidité volatile Très faible Faible Moyenne Forte Alcool 10 11 12 13 14 15 16 17 18 19 20 Besoins en azote 140 160 180 200 220 240 Ratio N ass/ Sucre (mg/g) 0,6 0,7 0,8 0,9 1 en ppm T°C conseillée de FA 5 10 15 20 25 30 35 en °C Implantation & Facteur killer Neutre et bonne implantation. Applications
doses Vins tranquilles rosés et rouges : 20 g/hl Conditionnement(s) 500 g réf. 140701T5 10 kg réf. 14070110 70 | FERMENTATION ALCOOLIQUE LEVURES
UNE APPLI POUR DES EXPERTS, PAR DES EXPERTS.









LA FERMENTATION, C’EST NOTRE MÉTIER.











Que vous soyez vignerons, vinificateurs, consultants ou distributeurs, vous trouverez dans notre application mobile des conseils et des outils très précis pour optimiser les fermentations, piloter les profils aromatiques ou encore sécuriser la production. Ce sont nos propres oenologues, ingénieurs et techniciens qui ont créé cette appli pour vous. Parce qu’entre experts, on se comprend.
 TÉLÉCHARGEZ
TÉLÉCHARGEZ
NOTRE APPLI ELLE EST FAITE POUR VOUS
SERGIO ALOISIO
Notre oenologue
commercial en
Amérique
du
Sud. Vinificateur
depuis 30
ans, il a contribué à la création
de
votre appli. | 71 LEVURES
Elle a été sélectionnée dans le Val de Loire sur le Sauvignon Blanc et convient aux blancs et rosés aux arômes très intenses. Elle favorise l’expression des thiols fruités et des terpènes (Sauvignon Blanc, Riesling, Gewürztraminer).
Résistante aux conditions de fermentation difficiles, elle valorise également les cépages neutres grâce à sa production élevée d’esters (Chardonnay).
Applications et doses
Vins tranquilles blancs/rosés : 20 g/hl


Les +
• Cryophile (fermentation à partir de 8°C).
• Forte production d’esters.
• Forte révélation des thiols.
• Phénotype Killer.
Impact Organoleptique
Paramètres de fermentation
Elle optimise l’expression aromatique des vins blancs. Son activité bêtaglucosidase élevée permet la libération de terpènes et de C13-Norisoprénoïdes (Muscat, Riesling, Viognier, Gewürztraminer, Pinot gris).
Elle a également de bons résultats sur les blancs aromatiques (Sauvignon Blanc, Sémillon) et sa faible résistance aux conditions de fermentation difficiles la rend idéale à la production de vins doux.
Applications et doses
Vins
: 20 à 30 g/hl
Conditionnement(s) 500 g réf. 140703T5 10 kg réf. 14070310
Intensité aromatique
Faible Moyenne Forte Très forte
Libération de thiols et de terpènes, notes tropicales et agrumes, bonne production d’esters.
Rondeur
Faible Moyenne Forte
Production/combinaison SO2
Faible moyenne
Alcool
Haute
d’acidité volatile
faible Faible Moyenne Forte
Implantation & Facteur killer
Neutre
Les +
• Forte révélation terpénique.
• Forte production de glycérol (10g/hl).
• Idéale pour vins doux.
Impact Organoleptique Paramètres de fermentation
Conditionnement(s)
500 g réf. 140706T5
Intensité aromatique
Maximise l’expression aromatique des cépages terpéniques et des C13-norisoprénoïdes (notes florales, agrumes).
Rondeur
& Facteur
SafOEnoTM CK S102
Moyenne
Forte Production
Très
10 11 12 13 14 15 16 17 18 19 20 Besoins en azote 140 160 180 200 220 240 Ratio N ass/ Sucre (mg/g) 0,6 0,7 0,8 0,9 1 en ppm T°C conseillée de FA 5 10 15 20 25 30 35 en °C
et bonne implantation.
SafOEnoTM UCLM S325
Faible Moyenne Forte Très forte
Faible Moyenne Forte Production/combinaison SO2 Faible moyenne Moyenne Haute Forte Production d’acidité volatile Très faible Faible Moyenne Forte Alcool 10 11 12 13 14 15 16 17 18 19 20 Besoins en azote 140 160 180 200 220 240 Ratio N ass/ Sucre (mg/g) 0,6 0,7 0,8 0,9 1 en ppm T°C conseillée de FA 5 10 15 20 25 30 35 en °C Implantation
killer Caractère Killer et bonne implantation .
blancs
72 | FERMENTATION ALCOOLIQUE LEVURES
Les +
• Forte révélation terpénique.
• Respect variétal.
• Phénotype Killer.
Elle optimise l’expression aromatique des vins blancs. Son activité bêtaglucosidase élevée permet la libération de terpènes et de C13-Norisoprénoïdes (Muscat, Riesling, Viognier, Gewürztraminer, Pinot gris). Elle a également de bons résultats sur les blancs aromatiques (Sauvignon Blanc, Sémillon) et sa faible résistance aux conditions de fermentation difficiles la rend idéale à la production de vins doux.
Applications et doses
Vins blancs : 20
Sulfitage séquentiel préconisé car sensiblité

Conditionnement(s)
Impact Organoleptique
Paramètres de fermentation
Les +
Forte révélation terpénique.
Respect variétal.
Phénotype Killer.
Elle apporte rondeur et complexité aromatique aux vins blancs premium. Elle est adaptée aux vins blancs ronds à fort degré alcoolique, élevés sur lies et subissant une fermentation malolactique. Elle convient aux vins complexes issus de cépages élégants comme le Chardonnay. Elle révèle doucement le potentiel aromatique des cépages avec des notes florales et fruitées.
Applications et doses
Vins blancs peu acides : 20 à 30
Conditionnement(s)
Intensité aromatique

Faible
Arômes floraux et agrumes, forte
de terpènes, bonne
d’esters.
Rondeur
:
fruitées, libération de terpènes et C13-norisoprénoïdes.
Rondeur
Implantation & Facteur killer
Caractère
SafOEnoTM HD T18
Moyenne Forte Très forte
révélation
production
Faible Moyenne Forte Production/combinaison SO2 Faible moyenne Moyenne Haute Forte Production d’acidité volatile Très faible Faible Moyenne Forte Alcool 10 11 12 13 14 15 16 17 18 19 20 Besoins en azote 140 160 180 200 220 240 Ratio N ass/ Sucre (mg/g) 0,6 0,7 0,8 0,9 1 en ppm T°C conseillée de FA 5 10 15 20 25 30 35 en °C
Killer et bonne implantation.
g/hl
au SO2
500 g réf. 195591T5 10 kg réf. 19559110
SafOEnoTM GV S107
Impact Organoleptique Paramètres de fermentation
•
•
•
Intensité aromatique Faible Moyenne Forte Très forte Production d’esters élevées
notes florales et
Faible Moyenne Forte Production/combinaison SO2 Faible moyenne Moyenne Haute Forte Production d’acidité volatile Très faible Faible Moyenne Forte Alcool 10 11 12 13 14 15 16 17 18 19 20 Besoins en azote 140 160 180 200 220 240 Ratio N ass/ Sucre (mg/g) 0,6 0,7 0,8 0,9 1 en ppm T°C conseillée de FA 5 10 15 20 25 30 35 en °C Implantation & Facteur killer Neutre et bonne implantation.
g/hl
500 g réf. 187610T5 10 kg réf. 18761010 NOUVEAUTÉ | 73 LEVURES
SafOEnoTM HD A54

SafOEno™ HD A54 confère aux vins des notes fruitées intenses évoquant la banane et la fraise, tout en renforçant la perception des notes florales.
Cette propriété permet également de masquer les notes végétales liées à des raisins vendangés en sousmaturité.
Sa capacité à maintenir une acidité totale élevée est intéressante pour garder un bon équilibre entre acidité, amertume et sucrosité, notamment dans le cas des vins blancs et rosés.
Applications et doses
Vins blancs/rosés/rouges : 20 g/hl
Sulfite séquentiel préconisé car sensiblité au SO2
Les +
• Production importante d’arômes fermentaires.
• Faible production de SO2
• Libération importante de bêta-damascénone.
Impact Organoleptique Paramètres de fermentation
Grâce à sa très faible production de SO2 et d’acidité volatile, cette souche montre une excellente compatibilité avec la fermentation malolactique dans le cas des vins rouges primeurs ou pour des vins à faible teneur en SO2
Intensité aromatique

Faible Moyenne Forte Très forte
Production élevée d’acétate d’isoamyle / alcool isoamylique et d’acétate de 2 phényléthyle / 2 phényléthanol.
Rondeur
Faible Moyenne Forte
Production/combinaison SO2
Faible moyenne Moyenne Haute Forte
Production d’acidité volatile
Très faible Faible Moyenne Forte
Alcool
Besoins en azote
Ratio N ass/ Sucre (mg/g)
conseillée de FA
Implantation & Facteur killer
Implantation
d’un
Conditionnement(s)
195618T5
19561810
AVEZ-VOUS PENSÉ À…
DÉTECTEUR DE CO2 PORTABLE - PSENSE
En cours de fermentation, du CO2 est libéré, ce détecteur portable va permettre de mesurer rapidement CO2, température et humidité relative de l’air affichés simultanément sur l’écran. Cet appareil, fonctionnant avec un système d’alarme, garantit aux vinificateurs de travailler en toute sécurité.
réf. 188391
10 11 12 13 14 15 16 17 18 19 20
140 160 180 200 220 240
0,6 0,7 0,8 0,9 1 en ppm T°C
5 10 15 20 25 30 35 en °C
moyenne nécessité
fort dosage à l’encuvage.
500 g réf.
10 kg réf.
NOUVEAUTÉ
74 | FERMENTATION ALCOOLIQUE LEVURES
Recommandations pratiques : REPRISE DE FERMENTATION
POUR TRAITER 100 HL DE VIN EN ARRET DE FERMENTATION, VOUS AUREZ BESOIN DE :

• 4 kg d’écorces de levure Springcell
• 3 kg de levure sèche active SafŒno™ BC S103
• 1 kg d’activateur de fermentation Vit’Azote P
• 3 kg d’activateur de fermentation Springferm
• 300 g de SO2
• 220 l d’eau non chlorée
• 25 kg de sucre
PROCEDURE :
1. TRAITEMENT DU VIN EN ARRET DE FERMENTATION (20 – 25°C)
• Soutirer le vin pour le séparer des lies (pour les vins rouges, soutirer avec aération et presser immédiatement)
• Sulfiter à 2-3 g/hl
• Ajouter 4 kg d’écorces de levure Springcell
• Effectuer un remontage doux pour homogénéiser
• Soutirer le vin après 24 - 48h
2. PREPARATION D’UN PIED DE CUVE DE 10 HL (20 - 25°C)
Dans une cuve de capacité > 10hl :
• 1re étape
Disperser 3 kg de SafŒno™ BC S103 dans 30 l d’eau propre à 25-30°C.
Après la réhydratation des levures, homogénéiser lentement et attendre 15 minutes.
• 2e étape
Ajouter : - 30 l de vin traité comme indiqué précédemment - 40 l d’eau non chlorée à 25 -30°C - 10 kg de sucre - 100 g de Springferm - 100 g de Vit’Azote P
Surveiller régulièrement la densité: dès qu’elle atteint d=1000, passer à l’acclimatation du pied de cuve.
3. ACCLIMATATION DU PIED DE CUVE (20 – 25°C)
• 1re étape : 500 l
Ajouter au pied de cuve : - 250 l de vin traité - 150 l d’eau non chlorée à 20 -25°C - 15 kg de sucre - 400 g de Springferm - 400 g de Vit’Azote P
Laisser reposer 24h avant de passer à l’étape 2.
• 2e étape : 10 hl
• Compléter les 500 l précédents par 500 l de vin traité
• Ajouter 500 g de Springferm + 500 g de Vit’Azote P
• Homogénéiser et laisser reposer 3h avant l’incorporation du pied de cuve
4. INCORPORATION DU PIED DE CUVE (20 - 25°C)
• Ajouter 2 kg de Springferm juste avant d’incorporer le pied de cuve dans le reste du vin
• Au cours d’un remontage aéré, incorporer le pied de cuve dans le vin
| 75
Gamme
Elle est recommandée pour les vins destinés à la production d’eaux-de-vie, alliant intensité et complexité aromatique. Cette souche est caractérisée par la promotion d’esters d’acétate (isoamyle, phényl-éthyle…) et de phényl-éthanol dans les vins, donnant des eaux-de-vie aux notes fruitées et florales intenses. Sa capacité à libérer des esters d’acides gras en fait une souche particulièrement adaptée à la distillation sur lies où elle apportera beaucoup de rondeur et de complexité aux eaux-de-vie. .
Les +
• Production très importante d’esters fermentaires.

• Production de notes florales et moyenne des autres alcools supérieurs.
• Acidité totale élevée en fin de fermentation alcoolique.

• Faible production d’acidité volatile.
• Faible production de sulfites. !
La SafSpirit CO-16 est actuellement en phase 3 d’observation par le Bureau National Interprofessionnel du Cognac (2017 – 2019).
Impact Organoleptique Paramètres de fermentation
Intensité aromatique
Implantation
SafSpiritTM CO16
Faible Moyenne Forte Très forte Production d’esters élevés et moyenne d’alcools supérieurs. Rondeur Faible Moyenne Forte Production/combinaison SO2 Faible moyenne Moyenne Haute Forte Production d’acidité volatile Très faible Faible Moyenne Forte Alcool 10 11 12 13 14 15 16 17 18 19 20 Besoins en azote 140 160 180 200 220 240 Ratio N ass/ Sucre (mg/g) 0,6 0,7 0,8 0,9 1 en ppm T°C conseillée de FA 5 10 15 20 25 30 35 en °C
Bonne implantation. Applications et doses Vins de base avant distillation : 20 g/hl Conditionnement(s) 500 g réf. 188390T5 Sur commande
SafSpiritTM 76 | FERMENTATION ALCOOLIQUE LEVURES
Vinextase® Aquilae


Levure Saccharomyces cerevisiae pour la production de vins rouges type Nouveau Monde, structurés, ronds et aromatiques.
l’expression variétale des cépages rouges
et doses
Les +
en fermentation
Fermentation régulière.
Organoleptique
Implantation & Facteur killer
Impact
Paramètres de fermentation
Favorise
• Départ
rapide. •
• Favorise les notes fruitées. Intensité aromatique Faible Moyenne Forte Très forte Production de notes fruitées. Rondeur Faible Moyenne Forte Production/combinaison SO2 Faible moyenne Moyenne Haute Forte Production d’acidité volatile Très faible Faible Moyenne Forte Alcool 10 11 12 13 14 15 16 17 18 19 20 Besoins en azote 140 160 180 200 220 240 Ratio N ass/ Sucre (mg/g) 0,6 0,7 0,8 0,9 1 en ppm T°C conseillée de FA 5 10 15 20 25 30 35 en °C
Neutre et bonne implantation.Applications
Vins rouges : 20 g/hl Conditionnement(s) 500 g réf. 140708T5 10 kg réf. 14070810 Gamme Vinextase® | 77 LEVURES
Vinextase® Cassiopeae
Levure permettant d’allier la sécurité fermentaire à une forte production d’arômes fermentaires. Particulièrement adaptée à l’élaboration de vins blancs et rosés à fort potentiel alcoolique. Très bonne fermentescibilité à basse température : 10 – 17°C

Applications et doses
Les +
Sécurité fermentaire même en conditions difficiles (hauts degrés et températures basses).

Faible production de SO2 et d’AV.
Organoleptique
de fermentation
Impact
Paramètres
•
•
Intensité aromatique Faible Moyenne Forte Très forte Production d’arômes fermentaires. Rondeur Faible Moyenne Forte Production/combinaison SO2 Faible moyenne Moyenne Haute Forte Production d’acidité volatile Très faible Faible Moyenne Forte Alcool 10 11 12 13 14 15 16 17 18 19 20 Besoins en azote 140 160 180 200 220 240 Ratio N ass/ Sucre (mg/g) 0,6 0,7 0,8 0,9 1 en ppm T°C conseillée de FA 5 10 15 20 25 30 35 en °C Implantation & Facteur killer Caractère killer et bonne implantation.
Vins blancs et rosés : 20 g/hl Reprise de fermentation : 30 à 40 g/hl Conditionnement(s) 500 g réf. 140707T5 10 kg réf. 14070710 78 | FERMENTATION ALCOOLIQUE LEVURES
Les +
Départ rapide en fermentation.
Résistance à l’alcool.
Cryophile.
Levure sélectionnée pour sa capacité à produire des arômes fermentaires pour l’élaboration de vins rosés technologiques. Elle développe des notes aromatiques sur les cépages blancs neutres.
Applications et doses
Cassandra est une préparation humide d’une souche particulière de Saccharomyces bayanus, sélectionnée en raison de ses caractéristiques de finesse qu’elle confère aux vins qu’elle fermente. Son utilisation présente un intérêt particulier dans la vinification de produits aux degrés d’alcool élevés ainsi que dans les prises de mousse. Elle garantit un départ sûr et rapide du processus de fermentation, y compris en présence de degrés d’alcool élevés. Utilisation tardive possible avec le bâtonnage.
Applications et doses
Vins fermentation : 10 à 20 g/hl
Reprise FA : 20 à 30 g/hl
Elevage (apport de rondeur) :
à 100g/hl
Impact Organoleptique
Paramètres de fermentation
Les +
• Simple d’utilisation et départ en fermentation rapide.
• Protection contre l’oxydation (en élevage), bonne contribution à la stabilité colloïdale, protéique et tartrique.


Intensité aromatique
& Facteur killer
Paramètres de fermentation
Implantation
500 g
Conditionnement(s)
Vinextase® Rosetta
•
•
•
Faible Moyenne Forte Très forte Production d’esters avec un débourbage poussé à 50-100 NTU et fermentation à basse T°C. Rondeur Faible Moyenne Forte Production/combinaison SO2 Faible moyenne Moyenne Haute Forte Production d’acidité volatile Très faible Faible Moyenne Forte Alcool 10 11 12 13 14 15 16 17 18 19 20 Besoins en azote 140 160 180 200 220 240 Ratio N ass/ Sucre (mg/g) 0,6 0,7 0,8 0,9 1 en ppm T°C conseillée de FA 5 10 15 20 25 30 35 en °C Implantation
Caractère killer et bonne implantation.
Vins blancs et rosés : 20 g/hl Conditionnement(s) 500 g réf. 190983T5
Vinextase® Cassandra Impact Organoleptique
! Conservation à 4°C Intensité aromatique Faible Moyenne Forte Très forte Rondeur Faible Moyenne Forte Production/combinaison SO2 Faible moyenne Moyenne Haute Forte Production d’acidité volatile Très faible Faible Moyenne Forte Alcool 10 11 12 13 14 15 16 17 18 19 20 Besoins en azote 140 160 180 200 220 240 Ratio N ass/ Sucre (mg/g) 0,6 0,7 0,8 0,9 1 en ppm T°C conseillée de FA 5 10 15 20 25 30 35 en °C
Bonne implantation.
50
réf. 183659T5 Par 4 pains de 500g | 79 LEVURES
CAP Vinicole
ADMINISTRATIVE
POURQUOI la Conduite de vinification ?

C’est le bénéfice de l’expertise des consultants Vitivalor en matière de démarches administratives, pour optimiser votre temps et vos ressources.
POUR QUELS RÉSULTATS ?
Montage des dossiers d’aide aux
Réalisation des
sur Pro.douane.
Réalisation des
auprès des
Réalisation des déclarations de mise en conformité environnementale :
Des experts Vitivalor à votre
pour
démarches
à
d’intervention de
Vinicole GESTION ADMINISTRATIVE
ICPE, gestion des

de cave, ADELPHE.
Mise en place de la traçabilité cave obligatoire : registre de cave, obligations ODG.
Domaines
CAP
• Visite préalable : identification de votre problématique. • Etablissement d’un cahier des charges. • Réalisation des tâches administratives déléguées.
investissements vitivinicoles.
déclarations obligatoires
déclarations obligatoires
ODG.
déclaration
effluents
service
gérer vos
administratives liées
l’élaboration du vin. GESTION
Vitivalor Solutions©, l’expertise Viti-Vinicole 360° E-mail : contact@vitivalor.com WWW.VITIVALOR.COM
FERMENTATION MALOLACTIQUE
| 81 Avec notre partenaire Chr. Hansen, nous vous apportons un outil incomparable pour suivre votre fermentation malolactique grâce à une gamme complète de bactéries à ensemencement direct (technologie DVS®). 84 | Les bactéries lactiques Viniflora 86 | Stabiliser le vin en réalisant la FML tout en préservant le fruité du vin 88 | Actions curatives pour les fermentations difficiles 90 | Sécurité alimentaire avec biogènes
AMONT DE LA VINIFICATION
FERM. MALO.
FERM. ALCOOL.
BIO-PROTECT. DES MOÛTS
ENZYMES
PRODUITS SULFUREUX
PROTECTION CORRECTION VENDANGES
TANINS & DÉRIVÉS DU BOIS
PRODUITS DE COLLAGE
CORRECT. ET STAB. DES VINS FILTRATION DES VINS HYGIÈNE
Le concept de l’ensemencent direct vous apporte de la facilité : ouvrir un sachet, verser son contenu dans la cuve … c’est tout. La magie de l’inoculation directe : pas de préparation. De la régularité : grâce à l’expertise et au savoir-faire de Chr. Hansen dans la production de bactéries, nous vous certifions par une série de contrôles qualité avec notamment le test exclusif ‘MACC’ de mettre à votre disposition des bactéries adaptées à vos vins et prêtes à l’emploi.
Du contrôle : grâce à Viniflora® vous gardez le contrôle de vos fermentations malolactiques. Vous savez combien de jours dureront vos fermentations, vous pouvez optimiser le travail fait en amont et obtenir la quintessence du raisin au travers des fermentations.
Un retour sur investissement : les divers bénéfices à l’utilisation de Viniflora® dépendent du type de vin, du process de vinification, de l’équipement en cave.
CO-INOCULATION
Ensemencement des bactéries lactiques réalisé au même moment que les levures. L’objectif de cette technique est d’assurer le succès de la fermentation malolactique (FML) tout en maîtrisant les microorganismes qui peuvent causer les déviations aromatiques.
Les +
• Vins fruités.
• Mise en marché rapide.
• Éviter toute sorte de contamination.
CO-INOCULATION TARDIVE
Ensemencement des bactéries vers la fin de la fermentation alcoolique (densité = 1,010 à 1,000).
CO-INOCULATION SÉQUENTIELLE
Ensemencement une fois que la FA se termine ou à l’écoulage.
L’INOCULATION INVERSÉE
Une nouvelle façon de fermenter les moûts, la FML se déroule avant la FA dans des cas très spécifiques grâce à la nouvelle souche NoVA™.

Les +
• Apport du gras et intensité aromatique.
• Mise en marché rapide.
• Éviter toute sorte de contamination microbienne.
Les +
• Complexité et structure.
• Profil aromatique inaltéré.
Les +
• Gain de temps.
• Pas de risque de piqûres lactiques.
• Idéale pour les vinifications sans SO2
82 | FERMENTATION MALOLACTIQUE FERMENTATION MALOLACTIQUE

Point sur les différentes formulations des bactéries lactiques Chr. Hansen UFC/gramme Inoculation Directe Viniflora® UFC/ml viables après inoculation Activité métabolique de chaque batch produit Freeze-Dried Élevé > 2,8E + 06 UFC/ml vin 2,8 x M > 2,0E + 06 UFC/ml vin 2,0 x M 1 g/hl = > 1,4E + 06 UFC/ ml vin 1,4 x M Élevé Élevé OUI OUI OUI FroZen Expert UFC = Unité Formant Colonie = bactéries actives M = “Numéro Magique“ = minimum de concentration pour le fermentation malolactique Test d’activité = spécification internet pour chaque batch | 83 LES FORMULATIONS DE BACTÉRIES LACTIQUES Viniflora® FreasyTM Les bactéries ‘FroZen’ de Chr. Hansen, disponibles pour tous ! Gérez vos fermentations malolactiques avec le produit phare du marché • 3 souches couvrant toutes les situations : CH11, CH16 et CiNeTM • des bactéries ‘FroZen’ disponibles chez Soufflet Vigne à -45°C, stockables au chai à -18°C • un conditionnement : 50HL pour plus de flexibilité • un ensemencement direct : pour plus de facilité, un seul geste suffit • un produit de haute qualité : concentration et viabilité vérifiées pour des fermentations sécurisées • un service de proximité associé : bénéficiez de nos conseils
BACTÉRIES LACTIQUES
Les bactéries lactiques Viniflora
Tableau de synthèse pour vos choix de bactéries pour vos fermentations malolactiques.
moderne
T°C / pH bas Contrainte de Temps
La plupart des vins
Tous les produits FroZen™ sont prêts à l’emploi pour une inoculation directe et disponibles en poches de 100 hl et 250 hl (sauf la CH35 qui est disponible seulement en 100 hl).
MALOCHECK
Alcool élevé Maturité élevée
Les produits FreasyTM sont prêts à l’emploi pour une inoculation directe et disponibles en cartons ou poches pour 50 hl que vous pouvez stocker dans un congélateur à -18°C durant les 3 mois précédant leur utilisation.

Souche pour réaliser la FML en co-inoculation inversée
Conditions extrêmes. Souche pour FML curative
Les bactéries sont des organismes vivants et le vin est un environnement hostile pour elles : toujours vérifier la température, l’alcool, le pH et le SO2 total maximum avant l’inoculation.
Malocheck est un Outil d’Aide à la Décision simple, utilisable sur smartphone ou PC via le navigateur. Il vous aidera à sélectionner la culture bactérienne Viniflora® la plus adaptée à vos conditions de vin, vous conduisant à une fermentation malolactique réussie.

Entrez les paramètres de votre vin et laissez-nous vous guider vers le bon choix ! malocheck.chr-hansen.com

84 | FERMENTATION MALOLACTIQUE
Souche Viniflora® CH35 Avec le plus large spectre Viniflora® CiNe™ Conserve le fruit Viniflora® CH11 La plus rapide Viniflora® Oenos La référence Viniflora® CH16 Résistante à l’éthanol Viniflora® Nova L’outsider Viniflora® Sparta La 4x4 Couleur du vin Arômes FML Oui Non Oui Oui Oui Oui Oui Température 15–25˚C 17–25˚C 14–25˚C 17–25˚C 17–25˚C 18–28˚C 15–25˚C Alcool max 14% vol 14% vol 15% vol 14% vol 16% vol 5% vol 16% vol pH Minimum 3.1 3.2 3.0 3.2 3.4 3.5 3 SO2 total maximum 45 mg/l 30 mg/l 35 mg/l 40 mg/l 40 mg/l 15 mg/l 45 mg/l Résumé Contrôle les FML SO2 Haut Fruité,
et effervescent
VINIFLORA CH16TM EXPERT
Viniflora CH16 expert est une version moins concentrée (1,4 x 106 UFC/mL vin) de Viniflora CH16 permettant d’avoir un produit suffisament concentré pour réaliser la FML (bactéries > 106 UFC/ ml de vin pour déclencher la FML) à un coût réduit. Ce produit est à utiliser lors de millésimes où les conditions sont très favorables pour réaliser la FML.
Conservation
-18°C pour les cuves de 2,5hL et 25hl -45°C pour les cuves de 50, 100 et 250 hl
VINIFLORA CH35TM
Haute performance et grande capacité à réaliser la fermentation malolactique sur des vins difficiles ou dans des conditions délicates. Elle fonctionne parfaitement sur vins rosés et blancs ainsi que sur les vins rouges où elle a également été testée à ensemencement direct.
Conservation
-18°C pour les cuves de 2,5hL et 25hl -45°C pour les cuves de 50, 100 et 250 hl
VINIFLORA OENOSTM
La souche de bactérie lactique standard, référence du marché, à ensemencement direct.
Conservation
-18°C pour les cuves de 2,5hL et 25hl -45°C pour les cuves de 50, 100 et 250 hl
Les +
• Coût réduit pour les millésimes aux malo “faciles”.
• Produit à concentration plus faible.
VINIFLORA CH16TM
Performance remarquable à conduire la fermentation malolactique dans des vins rouges à fort degré alcoolique (jusqu’à 16% Vol) avec un pH > 3.4. Bactérie à ensemencement direct.
Les +
• La souche de référence pour vins de pH bas ou pour vins rouges nécessitant des FML rapides (thermo, primeurs…).
• Pas de production d’amines biogènes.
Conditionnement(s)
Viniflora CH16 expert 250hL réf. 187238
Conservation
-18°C pour les cuves de 2,5hL et 25hl -45°C pour les cuves de 50, 100 et 250 hl
Conditionnement(s)
CH16 - 2,5 hl réf. 134577
CH16 - 25 hl réf. 129735
CH16 FREASY - 50 hl réf. 164400
LS CH16 - 100 hl réf. 129731
CH16 - 250 hl réf. 128250
LS CH16 - 250 hl réf. 129734
Les +
• Souche spécifique des vins blancs et rosés.
• Bonne résistance au SO2
• Pas de production d’amines biogènes.
Conditionnement(s)
CH35 - 2,5 hl réf. 115641
CH35 - 25 hl réf. 115642
LS CH35 - 100 hl réf. 134578
LS CH35 - 250 hl réf. 129730
VINIFLORA CH11TM
Souche de bactérie lactique de type Oenococcus oeni à ensemencement direct. Cette bactérie lactique hétéro-fermentaire a été soigneusement sélectionnée pour réaliser une fermentation malolactique rapide et sûre.
Conservation
-18°C pour les cuves de 2,5hL et 25hl -45°C pour les cuves de 50, 100 et 250 hl
Les +
• La souche de référence pour vins de pH bas ou pour vins rouges nécessitant des FML rapides (thermo, primeurs…).
• Pas de production d’amines biogènes.
Conditionnement(s)
CH11- 25 hl réf. 133214
CH11 FREASY - 50 hl réf. 174529
LS CH11- 100 hl réf. 133213
LS CH11- 250 hl réf. 134647
VINIFLORA NOVATM
Les +
• Adapté à la majorité des vins rouges classiques.
• Pas de production d’amines biogènes.
Conditionnement(s)
OENOS - 2,5 hl réf. 134579
OENOS - 25 hl réf. 129736
LS OENOS - 100 hl réf. 129737
OENOS - 250 hl réf. 129732
LS OENOS - 250 hl réf. 129733
Souche de bactérie lactique de type Lactobacillus plantarum, souche homofermentaire à utiliser sur moût en ensemencement direct avant l’addition de levure et le début de la fermentation alcoolique. Utilisable en Bioprotection, voir page 45
Conservation
-18°C pour les cuves de 2,5hL et 25hl -45°C pour les cuves de 50, 100 et 250 hl
Les +
• Permet de réaliser la FML avant la fermentation alcoolique, se référer à votre conseiller Soufflet Vigne pour sa bonne utilisation.
• A utiliser sur des moûts non sulfités et pH > 3.5.
• Réduction des doses de SO2
Conditionnement(s)
VINIFLORA FROZEN NOVA - 50 hl réf. 178133
| 85 BACTÉRIES LACTIQUES
Stabiliser le vin en réalisant la FML tout en préservant le fruité du vin
VINIFLORA CINETM
Souche de bactérie lactique de type Oenococcus oeni citrate négative à ensemencement direct. Cette souche ne dégrade pas l’acide citrique, elle permet de conserver le fruité des vins en ne produisant pas de diacétyle.
Les +
• Des vins plus fruités : pas de production de notes beurrées / lactées.
• Idéal pour produire des vins sans sulfite ou réalisés avec un minimum de SO2

• Pas de production d’amines biogènes.
la production d’acidité volatile
co-inoculation sur vin rouge.
Conversation
Conditionnement(s)
Le respect du profil pour moins de SO2
Viniflora CINE est une souche unique sur le marché. Citrate négative stricte brevetée, elle permet de réaliser la FML, sans production de diacétyle (goût beurré, lacté caractéristique de la FML).
Il est maintenant possible de réaliser la FML sur des vins où cet impact organoleptique n’était pas souhaité (blancs thiolés, rosés). La dégradation de l’acide citrique par les autres bactéries lactiques accompagne généralement d’une augmentation de l’acide acétique dans le vin. En utilisant CINE nos utilisateurs peuvent limiter l’acidité volatile de leur vin. Elle est très utilisée en co-inoculation sur rouge à cet effet.
CINE est une solution pour diminuer le SO2 total sur blancs et rosés, la FML stabilise le vin microbiologiquement. Le sulfitage habituel post FA et tout au long de l’élevage peut-être raisonné pour lutter uniquement contre l’oxydation.
CINE accentue les notes fruitées du vin, en association avec Concerto c’est la combinaison parfaite pour réaliser des blancs et rosés frais et aromatiques, tout en diminuant le SO2, répondant ainsi aux attentes du marché.
« Viniflora CINE est une souche formidable pour les vins respectant les attentes sociétales.»
Guillaume Comte, Responsable Œnologie/Hygiène France, Technico-commercial Vinextase® Oenologie
• Limite
en
FREASY CINE - 50 hl réf. 174851 LS CINE - 250 hl réf. 134530
-18°C pour les cuves de 2,5hL et 25hl -45°C pour les cuves de 50, 100 et 250 hl
86 | FERMENTATION MALOLACTIQUE STABILISER LE VIN
PRINCIPALE VOIE DE PRODUCTION DE DIACÉTYLE PAR O. OENI
Paroie cellulaire de la bactérie
• La production de diacétyle provient du catabolisme de l’acide citrique, et ce processus se produit vers la fin de FML
• L’acide malique est le substrat préférentiel pour Oenoccus oeni. Toutefois au cours de la FML quand ce substrat se rarifie, les cellules commencent à consommer l’acide citrique présent.
• Une fois que l’acide citrique est épuisé, Oenoccus oeni va alors consommer le diacétyle produit.
• Le seuil de perception du diacétyle : 3-4 µg/l
26 (2009) 197-203
161 special (2016)
Viniflora® CiNeTM Citrate perméase négative (2)
Aerobie Décarboxylation chimique Arômes Beurré-Lacté
VINIFLORA CINETM - BACTÉRIE LACTIQUE CITRATE NÉGATIVE STRICTE
(1)
(1) N. Olgin et al./food Microbiology
(2) S. Saeren et al./Revue des Oenologues
65-67
Acide citrique Acide citrique Citrate perméase Citrate Acétate Oxaloacétate Acide pyruvique Acétoine Butane-2,3-dione a-acetolactate CO2 CO2 O2 Diacétyle Fig.1 Effet de la température et des souches de bactéries pour la production de diacétyle Diacétyle (mg/l) 0 Control (No MLF) CiNe CH11 CH35 20°C 16°C 4 3 2 1 0 0 5 10 15 Acide malique (g/l) Acide malique Temps (jours) CiNe Oenos CiNe Oenos Acide citrique 400 300 200 100 0 0 5 10 15 Acide citrique (g/l) Temps (jours) Diacetyle [ppb] 0 20 40 60 CH11 20°C CH11 16°C CiNe 20°C CiNe 16°C Diacetyle : 3-4 µg/l > Inférieur au seuil de perception Pas d’absorption de citrate > Pas de dégradation du citrate en diacétyle et acétoïne > Pas de saveur de beurre Publication “Revue des Oenologues, N°161 special, Nov 2016, pp 65-68“ Beurre Blend Roussanne & Marsanne 7 6 5 4 3 2 1 0 CeriseCitronRaisinAnanasManguePommePoireFigueAbricotNoisetteAmandePoivreCannelleGirofleRéglisseCuirRoseVioletteMielHerbefraîcheTabacCitronvertVerbenaVerveineCacaoCaféToastéRôtiFuméBeurréLacté Fréquence de cotation des arômes (In senso veritas, avril 2012) Control CiNe CH35 | 87 STABILISER LE VIN
Actions curatives pour les fermentations difficiles
VINIFLORA SPARTATM
Viniflora® SPARTA™ a été sélectionnée parmi 156 souches d’Oenococcus oeni pour ses performances à pH bas, à basse température et à des niveaux en SO2 élevés. Avec SPARTA™, l’inoculation des vins difficiles devient plus facile et plus fiable.
Les +
• En cas d’arrêt ou non déclenchement de FML, permet d’assurer une FML, même en conditions difficiles.
• Forte concentration de bactéries : SPARTA™ est concentrée à au moins 2E+13 UFC/ sachet ou 50MLU1(500g)bactérie frozen hyper concentrée.
• Un dosage flexible :
- SPARTA™ adaptée 1MLU à 1HL pour des FML lentes ou arrêtées, pour des millésimes aux conditions difficiles > Inoculer 1 sachet de SPARTA™ pour 50HL EN CONDITIONS
DIFFICILES ;
- pour des vins plus faciles, un dosage ajusté de SPARTA™, 1 MLU à 2-4HL, facilite la FML > Inoculer 1 sachet de SPARTA™ pour 100 à 200HL.
Conditionnement(s)
SPARTA 50 MLU réf. 187237
AIDE LA FERMENTATION EN CONDITIONS DIFFICILES
Conversation -18°C pour les cuves de 2,5hL et 25hl -45°C pour les cuves de 50, 100 et 250 hl
SPARTATM
Performance de SPARTATM sur Riesling à pH bas Performance de SPARTATM avec un SO2 élevé Acide malique (g/l) 7 6 5 4 3 2 1 0 Temps (jours) 0 5 10 15 20 Control SPARTATM SPARTATM + BACTIV-AID 0,15 g/l SPARTATM + BACTIV-AID 0,30 g/l 7 6 5 4 3 2 1 0 Acide malique (g/l) Temps (jours) 0 2010 10 5040 60 Control CH35 SPARTATM Addition de 0,15 g/l BACTIIV-AID après 28 jours SPARTATM DÉBLOQUE DES FML COMPLIQUÉES Merlot Vinification traditionnelle macération logue - Bordeaux Gamay, macération pré fermentaire à chaud - France* Château 1 Arrêt de FLM2 Château 2 FLM languissante3 Château 3 Pas de FLM spontanée4 Date Malique (g/l) FML (%) Date Malique (g/l) FML (%) Date Malique (g/l) FML (%) 03/01 1,3 50 30/10 0,9 60 19/12 0,8 29/11 0,7 15/12 0,9 03/01 0,7 13/12 0,7 22/12 0,6 11/01 0,6 05/01 0,5 27/12 0,5 18/01 0 10/01 0,5 03/01 0,5 12/01 0,4 11/01 0,5 17/01 0 18/01 0 Inoculation avec SPARTATM Co-inoculation (48h) 12.55% vol. Co-inoculation tardive (après pressurage) 12.1%vol. Co-inoculation tardive (après pressurage) 12.64%vol. Date Malique (g/l) MLF (%) Date Malique (g/l) MLF (%) Date Malique (g/l) MLF (%) 09/10 2.9 0 04/10 2.8 0 10/10 2.6 0 10/10 2.9 0 05/10 2.8 0 11/10 2.6 0 11/11 2.9 0 06/10 2.6 3 13/10 2.6 0 12/10 2.9 3 07/10 2.2 14 15/10 2.4 4 13/10 2.9 5 09/10 1.9 27 16/10 2.2 6 14/10 2.8 8 11/10 0.7 60 17/10 1.6 27 16/10 2.6 11 13/10 0.1 94 18/10 0.8 82 17/10 2.4 32 14/10 0.1 94 19/10 0 100 18/10 1.6 80 16/10 0 100 19/10 0.4 90 21/10 0.3 92 22/10 0.2 95 24/10 0 100 *inoculation avec SpartaTM + Bactiv-Aid 88 | FERMENTATION MALOLACTIQUE ACTIONS CURATIVES POUR LES FERMENTATIONS DIFFICILES
Azote et fermentation malolactique
Les bactéries lactiques ne peuvent assimiler que les acides aminés (sauf la proline) et les petits peptides afin de synthétiser leurs protéines, c’est ce l’on appelle le FAN (Free Amino Nitrogen) mesurable par méthode de dosage enzymatique qui détermine le Bacterial Assimilable Nitrogen (BAN).
Il a été estimé qu’un BAN supérieur à 60mg/l est nécessaire à la croissance bactérienne et au bon déroulement de la FML. Une analyse avant ensemencement permet de mieux gérer cette fermentation capricieuse. La majorité des FML est réalisée par une souche de l’espèce Oenococcus oeni. Cette espèce a des besoins spécifiques et intraspécifiques en azote, ces besoins varient d’une souche à l’autre. Les différentes souches commerciales du marché (et indigènes) ont un besoin différent en azote ce qui peut expliquer dans certains cas, sans apport, des différences de comportement et de réussite pour la FML.
L’azote organique du milieu est donc un élément nécessaire pour la FML. Il existe plusieurs solutions pour corriger cette carence :
Travailler dès la vigne pour éviter des carences dans le moût (cf. Ferti-oeno en début de ce catalogue) ;
- Un apport indirect en amont par des apports de levures non-Saccharomyces en co-inoculation séquentielle qui vont libérer leurs acides aminés dans le milieu avant la fin de la FA, ou par des apports d’azote organique au cours de la FA ;
- Un apport d’autolysat de levures riche en azote organique pour la FML.
Vinextase® Oenologie distribue un activateur de fermentation malolactique Bactiv-aid 2.0 afin de garantir les meilleures conditions en nutriments pour l’inoculation des différentes souches Viniflora®
BACTIV-AID 2.0
Nutriment sélectionné pour les bactéries lactiques. Pour moûts et vins carencés en azote.

Les +
• Gain de temps pour la fermentation malolactique.
• Recommandé sur vins à degrés alcooliques élevés.
Conversation
-18°C pour les cuves de 2,5hL et 25hl -45°C pour les cuves de 50, 100 et 250 hl
Conditionnement(s)
Dose pour 25 hl réf. 129728
Dose pour 250 hl réf. 129729
| 89 AZOTE ET FERMENTATION MLOLACTIQUE
Sécurité alimentaire avec biogènes

SÉCURITÉ ALIMENTAIRE AVEC
Les acides aminés (histidine par exemple) présents dans le moût sont les substrats à l’origine de la synthèse d’amines biogènes par certaines souches indigènes, l’utilisation des souches commerciales évite ce problème.
Les souches indigènes de bactéries lactiques présentes lors de FML spontanée peuvent produire des amines biogènes.
Celles-ci sont métabolisées à partir de certains acides aminés précurseurs du moût par des enzymes décarboxylases.
Les souches commerciales sont sélectionnées sans les gènes produisant les enzymes responsables de cette voie de biosynthèse.
Les principales amines biogènes retrouvées dans les vins produits par les micro-organismes : Histamine (acide aminé précurseur : histidine => allergène connu)
Putrescine (acide aminé précurseur : ornithine) Cadavérine (acide aminé précurseur : lysine)
Tyramine (acide aminé précurseur : tyrosine)
Ces molécules (putrescine, cadavérine) ont aussi un impact négatif sur la qualité organoleptique du vin)
Elevée Non significatif Significatif Significatif Modérée Non significatif Non significatif Significatif Faible Non significatif Non significatif Significatif Faible Modérée Elevée Gravité (effet inverse) Probabilité Exemple de référentiel HACCP Histamine Comment éviter les amines biogènes dans les vins ? Spontanée Viniflora CH16 Moût initial Après la fermentation alcoolique Après la fermentation malolactique Histamine ppm 0,0 0,5 1,5 2,5 1,0 2,0 3,0 90 | FERMENTATION MALOLACTIQUE
BIOGÈNES
PRODUITS DE COLLAGE
92 | Les protéines végétales et levuriennes
93 | Les produits de la gamme Natura (biopolymères)
98 | Les produits de collage traditionnels (considérés comme allergènes)
Le collage est une étape fondamentale pour la stabilisation protéique et la clarification naturelle des moûts et des vins. Il permet d’éliminer, par précipitation, les protéines, les complexes colloïdaux, à l’origine de déviations organoleptiques et de troubles. C’est une étape essentielle pour l’affinage aromatique et la réduction des caractères astringents.
| 91
AMONT DE LA VINIFICATION
PRODUITS DE COLLAGE
FERM. MALO.
FERM. ALCOOL.
BIO-PROTECT. DES MOÛTS
ENZYMES
PRODUITS SULFUREUX
PROTECTION CORRECTION VENDANGES
TANINS & DÉRIVÉS DU BOIS CORRECT. ET STAB. DES VINS FILTRATION DES VINS HYGIÈNE
Produits de collage
Les protéines végétales et levuriennes, un effet comparable aux oeufs et au lait
Afin d’évaluer les propriétés des protéines végétales, il est nécessaire de tenir compte des mécanismes qui caractérisent ces interactions et interviennent dans la réaction de l’adsorption. La charge électrique superficielle est un paramètre fondamental pour comprendre le fonctionnement de ces produits. La charge électrique influence les interactions par rapport aux macromolécules, en dispersion colloïdale, qui peuvent changer la qualité d’un vin autant que la couleur, les arômes, la structure et la souplesse.
Le schéma suivant représente une vinification typique pour un vin blanc avec les adjuvants :
A différentes valeurs de charge électrique correspondent différentes actions sur le vin : un pouvoir clarifiant notoire quand la charge est élevée et un fort pouvoir “detanisant” quand elle est faible.
Si nous examinons les charges électriques des protéines végétales (ou phytoprotéines) nous pouvons observer qu’elles sont comparables à celles des clarifiants traditionnels : l’utilisation de protéines végétales a donc un effet sur la clarification comparable à celle des dérivés des oeufs, du lait et des gélatines d’origine animale, donc efficace sur les blancs et les rouges.
Suite à l’entrée en vigueur de la directive communautaire ((UE) n°579/2012), les vins étiquetés depuis le 1er Juin 2009 doivent reporter sur l’étiquette la présence de dérivés de blé, d’oeuf et de lait, ingrédients considérés comme potentiellement allergènes. La recherche de nouveaux clarifiants, permettant d’offrir aux vignerons une alternative valable aux produits traditionnels
à base de caséinate et ovalbumine, nous a amené à réfléchir à des formulations à base de matières premières d’origine végétale et levuriennes, respectivement introduites en oenologie par les monographies OIV 28/2004 et 452-2012.
Cette nécessité est née suite à l’apparition de la “maladie de la vache folle” ou ESB, à la fin des années 90. Cet évènement a marqué l’abandon immédiat des sources protéiques dérivées des bovins, substituées par le porc et ensuite par les protéines végétales, qui deviennent de plus en plus importantes notamment par rapport à des habitudes d’alimentation particulières (végétarien et végétalien).
Trois sources de protéines végétales sont aujourd’hui autorisées : le blé, le pois et, depuis décembre 2013, la pomme de terre. Du fait de la problématique allergène, les protéines de blé ne répondent pas aux attentes (gluten). En revanche, les protéines de pois constituent une bonne alternative à la PVPP pour la clarification des vins blancs et rosés.
Raisins Vin SO2 Clarification • Clarifiants Pressurage • Enzymes Moût • Enzymes et SO2 Débourbage et clarification • Clarifiants FML Bactéries Vin SO2 FA Levures Activateur Stabilisation • Stabilisants Filtration • Adjuvants de filtration Embouteillage • Gaz inerte
92 | PRODUITS DE COLLAGE PRODUITS DE COLLAGE
Gamme Natura
Polymères d’origine végétale, minérale ou biologique - non allergènes. Les produits de la gamme Natura sélectionnés par Vinextase® Oenologie sont issus de produits naturels et non allergènes. Ils peuvent, par exemple, réduire la charge microbienne des moûts et ainsi diminuer et/ou être une alternative au SO2 utilisé en vinification. Ils sont issus de matières végétales, biologiques, ou minérales et sont en adéquation avec les nouvelles exigences des consommateurs, les tendances alimentaires (végétariennes ou vegan) et les intolérances alimentaires.
La protéine de pois
NATURA PRO
Colle végétale
100% issue de protéine de pois pour le traitement préventif et curatif de l’oxydation des moûts.
Améliore la limpidité et diminue l’astringence Améliore la floculation et le tassement des bourbes.

Applications et doses
Lors du débourbage ou en début de FA Vins blancs 3 - 10 g/hl Vins rouges et moûts 5 - 20 g/hl
Les +
• Permet une diminution de la nuance jaune sur les vins rosés (évite les nuances orangées).
• Réduit le caractère végétal des vins.
• Produit de flottation non allergène.
Conditionnement(s)
500gr réf. 164526T5 15 kg réf. 16452615
NATURA PRO LIQUIDE
Colle végétale
100% issue de protéine de pois, formulation liquide, sélectionnée pour le collage des moûts et des vins.
Les +
• Permet une diminution de la nuance jaune sur les vins rosés (évite les nuances orangées).
• Réduit le caractère végétal des vins.
• Produit de flottation non allergène.
Applications et doses
Flottation des moûts blancs/rosés 100 - 200 ml/hl Moûts 50 - 200 ml/hl Vins blancs/rosés 20 - 100 ml/hl Vins rouges 50 - 200 ml/hl
Conditionnement(s)
22 kg réf. 18325522
AVEZ-VOUS PENSÉ À…
CUVE AGITATION (POUDRE ET LIQUIDE)
Bac mélangeur sur roues ou sur socle. Bac monté sur socle thermo formé avec passage pour transpalette, avec vidange totale 40 mâcon et vanne à boule, piquage pour mélangeur à 45° en 40 mâcon.
réf. 187555 - Cuve de 500 L réf. 187554 - Cuve de 300 L

Les +
• Permet une préparation rapide des produits solides (sucres, bentonites, colles) à ajouter au vin sans grumeaux.
• Stockage et manipulation plus aisée qu’avec une baste.
| 93 GAMME NATURA
La protéine de pomme de terre
Les préconisations de Vinextase® Oenologie :
Étude comparative de l’impact des différents produits de collage sur la couleur d’un jus de presse blanc et rouge
Vinextase® Oenologie a sélectionné
Natura Pat à partir d’une matière première spécifique, pour sa capacité à éliminer les polyphénols oxydables et son efficacité au niveau du compactage des produits.
Elle est efficace mais on doit l’utiliser à faible dose (<10g/hl) pour respecter les qualités organoleptiques.
sur la couleur
NATURA PAT
Colle végétale
100% issue de protéine de pomme de terre.
Les +
sur la couleur d’un vin rouge
sur la couleur d’un vin blanc
CONCLUSIONS DES OBSERVATIONS :
• Charbon : fort pouvoir décolorant mais efficace sur la couleur rouge - nuance jaune
• Natura Pat et Xtrem Gel Fine : bonne efficacité et bonne réponse par rapport à la nuance
• Protéine de Pois : résultat comparable à la caséine et la PVPP
• Natura bent : peu efficace
Étude comparative de l’impact des différents produits de collage sur la couleur d’un vin blanc oxydé
Natura Bent
Caséine
Charbon Protéine de pois
PVPP
Xtrem Gel fine
Natura Pat
0 20 40 60 80 100 Teneur en composés phénoliques oxydés
CONCLUSIONS DES OBSERVATIONS :
• Natura Pat, Xtrem gel Fine, Charbon : forte efficacité sur le jaune
• Protéine de Pois : réponse entre la PVPP et la Caséine
• Natura Bent : peu efficace sur le jaune
- Sur moûts : en flottation, collage plus précis et plus efficace que les gélatines : temps très court. Formation d’un floculat compact, élimination des composés phénoliques oxydés ou oxydables.
- Sur vins : présente une forte capacité de clarification et de sédimentation, elle stabilise la matière colorante et élimine sélectivement les tanins astringents.

• Sa réactivité permet des clarifications rapides et efficaces sur vins et moûts.
• Élimination sélective des polyphénols oxydables sur les vins blancs.
• Sur les vins rouges, amélioration de la limpidité et de l’astringence tannique sans modification de l’équilibre polyphénolique.
Conditionnement(s)Applications et doses
kg réf. 18325401
kg réf. 183254S3
1
12,5
Moûts 3 - 20 g/hl Vins 1 - 10 g/hl Impact sur la couleur d’un vin blanc oxydé Natura Pat Xtrem Gel fine PVPP Charbon Protéine de pois Caséine Natura Bent 0 20 40 60 80 100 Impact
Impact
Impact
94 | PRODUITS DE COLLAGE GAMME NATURA
Les bentonites sodiques activées
NATURA BENT P
Bentonite poudre sodique activée. Collage des vins blancs et rosés pour éliminer les protéines et les stabiliser. Elle permet l’élimination de la matière colorante instable.
Applications et doses
Dose 30 - 100 g/hl
Déterminer la dose avec un test protéique, incorporer la bentonite poudre lentement en maintenant une agitation dans 10 fois son poids d’eau. Laisser gonfler 1 heure pour obtenir un gel homogène.
Les +
• Fort pouvoir déprotéinisant.
Les préconisations de Vinextase® Oenologie :
• LA BENTONITE
NATURA BENT G
Bentonite granulée sodique activée. Collage des vins blancs et rosés pour éliminer les protéines et le stabiliser. Elle permet l’élimination de la matière colorante instable.
Applications et doses
Dose 30 - 100 g/hl
Déterminer la dose avec un test protéique, incorporer dans 20 fois son poids d’eau.
Laisser gonfler 45 minutes pour obtenir un gel crémeux, mélanger vigoureusement et incorporer au cours d’un remontage.
AVEZ-VOUS PENSÉ À…
Conditionnement(s)
• Son « activation » facile d’utilisation et ses propriétés d’adsorption. 1 kg réf. 16360401 25 kg réf. 16360425
La bentonite est une colle minérale, un silicate d’aluminium hydraté, essentiellement de la montmorillonite, structuré en feuillet. C’est cette structure particulière qui permet à cette dernière de gonfler, chargée négativement qui fixera les protéines du vin chargées positivement.
NATURA BENT ACTIVE +
Les +
• Fort pouvoir déprotéinisant.
• Son « activation » facile d’utilisation et ses propriétés d’adsorption. 1 kg réf. 16326601 25 kg réf. 16326625
Conditionnement(s)
Bentonite sodique activée issue d’un procédé innovant : durant la phase de granulation la montmorillonite est absorbée par un gel de silice spécifique. Ainsi cette bentonite a une forte capacité de déprotéinisation et est naturellement clarifiante.
Applications et doses
Moûts ou vins jeunes 20 - 60 g/hl, Vins rouges ou blancs 5 - 80 g/hl, selon l’objectif choisi (clarification ou déprotéinisation)
Les +
• Le gel de silice associé à sa formulation favorise le compactage rapide.
• Facile à mettre en œuvre : bonne dissolution dans l’eau.
TURBIDIMÈTRE PORTATIF
HAUTE PERFORMANCE HI98703
Robuste et compact, le turbidimètre HI98703 est l’outil idéal pour des mesures simples, efficaces et confortables en toute mobilité.

La conception électronique et optique issue de technologies de dernière génération assure une exactitude de mesure de +2 % avec une excellente sensibilité et une remarquable reproductibilité. HI98703 est équipé en outre d’un dispositif de gestion traçabilité appelé FastTracker™. Par l’enregistrement des mesures, il supprime tout relevé manuel et évite des erreurs de report. réf. 129666
• Elle respecte la couleur du vin. 1 kg réf. 18097801 20 kg réf. 18097820
Conditionnement(s)
Les +
• La mesure de la turbidité des vins blancs et rouges.
• Le contrôle de la stabilité protéique pour une évaluation exacte du dosage de bentonite des vins blancs.
| 95 GAMME NATURA
La Bentonite Naturelle
NATURELLE BENT G
Bentonite granulée sodique naturelle.

Les +
Applications et doses
Clarification des moûts 15 - 30 g/hl
Clarif. vins rouges et blancs 5 - 30 g/hl
Conditionnement(s)
• Forte action déprotéinisante. 5 kg réf. 18098105
Les dérivés de Chitine pour la flottation
CLARITOSAN
Colle d’origine fongique (issu d’Aspergillus niger) spécifique pour la flottation des moûts. Elle peut être utilisée en collage de vin. Grace à sa charge électrique superficielle élevée (1 meq/g), elle a un fort pouvoir de floculation.
Applications et doses
Clarification des moûts à travers la flottation 4 - 20 g/hl Doses plus élevées sur moûts dérivés de raisins rouges et produits difficiles à clarifier.

Les +
• La flottation est plus rapide qu’avec une colle traditionnelle.
CLARITOSAN PRO

Claritosan Pro est une formulation liquide à base de chitosane (origine fongique : Aspergillus niger) et de protéines de pois (origine végétale).
Les +
• Formulation liquide.
• Élimination des notes astringentes et un meilleur équilibre en bouche.
Conditionnement(s)
• Les indices de filtrabilité sont améliorés : le vin est plus limpide. 1 kg réf. 18097601 10 kg réf. 18097610
Applications et doses
Clarification rapide des moûts de flottation et issus de thermovinification : 100 à 200 ml/hl sur moût
Dose maximale légale autorisée : 500 ml/hl
Aux doses préconisées, il n’y a pas d’instabilité protéique. Solution prête à l’emploi.
• Améliore la couleur et élimine les notes d’oxydations par une diminution significative des absorbances à 420 nm et 440 nm.
POMPE DE FLOTTATION
EASY-FLOT 100
Les pompes de flottation discontinue EASYFLOT sont équipées d’une pompe péristaltique permettant une injection régulière des adjuvants de floculation (claritosan, protéine de pois, gélatine).
réf. 181274
Conditionnement(s)
Bidon de 22kg réf. 19119922
Son efficacité et sa rapidité d’action lui permettent de flotter tous types de moûts tout en préservant les qualités organoleptiques du produit initial. Les comparaisons analytiques entre le « Claritosan », une solution de gélatine d’origine porcine et une solution de protéines de pois ont donné comme résultat une persistance aromatique plus importante et une diminution de l’astringence et du côté végétal. Claritosan permet de préserver toutes les qualités organoleptiques des moûts et ainsi des vins qui en sont issus.
AVEZ-VOUS PENSÉ À…
96 | PRODUITS DE COLLAGE GAMME NATURA
La protéine issue de la levure
SPRING’FINER™ (E2U)
1er agent de collage d’origine levurienne. Concentration de protéines issues de la levure, présentant des propriétés de collage remarquables.
Les +
• Collage sans allergène et respectueux des vins.
Élimination spécifique des tanins astringents et amers pour un meilleur profil organoleptique.
• Lies fines et compactes pour des pertes limitées de vin.
Applications et doses
Vins blancs et rosés 1 - 5 g/hl


Vins rouges 5 - 15 g/hl
Conditionnement(s)
Les préconisations de Vinextase® Œnologie :
• Soucieux de s’adapter aux nouvelles exigences sur la sécurité des utilisateurs et consommateurs, notamment sur la présence d’allergènes dans les produits œnologiques, Fermentis a mis au point un procédé industriel unique afin de permettre l’extraction et la préservation des protéines natives d’une souche de levure Saccharomyces Cerevisiae spécialement sélectionnée et dont les propriétés de collage sont remarquables.
• Exclusivement d’origine levurienne, l’extrait protéique de levures Spring’Finer est exempt d’allergènes et peut être considéré comme le seul agent de collage totalement intégré dans l’élaboration des vins.

•
125 g réf. 180625TP
27 7 66 31 14 Distribution du Poids Moléculaire EPL M (kDa) Extrait classique M (kDa) Gélatine M (kDa) Profils d’électrophorèse SDS PAGE Protéines spécifiques de hauts poids moléculaires Turbidité finale (NTU) Cabernet Sauvignon 2014 0 5 10 15 20 25 30 35 Témoin Spring’Finer 10g/hl Albumine 5g/hl Gélatine 6cL/hL Sensibilité à l’oxydation (%) Cabernet Sauvignon 2014 3 2 1 0 -1 -2 -3 -4 -5 Spring’Finer 10g/hl Albumine 5g/hl Gélatine 6cL/hL Témoin Spring’Finer 10g/hl Albumine 5g/hl Gélatine 6cL/hL Brillance Cabernet Sauvignon 2014 30,0 30,5 31,0 31,5 32,0 32,5 • Action clarifiante • Réduction de la sensibilité à l’oxydation Diminution de l’intensité tannique pour un meilleur équilibre et une augmentation de la sucrosité. 0,00 0,50 1,00 1,50 2,00 2,50 3,00 3,50 Perception en bouche Panel professionnel (12 dégustateurs) Acidité Volume/rondeur Astringence Amertume Intensité tannique Qualité aromatique Persistance aromatique Equilibre Sucrosité Brûlant Spring’Finer 10g/hl Albumine 5g/hl Gélatine 6cL/hL Témoin | 97 GAMME NATURA
Les produits de collage traditionnels
CASÉINE SOLUBLE
Clarifiant pour vins blancs et rosés.
PRODUITS DE COLLAGE
Applications et doses
Moûts 50 - 100 g/hl
Vins 20 - 50 g/hl
Les + Cette protéine de charge positive est capable de floculer dans le vin, adoucissant les composés polyphénoliques tels les flavanols, du type catéchines et proanthocyanidines, responsables du brunissement et de l’oxydation des vins.
Conditionnement(s)
1 kg réf. 16461601 20 kg réf. 16461620
ALBUMINE D’OEUF
Produit en poudre spécifique du collage des vins rouges de garde. Les protéines du vin, colloïdes, hydrophiles positifs donnent, avec les tanins des micelles négatives qui, en présence de cations métalliques vont perdre leurs charges : la colle

Applications et doses
Vin > à 20°C 5 - 10 g/hl
Vin < à 20°C 10 - 15 g/hl
Les + Collage des vins rouges de garde.
positive se combine au complexe négatif « tanin-fer » et l’ensemble flocule mutuellement.
Conditionnement(s)
1 kg réf. 16327001
COLLE DE POISSON
Préparation de collagène issue de vessie natatoire de poisson, indiquée pour le traitement des vins blancs.
Applications et doses
Vins 1 - 3 g/hl
FLOTTAGEL
Solution de gélatines spécifiques particulièrement adaptée à la technique de clarification des moûts par flottation.
Applications et doses
Moûts 40 - 100 ml/hl
Les + Donne de l’éclat et renforce la couleur des vins blancs. 100 g réf. 163278T1
Conditionnement(s)
Les + Amélioration des indices de filtrabilité en flottation. 22 kg réf. 16326822
Conditionnement(s)
98 | PRODUITS DE COLLAGE
TRADITIONNELS
XTREM GEL FINE
Xtrem gel fine est une gélatine liquide purifiée peu hydrolysée, obtenue à partir de collagènes. Clarification des vins rouges de garde structurés riches en couleur et tanins.
Les +
• Sa formulation liquide facilite son utilisation.
• Son faible degré d’hydrolyse n’entraîne pas de sur-collage.
• Elle gomme les notes astringentes.
• Elle est recommandée pour son excellente action clarifiante en adjuvant de flottation pour les vins blancs et les vins rosés.
Applications et doses
Moûts - Vins 30 - 80 ml/hl
Conditionnement(s)
5 kg réf. 17432605 22 kg réf. 17432622
XTREM GEL FORTE
Solution de gélatines destinée à la clarification des vins rouges jeunes et déséquilibrés, des vins rosés et blancs très chargés. Recommandée pour les vins de presse difficiles à clarifier.
Applications et doses
Vins blancs et rosés 10 - 25 ml/hl
Vins rouges 20 - 60 ml/hl TRIO CLAR
Association de PVPP, bentonite sodique et charbon végétal.
Les +
Stabilisation colloïdale et action clarifiante puissante pour vins de presses et vins jeunes instables.
XTREM GEL MEDIUM
Xtrem gel medium est une gélatine liquide, purifiée, moyennement hydrolysée obtenue à partir de collagènes. Elle donne de la rondeur et de la souplesse aux vins aromatiques et jeunes.
Les +
• Sa formulation liquide facilite son utilisation.
• Son faible degré d’hydrolyse n’entraîne pas de sur-collage.
• Elle élimine les notes végétales et astringente sans altérer le profil aromatique.
Applications et doses
Trio Clar s’utilise pendant la fermentation des vins rosés. Dose moyenne 50 - 70 g/hl
Conditionnement(s)
5 kg réf. 17432405
22 kg réf. 17432422
Applications et doses
Moûts - Vins 30 - 80 ml/hl
Conditionnement(s)
5 kg réf. 17432505 22 kg réf. 17432522
GEL DE SILICE
Solution colloïdale de silice à 300g/l améliorant la sédimentation des produits traités lors du collage à la gélatine. Utilisé aussi dans le cadre de la flottation.
Applications et doses
Moûts 10 - 20 ml/hl
Vins 30 - 100 ml/hl
Les +
• Améliore le compactage des lies, la clarification et la sédimentation.
• Permet aussi la formation rapide des flocules dans le processus de flottation.
Conditionnement(s)
5 kg réf. 16324205 25 kg réf. 16324225
Les +
• Corrige et prévient le brunissement des moûts blancs et rosés.
• Limite les risques de casse protéique.
• Donne des vins rosés aux tonalités plus claires.
Conditionnement(s)
1 kg réf. 16327101 25 kg réf. 16327125
Les préconisations de Vinextase® Œnologie : Besoins d’échantillons pour faire vos essais ? N’hésitez pas à consulter votre référent Vinextase® Oenologie.
| 99 PRODUITS DE COLLAGE TRADITIONNELS

TANINS ET DÉRIVÉS DU BOIS
| 101 Notre collection de tanins et dérivés du bois est issue de matières premières rigoureusement sélectionnées. Nous savons l’impact de ces solutions sur le profil des vins, il nous apparait indispensable de fournir des produits efficaces et avec une mise en œuvre facilitant leur utilisation. 102 | Tanins sur moûts 103 | Tanins d’élevage 105 | Protection des barriques et des foudres 106 | Dérivés du bois - éclats de chêne chauffés / non chauffés 108 | Dérivés du bois - Inserts 109 | Dérivés du bois - Staves
AMONT DE LA VINIFICATION
TANINS & DÉRIVÉS DU BOIS
PRODUITS DE COLLAGE
FERM. MALO.
FERM. ALCOOL.
BIO-PROTECT. DES MOÛTS
ENZYMES
PRODUITS SULFUREUX
PROTECTION CORRECTION VENDANGES
CORRECT. ET STAB. DES VINS FILTRATION DES VINS HYGIÈNE
Tanins
Les composés polyphénoliques jouent un rôle important dans les caractéristiques organoleptiques des vins. Un équilibre parfait donne une amélioration de l’expression aromatique et de la structure des vins. Les tanins oenologiques se répartissent en deux catégories :
•Tanins condensés ou proanthocyanidiques qui offrent d’excellentes protections antioxydantes et de stabilisation de la couleur, augmentant de surcroît la structure et le corps des vins grâce aux propriétés importantes de polymérisation.
•Tanins hydrolysables ou acides phénoliques, spécifiques, pour obtenir une protection antioxydante exceptionnelle ou des clarifications sans risque de surcollage. Dans un milieu comme le vin (milieu acide) ils s’hydrolysent facilement en apportant des acides phénoliques comme l’acide gallique, di-gallique (ou tanique) et/ou l’acide ellagique en fonction de l’espèce botanique d’où provient l’extrait. Ils possèdent d’excellentes propriétés de protection antioxydante des vins et facilitent les clarifications difficiles de par leur forte attraction envers les protéines.
Moûts
TANEX GALA
Extrait de tanins galliques spécifiques pour la vinification des moûts de blancs et rosés. Effet inhibiteur de la laccase et de la tyrosinase. Participe à la précipitation des protéines instables et présente un effet antioxydant complémentaire au SO2
Les +
• Fort pouvoir antioxydant.
• Sur vendanges altérées, limite les déviations dues au botrytis.
• Permet de limiter le SO2 en cas de conditions réductrices du moût.
• Co-adjuvant pour la clarification.
• Peut être utilisé lors de la prise de mousse sur effervescent pour la clarification.
Applications et doses
Sur moûts 2 -10 g/hl
Sur vendanges altérées 10 -20 g/hl
Clarification 5 -10 g/hl
Effervescent 5 -10 g/hl
Conditionnement(s)
1 kg réf. 16323901
TANEX PÉPIN
Tanin condensé issu de pépins de raisin. Apport lors de la fermentation et du décuvage où il accentue les arômes du vin et marque les caractéristiques variétales.
Les +
• Forte réactivité et combinaison avec les anthocyanes du raisin.
• Augmente le potentiel phénolique du vin.
• Apport de structure.
• Tanins endogènes au vin issus de la revalorisation de co-produits de vinification.
Applications et doses
Rosés/blancs 10 -20g/hL
Rouges 10 – 40 g/hL

Une dose haute est conseillée pour un apport de structure et une bonne stabilisation de la couleur
Conditionnement(s)
1 kg réf. 18031001
AGRICULTURE
BIOLOGIQUE Utilisable en
AGRICULTURE BIOLOGIQUE
Utilisable en 102 | TANINS ET DÉRIVÉS DU BOIS TANINS
TANEX PRO
Tanins condensés issus de Quebracho spécifique de la fermentation alcoolique.
Les +
• Protection en cas de vendanges altérées (inhibition de la laccase). Stabilisation de la couleur et des polyphénols.
Applications et doses
Moûts et vins 10 - 40 g/hl
Conditionnement(s)
1 kg réf. 14081501 25 kg réf. 14081525
Polyphénols totaux et intensité colorante d’un vin témoin et d’un vin élaboré avec Tanex Pro
Elevage
TANEX ANTI-OX
Association de tanins oenologiques tous conformes au Codex. Nos méthodologies d’extraction et de concentration garantissent la qualité naturelle et la stabilité du produit, sans aucun agent de conservation ou additif. Les tanins oenologiques Tanex anti-OX peuvent naturellement être utilisés pour la clarification des moûts ou des vins.

Applications et doses
Anti-Ox Blanc 30 -50ml/hL Anti-Ox Rouge 30 -50ml/hL
Les +
• Action antioxydante avec une réduction partielle ou totale de l’utilisation du soufre.
• Préservation des qualités olfactives et gustatives de raisins de qualité.
Conditionnement(s)
1L (blanc) réf. 19307201
1L (rouge) réf. 19307301
AGRICULTURE BIOLOGIQUE Utilisable en conformément au règlement CE 834/2007 IPT IC 0 25 50 75 100 Tanex Pro Témoin
AGRICULTURE BIOLOGIQUE Utilisable en Temps (heures) Niveau de protection 6 0% Anti-OX 100 ppm Anti-OX 250 ppm Anti-OX 500 ppm SO2 25% 50% 75% 100% 12 18 24 30 36 Schéma de la protection oxydative Intensité coloranteIPT | 103 TANINS
ET DÉRIVÉS DU BOIS
TANEX VX
Les extraits oenologiques de chêne Tanex Vx sont des concentrés polyphénoliques produits à partir de duramen de chêne français ou de chêne américain. Le bois de qualité tonnellerie est maturé naturellement sur parc.
Nos méthodologies d’extraction et de concentration garantissent naturellement la stabilité du produit, sans aucun agent de conservation ou additif. Le procédé d’extraction à basse température induit une complexité sans égale combinée à un faible niveau d’astringence et d’amertume. Les composants présents naturellement dans le chêne sont extraits de façon douce et ses qualités originelles sont ainsi respectées.
Notre gamme se compose de cinq extraits dont les caractéristiques répondent aux besoins des différents stades de vinification ou d’élevage. Nous proposons des tanins spécifiques répondant aux divers besoins de la vinification et de l’élevage de vos vins.
TANEX VX 10 VOLUME
Apport de fraîcheur en attaque et de structure en milieu de bouche.
Conditionnement(s)
1L réf. 18905401
TANEX VX 13 RONDEUR
Apport de volume en milieu de bouche.
Conditionnement(s)
1L réf. 18905601
35ml (shot barrique) réf. 18580135
TANEX VX 22 INTENSE
À base de chêne américain, apport de rondeur et sucrosité en milieu de bouche.
Conditionnement(s)
1L réf. 18905801
35ml (shot barrique) réf. 18580335
Les +
• Préservation des vins traités vis à vis des phénomènes oxydatifs.
• Stabilisation durable de la couleur.
• Accentue l’expression des qualités organoleptiques et hédoniques originelles.
Applications et doses
Vins rouges et blancs liquoreux
En fermentation alcoolique 10 - 50 ml/hl
En fermentation malolactique 10 - 50 ml/hl
En élevage 10 - 50 ml/hl
Vins blancs secs et rosés moitié du dosage des vins rouges
TANEX VX 12 FRUIT
Accentue l’intensité aromatique intrinsèque au vin.
Conditionnement(s)
1L réf. 18905501
TANEX VX 14 ELÉGANCE
Révélation de l’élégance des vins.
Conditionnement(s)
1L réf. 18905701
35ml (shot barrique) réf. 18580235
Les préconisations de Vinextase® Œnologie :
Un kit facilitant vos essais sur vin est à disposition auprès de votre technico-commercial référent
Ce kit permet de tester facilement les tanins, de déterminer les doses idéales et les assemblages possibles. Faites la demande de ce kit ou d’un test auprès de votre contact technique Vinextase® Oenologie.

AGRICULTURE BIOLOGIQUE Utilisable en conformément au règlement CE 834/2007
AGRICULTURE BIOLOGIQUE Utilisable en
AGRICULTURE BIOLOGIQUE Utilisable en
AGRICULTURE BIOLOGIQUE Utilisable en conformément au règlement CE 834/2007
AGRICULTURE BIOLOGIQUE Utilisable en
AGRICULTURE
BIOLOGIQUE Utilisable en
104 | TANINS
TANINS
Protection des barriques et foudres

TANEX BARREL
Tanex Barrel est une solution de tanins à pulvériser dans une barrique en vidange après nettoyage afin d’assurer une protection du bois et d’éviter toute déviation à la réutilisation.
Les +
• Action de protection contre les dérives organoleptique de la barrique en phase de stockage.
• Préservation des qualités olfactives et gustatives de votre barrique.
• Réduit l’utilisation du soufre ou/et de l’ozone.
Applications et doses
Barrique en vidange : 35 ml en spray
Sur barrique saine, sans cloque, échaudée à la vapeur, chaude/tiède. Pression eau comprimé : 5 bars
Durée de la pulvérisation : 7 secondes (Équivalent dosage 35 ml par barrique)
Conditionnement(s)
NOUS CONSULTER
Les préconisations de Vinextase® Œnologie :
TANEX BARREL® est composé d’une association de tanins œnologiques qui sont tous conformes au Codex Œnologique. Le blend de poudres est ensuite mis en solution d’eau osmosée afin de faciliter la diffusion par pulvérisation dans la barrique.
Nos méthodologies d’extraction et de concentration garantissent naturellement la qualité et la stabilité du produit, sans aucun agent de conservation ou additif.
PISTOLET DE PULVÉRISATION
Un compresseur avec régulateur de pression. L’outil doit être nettoyé à l’eau claire, puis séché après chaque campagne d’utilisation.
Réduction ou élimination de l’utilisation du soufre (dépend de l’état sanitaire initial de la barrique). Facile d’utilisation (spray)


| 105 TANINS
BOIS
DÉRIVÉS
Dérivés du bois
Nous nous employons à sélectionner pour vous les meilleurs chênes de qualité tonnellerie des forêts françaises et nord-américaines.
Les bois sont maturés naturellement sur parc en Allier, Alsace ou dans le Cognac pendant 24 mois minimum pour le chêne français et 12 mois minimum pour le chêne américain. Nous allions tradition et innovation en développant un process de chauffe précis et fiable. Cette technique tient compte des paramètres intrinsèques du bois et garantit la répétabilité de la chauffe.

Travailler vos vins sur nos produits hautement qualitatifs vous permet d’élargir leur potentiel aromatique et de vieillissement.
Nous pouvons ainsi vous proposer des produits homogènes et de qualité constante. L’échange d’oxygène entre le bois et le vin est lent et mesuré. Les vins tanniques s’assouplissent, le fruit s’exalte. Les fermentations malolactiques sur nos bois offrent aux vins une touche de complexité, renforcent leur caractère et leur terroir.
Eclats de chêne non chauffés
NUANCE FRAÎCHEUR
Chêne qualité merrain maturé sur parc pendant 18 à 24 mois. Broyé lentement et garanti sans chauffe de déshydratation, préservant ainsi tous les composés aromatiques, sans hydrolyser les tanins.
Applications et doses
En fermentation
Blancs et rosés 0,25 - 1,5 g/l Rouges 1 à 6 g/kilo de vendange
Profil organoleptique
Apporte des notes de vanille fraîche et de coco, augmente la structure en bouche.
Conditionnement(s)
Filet de 10 kg réf. 18405610 Sac vrac 10 kg réf. 18404810 Big-Bag de 400 kg réf. 184048BQ
Eclats de chêne chauffés
NUANCE ÉPICÉE
Applications et doses
Sur vendange ou moût 0,5 g/l - 5 g/l
Sur vin fini en élevage 2 à 6 g/l pendant minimum 1 mois
Profil organoleptique
Notes de pain d’épice, cannelle, girofle et vanille.
Augmente la complexité et longueur en bouche.
Conditionnement(s)
Filet de 10 kg réf. 18404610
Big-Bag de 300 kg réf. 184046B3
Les +
• Apport de gras, de rondeur et de sucrosité.
• Augmentation de l’expression des notes fruitées, réduction des notes herbacées.
• Stabilisation de la couleur dans les vins rouges, soutien des notes violacées.
NOUVEAUTÉ
NUANCE FRUITÉE
Applications et doses
Sur vendange ou moût 0,5 g/l - 5 g/l
Sur vin fini en élevage 2 à 6 g/l pendant minimum 1 mois
Profil organoleptique
Apporte des notes de vanille et de coco. Augmente la sucrosité en bouche et exhauste le fruité du vin.
Conditionnement(s)
Filet infusion de 10kg réf. 19219910
Big Bag de 300kg Nous consulter
106 | TANINS ET DÉRIVÉS DU BOIS
DU
Chêne qualité merrain, maturé sur parc pendant 18 à 24 mois, broyé lentement puis chauffé dans des fours de haute technologie assurant une haute répétabilité des profils aromatiques.
Les +
• En vinification, en association avec Vinextase® Nuance Fraîcheur, les éclats de chêne chauffés augmentent la complexité aromatique des vins.

• En élevage, Vinextase® Nuance Vanillée, Épicée et Torréfiée apportent gras, rondeur et complexité en bouche, avec quelques notes boisées.
NUANCE TORRÉFIÉE
Applications et doses
Sur vendange ou moût 0,5 g/l - 5 g/l
Sur vin fini en élevage 2 à 6 g/l pendant minimum 1 mois
NUANCE VANILLÉE
Applications et doses
Sur vendange ou moût 0,5 g/l - 5 g/l
Sur vin fini en élevage 2 à 6 g/l pendant minimum 1 mois
Profil organoleptique
Notes empyreumatiques, grillées, moka.
Conditionnement(s)
Filet infusion de 10kg Réf. 18404710
Big Bag de 300kg Réf. 184047B3
Profil organoleptique
Apporte des notes de vanille et de coco.
Augmente le gras, la rondeur et sucrosité en bouche.
Conditionnement(s)
Filet infusion de 10kg Réf. 18404510
Big Bag de 300kg Réf. 184045B3
Une gamme boisée plébiscitée pour sa praticité, ses propriétés et qualités aromatiques & organoleptiques
Les morceaux de bois sont des outils de vinification et d’élevage, aujourd’hui largement utilisés par les producteurs.

Utilisés tout d’abord comme alternatifs à la barrique de chêne, ils trouvent à présent de nombreuses applications :
• Apport structurant pour une vendange manquant de concentration ;
• Effet sucrant pour enrober des tanins agressifs ;
• Apport aromatique pour tempérer l’expression végétale d’une maturité inaboutie ;
• Exhausteur du fruit Tampon oxydo-réducteur pour les vins blancs et rosés ;
• Gestion spécifique des vins de presse ;
• Reprofilage de vins manquant d’équilibre de bouche ;
• Apports aromatiques boisés de vins élevés en cuve ‘’Boost’’ aromatique pour élevage en barriques usagées.
La gamme boisée Vinextase® est particulièrement intéressante pour atteindre ces différents objectifs. Elle a donné entière satisfaction dans notre panel annuel comparatif (50 échantillons testés), où ont été remarqués l’élégance aromatique, la finesse des tanins et le bon pouvoir sucrant des gammes Fraîcheur et Expression.
Coutras (33) - Pascal Hénot - OEnologue consultant, Membre du Conseil Scientifique Vinextase®, Directeur EnoSens
| 107 DÉRIVÉS DU BOIS
BOIS
DÉRIVÉS
Inserts
La facilité d’utilisation des Inserts Vinextase® vous permet de prolonger la vie de vos barriques en bon état sanitaire. La gamme Expression vous assure une exceptionnelle puissance et complexité aromatique.
Les +
• Les inserts Vinextase® Expression sont destinés à être mis dans des fûts, à partir du deuxième vin, afin de compenser la baisse d’apport aromatique.
• Ils assurent une diffusion harmonieuse du boisé dans le vin.

• Les inserts Vinextase® Expression sont disponibles en Expression fruitée, vanillée et épicée.

EXPRESSION FRUITÉE
Applications et doses
1 kit par barrique
EXPRESSION VANILLÉE
Applications et doses
1 kit par barrique
EXPRESSION EPICÉE
Applications et doses
1 kit par barrique
Profil organoleptique
Intensifie l’expression fruitée des vins et apporte des notes de coco, et de vanille.
Apporte structure et complexité.
Augmente la sucrosité des vins.
Conditionnement(s)
24 Kits par carton réf. 184057
Profil organoleptique
Augmente la sucrosité, la rondeur et la structure du vin.
Apporte des arômes de vanille, caramel, moka, pain grillé et des notes légèrement épicées.
Maîtrise l’astringence et apporte de la complexité.
Conditionnement(s)
24 Kits par carton réf. 184058
Profil organoleptique
Apporte élégance, volume et complexité au vin.
Notes d’épices, de fumé, de pain grillé, caramel et moka.
Préserve les qualités du cépage et réduit les notes herbacées.
Conditionnement(s)
24 Kits par carton réf. 184059
108 | TANINS ET DÉRIVÉS DU BOIS
DU
Staves
EXPRESSION FRUITÉE
Profil organoleptique
Intensifie l’expression fruitée des vins et apporte des notes de coco et de vanille. Apporte structure et complexité. Augmente la sucrosité des vins.
Conditionnement(s)
Stave 7 mm : paquet de 20 staves réf. 18405220
Stave 18 mm : paquet de 8 staves réf. 18404908
EXPRESSION VANILLÉE
Profil organoleptique
Augmente la sucrosité, la rondeur et la structure du vin.

Apporte des arômes de vanille, caramel, moka, pain grillé et des notes légèrement épicées.
Maîtrise l’astringence et apporte de la complexité.
Conditionnement(s)
Stave 7 mm : paquet de 20 staves réf. 18405320
Stave 18 mm : paquet de 8 staves réf. 18405008
Chêne de qualité merrain maturé sur parc pendant 24 à 36 mois assurant l’exceptionnelle puissance et complexité de la gamme Expression. Spécifiques d’un long élevage en cuve, elle permet d’obtenir un boisé avec des notes aromatiques fondues et intégrées. Elles apportent structure et complexité aux vins.
Les +
• Les staves Vinextase® Expression augmentent considérablement la complexité aromatique des vins de façon proche d’un élevage sous bois.
EXPRESSION EPICÉE
Profil organoleptique
Apporte élégance, volume et complexité au vin. Notes d’épices, de fumé, de pain grillé, caramel et moka. Préserve les qualités du cépage et réduit les notes herbacées.
Conditionnement(s)
Stave 7 mm : paquet de 20 staves réf. 18405420
Stave 18 mm : paquet de 8 staves réf. 18405108
Durée de l’élevage Dimensions Application et dose Stave 7 mm 2-6 mois 7 x 47 x 950 mm 2-3 staves par hl Stave 18 mm 9-14 mois 18 x 47 x 950 mm 1-2,5 staves par hl. | 109 DÉRIVÉS DU BOIS
Staves et complexité des vins


LES BÉNÉFICES DE L’ÉPAISSEUR
Les échanges entre le bois et le vin se réalisent lentement, au cœur de la stave. Le phénomène de nano-oxygénation permis par l’oxygène emprisonné dans le bois augmente la complexité intrinsèque de vos vins.
Plus la stave est épaisse, plus l’échange est lent et important entre le vin et le bois et plus vous vous rapprocherez d’un résultat barrique.
Vous pouvez comme cela travailler la complexité de la bouche, du nez, renforcer le volume et le gras de votre vin.
LE TEMPS APPORTE LA COMPLEXITÉ
Une grande épaisseur des bois intégrés dans le vin permet des échanges lents entre le chêne et le vin, jusqu’au cœur de la stave.
Une stave plus épaisse (18mm) permet d’augmenter le temps de contact avec le vin, améliorant sa complexité, sa finesse et son élégance.
AVEZ-VOUS PENSÉ À…
LIENS INOX POUR IMMERSION DES STAVES
Regroupe un lot de staves et permet de meilleurs échanges du fait de l’immersion totale au fond de la cuve et facilite la micro-oxygénation. 2 boucles, longueur 95 cm, conditionné par 10 liens.
NOUS CONSULTER
Stave 18 mm (2 st/hl) Stave 7 mm (3 st/hl) 3 mois Complexité 6 mois 12 mois 3 mois Vanillé 6 mois 12 mois 3 mois Whisky-Lactone 6 mois 12 mois 110 | TANINS ET DÉRIVÉS DU BOIS DÉRIVÉS DU BOIS
CORRECTION ET STABILISATION DES VINS
| 111 Pour certains vins, le marché n’autorise plus la présence de dépôts au fond de la bouteille. La préparation des vins à la mise en bouteille doit être raisonnée pour éviter : - les colmatages de filtres ; - les risques de précipitations tartriques, et les dépôts de matière colorante, les casses ; - la dissolution de l’oxygène ; - la contamination en Brettanomyces sp. ; - etc. Vinextase® Oenologie propose une gamme de produits de stabilisation et correcteurs des moûts et des vins répondant à ces exigences. 112 | Stabilisation / précipitations tartriques 113 | Stabilisation de la couleur : gommes arabiques 114 | Correction des oxydations de la couleur 116 | Traitement des déviations organoleptiques
AMONT DE LA VINIFICATION
TANINS & DÉRIVÉS DU BOIS
PRODUITS DE COLLAGE
FERM. MALO.
FERM. ALCOOL.
BIO-PROTECT. DES MOÛTS
ENZYMES
PRODUITS SULFUREUX
PROTECTION CORRECTION VENDANGES
CORRECT. ET STAB. DES VINS FILTRATION DES VINS HYGIÈNE
Stabilisation / précipitations tartriques
ACIDE METATARTRIQUE
Inhibiteur de la formation de cristaux de tartre. Indice d’estérification 38/40%.
Applications et doses
Précautions à prendre :
Avant la mise en bouteille ou la filtration finale. Ne pas utiliser après un traitement au lysosym qui fait précipiter l’acide métatatrtrique.
Eviter de traiter à des températures inférieures à 10°C.
Dose : 5 à 10 g / hl
Dose max légale : 10g / hl
BITARTRATE DE POTASSIUM
Crème de tartre qui favorise la cristallisation des sels de l’acide tartrique lors du traitement par le froidrosé/blanc.
Applications et doses
Stabilisation par «semi-contact» 7 à 10 jours : 20 - 40 g/hl Stabilisation par «contact» 4 - 6 heures : 4 g/l Stabilisation «en continu» : 2 - 5 g/l
Les +
• L’indice d’estérification de 38/40 permet une protection maximale.
• Vins jeunes consommés dans l’année.
Conditionnement(s)
1 kg réf. 19550401
SOLUSTAB 100
CMC-carboxymethylcellulose hautement purifiée permettant la stabilisation tartrique de façon irréversible.
Les +
• Solustab 100 est très concentré ce qui permet de rajouter très peu d’eau au vin et d’avoir un traitement le plus neutre possible au niveau organoleptique.
• Sa viscosité facilite sa solubilisation dans le vin.
Applications et doses
Dose : 5 à 10 cl / hl sur Blanc et rosé pale
Dose max légale : 10 cl /hl
Sur vin rouge et rosé coloré il est conseillé de faire au préalable un test de stabilité de la matière colorante.

• Se filtre très bien et est très peu colmatant.
Conditionnement(s)
1 kg réf. 16452601
5 kg réf. 16707905
15 kg réf. 16452615
22 kg réf. 16707922
Les +
• Le bitartrate de potassium ou crème de tartre, favorise la cristallisation des sels d’acide tartrique lors du traitement par le froid.
Conditionnement(s)
25 kg réf. 16461725
MANNO LIQUIDE
Les mannoprotéines ont un effet partiel sur la stabilisation tartrique du vin par rapport aux précipitations colloïdales. Elles sont micro-filtrables.
Les +
• Amélioration de la sensation de souplesse et de rondeur en bouche.
• Harmonisation du profil aromatique : enrobe les points rugueux des tanins.
Applications et doses
Vins blancs : 1 - 5 g/hl
Vins rouges : 3 - 10 g/hl
Conditionnement(s)
1 kg réf. 18325301
AGRICULTURE
BIOLOGIQUE Utilisable en
AGRICULTURE BIOLOGIQUE Utilisable en conformément au règlement CE 834/2007
AGRICULTURE BIOLOGIQUE Utilisable en conformément au règlement CE 834/2007
AGRICULTURE BIOLOGIQUE Utilisable en conformément au règlement CE 834/2007 112 | CORRECTION ET STABILISATION DES VINS STABILISATION / PRÉCIPITATIONS TARTRIQUES
Stabilisation de la couleur : gommes arabiques
VEREK COLOR
Gomme arabique issue de l’Acacia sénégal (Acacia verek). Sa nature hydrophile préserve la limpidité du vin, évitant les dépôts colloïdaux : elle favorise la stabilité de la matière colorante, protégeant le vin des chutes cupriques, ferriques et/ou protéiques.


Applications et doses
Lors du débourbage ou en début de FA Vins blancs 3 - 10 g/hl Vins rouges et moûts 5 - 20 g/hl
Les +
• Protège les vins des casses métalliques et protéiques.
VEREK STAB’COLOR
Gomme arabique en solution à 30%, sélectionnée pour stabiliser la matière colorante et apporter de la rondeur et du volume en bouche.
Conditionnement(s)
5 kg réf. 16327205 22 kg réf. 16327222
Applications et doses
Vins : 70 et 200 ml/hl
Les +
• Protège la matière colorante en s’adaptant aux traitements simultanés avec la CMC.
• Augmente les sensations de corps et de douceur en bouche tout en respectant les caractéristiques aromatiques du vin.
Conditionnement(s)
5 kg réf. 18326105 22 kg réf. 18326122
SAVERGOM
Savergom confère volume et rondeur aux vins traités. Elle aide également à la stabilisation colloïdale des vins. Savergom est préparée à partir d’une sélection de gommes arabiques de haute qualité, libres de toute impureté et filtrées postérieurement. Elle a un faible indice de colmatage.
Applications et doses
Vins : 8 - 20 cl/hl
Les +
• Apporte rondeur et souplesse.
• Diminue les sensations de verdeur, des notes végétales.
SAVERGOM A
Association de gommes arabiques et de mannoprotéines issus de la levure, elle stabilise la matière colorante tout en attenuant l’astringence des vins avant la mise en bouteille. Elle a un faible indice de colmatage.
Applications et doses
Vins : 100 - 300 ml/hl
Conditionnement(s)
• Garantit une réduction de l’astringence et de la sécheresse en bouche. 5 kg réf. 16981605 22 kg réf. 16981622
Les +
• Atténue et module l’astringence tannique.
• Contribue à la stabilité cristalline et colloïdale des vins.
Conditionnement(s)
5 kg réf. 18326205 21 kg réf. 18326221
AGRICULTURE BIOLOGIQUE Utilisable en conformément au règlement CE 834/2007
AGRICULTURE BIOLOGIQUE Utilisable en conformément au règlement CE 834/2007
AGRICULTURE
BIOLOGIQUE Utilisable en conformément au règlement CE 834/2007
AGRICULTURE
BIOLOGIQUE Utilisable en conformément au règlement CE 834/2007
Acacias Seyal du Sénégal produisant la gomme arabique SAVERGOM
Produit alternatif non-exogène : voir Springcell color G2, page 57
| 113 STABILISATION DE LA COULEUR
Correction des oxydations et de la couleur
La Polyvinylpolypyrrolidone est capable d’éliminer de manière sélective les composés phénoliques produits par le brunissement des moûts et des vins. Elle ne modifie pas le profil organoleptique du vin, puisque les vins traités avec la PVPP obtiennent plus de fraîcheur au détriment des notes oxydées. Elle agit face aux catéchines et aux leucoanthocyanes évitant l’évolution vers des tons oxydés en diminuant la fraction combinée du SO2 La PVPP rectifie la teinte jaune et peut réduire l’astringence des vins rouges jeunes.
PVPP GRANULEE
Action stabilisante et prévention des phénomènes oxydatifs des moûts et des vins.
Les +
• Produit très concentré : permet de réduire les doses / à la poudre.
• Facile à dissoudre dans de l’eau (pas de grumeau) et rapide à mettre en œuvre.
Applications et doses
Moûts blanc et rosé oxydé : diminuer les doses de 30 à 50% par rapport à la poudre selon l’instabilité du moût Vin blanc et rosé : 2– 15g/hl

Dose max légale : 80 g/hl
PVPP PELLETS
Action stabilisante et prévention des phénomènes oxydatifs des moûts et des vins.
Les +
• Même efficacité que la poudre.
• Non volatile : sécuritaire pour l’utilisateur. 500 g réf. 180983T5 20 kg réf. 18098320
Applications et doses
Conditionnement(s)
Conditionnement(s)
• A un impact très positif sur la nuance des vins traités en préventif sur moût ou en curatif sur vin : la tenue générale de la couleur du vin final est améliorée dans le temps.
• Ingrédient 100% actif : absence d’additif liant et d’eau dans le process de granulation.
• Facile à dissoudre dans de l’eau (pas de grumeau) et rapide à mettre en œuvre.
• Non volatile : sécuritaire pour l’utilisateur.
comparative de l’effet de la PVPP Pellets Vinextase® par rapport à la formulation poudre et à d’autres formulations granulées du marché Essai de collage : Rosé CDR grenache syrah - Dioenos Rhone - Orange Avril
Temps de contact :
Dose d’utilisation : 50g/hl
AGRICULTURE BIOLOGIQUE
Utilisable en
AGRICULTURE
BIOLOGIQUE Utilisable en Réduction de la teneur en catéchines Conditions d’essai : Muscat - Dose d’utilisation = 15 g/hl Réduction du % de catéchines sur Muscat Témoin 0 50 100 150 PVPP Pellets 15g/hl DO420 Témoin PVPP Pellets 15g/hl 0,145 0,15 0,16 0,17 0,18 0,155 0,165 0,175 CORRECTION DES OXYDATIONS ET DE LA COULEUR 10 kg réf. 19525410
Moûts blancs et rosés oxydés : 10 -40g/hl Vin blanc et rosé : 5 – 20g/hl Dose max légale : 80 g/hl 1 2 3 4 5 RÉSULTATS : La PVPP Pellets a été jugée plus brillante que les autres échantillons, active dès 1 heure de contact. Sa teinte après traitement est comparable au vin traité avec la formulation poudre. 1 - témoin 2 - PVPP poudre Vinextase 3 - PVPP granulée A 4- PVPP pellets Vinextase 5 - PVPP granulée B Etude
2019
7 heures
114 | CORRECTION ET STABILISATION DES VINS
CHARBON ALPHA GRANULE
D’origine végétale, il a un très fort pouvoir de décoloration : il est activé chimiquement à l’acide phosphorique, ce qui lui confère un très haut pouvoir adsorbant. Il est adapté au détachage des moûts et des vins blancs.
Applications et doses
Sur moût ou vin peu oxydé (brun pâle) : 10 à 50 g/hl
Sur moût ou vin oxydé : > 50g/hl
Temps de contact : sur moût 24h et sur vin 48h
Dose maximale légale autorisée : 100g/l
Il est conseillé d’ajuster la teneur en SO2 libre avant utilisation du charbon, et de traiter sur moût en même temps que l’enzymage
Les +
• Le Charbon Alpha Vinextase® n’affecte pas les qualités organoleptiques des vins. • Sa formulation granulée sécurise les manipulations du produit et améliore les temps de traitement et de sédimentation du produit.

Conditionnement(s)
15 kg réf. 19139815
DECOLOR PLUS
Charbon végétal en poudre, il est utilisé pour la décoloration des moûts et des vins tachés.
Les +
Pouvoir détachant (en %)
CHARBON HUMIDIFIE
Applications et doses
Vins légèrement bruns et orangés : 3 - 10 g/hl
Vins nettement tuilés ou bruns : 10 - 15 g/hl
Vins fortement oxydés : > à 15 g/hl
Élimination de la couleur dans le moût et dans le vin. 17,5 kg réf. 163292SB
Conditionnement(s)
L’humidité présente facilite sa manipulation en réduisant les risques sanitaires. Utilisation directe sans préparation préalable. Fort pouvoir décolorant. Charbon actif obtenu à partir du bois de pin maritime activé avec l’acide phosphorique et humidifié.
Applications et doses
Doses variables jusqu’à 154 g/hl correspondants à 100 g/hl de produit sec.
Les +
• L’eau qui imbibe le charbon évite la présence de l’air, réduisant les phénomènes d’oxydation. 15 kg réf. 18097915
Le Charbon Alpha granulé : une action confirmée !
Conditionnement(s)
Nous avons comparé l’efficacité du Charbon Alpha Granulé sur un moût de grenache/syrah 2018, par rapport à 2 autres charbons granulés du commerce, à 2 doses différentes (20 et 50 g/hl) et avec une répétition pour chaque modalité.
Ces essais ont montré que le Charbon Alpha granulé avait un pouvoir décolorant supérieur aux 2 autres charbons, mis en évidence par l’augmentation de l’angle de teinte, et par une baisse de l’intensité colorante et de la saturation, de façon significative à la dose de 50 g/hl.
Loic d’Achon - Œnologue Conseil chez DIOENOS RHONE (Orange-84)
AGRICULTURE BIOLOGIQUE Utilisable en Réduction de la couleur Témoin Alpha Gr 20g Alpha Gr 50g Charbon B 20g Charbon B 50g Charbon C 20g Charbon C 50g 0 0,5 1,5 3 2,5 1 2
Témoin Alpha Gr 20g Alpha Gr 50g Charbon B 20g Charbon B 50g Charbon C 20g Charbon C 50g 0 0,5 1 2 3 1,5 2,5 3,5
CORRECTION DES OXYDATIONS ET DE LA COULEUR
AGRICULTURE BIOLOGIQUE Utilisable en
AGRICULTURE BIOLOGIQUE Utilisable en
| 115
Traitement des déviations organoleptiques
CHARBON BETA
Charbon végétal qui présente une surface d’adsorption spécifique. C’est un produit très pur, activé à la vapeur et avec une faible présence de métaux. Grâce à ses caractéristiques spécifiques et à sa porosité, il est capable d’adsorber pigments et molécules de petites dimensions de manière sélective.
Son activité permet l’élimination partielle des phénols volatils des vins.
GEO’S TOP
Les charbons sont des produits œnologiques soumis à autorisation : se conformer à la législation en vigueur dans votre région viticole.
Applications et doses
Dose / Application : Moûts ou vins : 5 - 50 g/hl
Les +
• Bon pouvoir décolorant.
• Spécifiquement réactif vers les composés phénolés.
NOREDUX
Produit complexe formulé à base de citrate de cuivre et de Bentonite pour éliminer les mauvais goûts et les odeurs dues à l’hydrogène sulfureux (H2S) ou à des composés à fonction sulfure (SH).
Applications et doses
Doses variables selon nécessité jusqu’à 100 g/hl
Conditionnement(s)
1 kg réf. 18098201 20 kg réf. 18098220
Les +
Applications et doses
5 à 15g/hl
Dans le cas des vins blancs et rosés, procéder par ajouts successifs en vérifiant entre chaque ajout et après 12 heures :
· l’impact organoleptique
· la teneur résiduelle en cuivre
MICROSAN
Polysaccharide naturel d’origine fongique, issu d’Aspergillus niger, non allergène, non animal et non OGM qui permet de réduire la charge microbienne des vins.
Les +
• Diminue efficacement les populations de levures et de bactéries lactiques
Conditionnement(s)
Traitement des déviations organoleptiques : goûts moisis et terreux (présence de géosmine et d’octènone). 17,5 kg réf. 163293SB
Applications et doses
4 à 10 g/hl sur vin fini après FA ou FML selon l’effet désiré
• Préserve les qualités aromatiques des vins en éliminant les défauts organoleptiques
Conditionnement(s)
100g réf.194358T1
Les +
AGRICULTURE BIOLOGIQUE
• La formulation du produit en association avec la bentonite permet une diminution de la teneur en cuivre dans le vin après traitement, une partie de celui-ci étant retenu dans le réseau de bentonite et éliminé après soutirage ou filtration.

• Noredux évite les goûts métalliques que peuvent donner les produits formulés à base de sulfate de cuivre en cas de dose élevée.
Conditionnement(s)
1 kg réf. 18325601
NOREDUX MANNO
Préparation de citrate de cuivre et d’écorces de levures riches en mannoprotéines. Rapide élimination des défauts de réduction dans les vins : sulfhydriques et dérivés, oeuf putréfié, légume cuit, gomme brûlée, etc. Son contenu en mannoprotéines solubles non liées à des polysaccharides a une action rapide sur la sensation de volume en bouche.
Applications et doses
Vins finis : 5 - 15 g/hl
Les +
• Atténue les éventuels déséquilibres.
Conditionnement(s)
g réf. 183257T5
500
AGRICULTURE BIOLOGIQUE
Utilisable en
AGRICULTURE BIOLOGIQUE
Utilisable en
Utilisable en
CORRECTION DES OXYDATIONS ET DE LA COULEUR 116 | CORRECTION ET STABILISATION DES VINS
AGENTS FILTRANTS
| 117 La filtration est une étape clé pour la stabilité dans le temps du vin, Vinextase® Oenologie vous propose une collection d’agents filtrants répondant aux différents besoins en filtration. 119 | Terres de filtration 120 | Capsules de filtration 121 | Plaques de filtration 122 | Cartouches et membranes de filtration Amazonfilters
AMONT DE LA VINIFICATION
TANINS & DÉRIVÉS DU BOIS
PRODUITS DE COLLAGE
FERM. MALO.
FERM. ALCOOL.
BIO-PROTECT. DES MOÛTS
ENZYMES
PRODUITS SULFUREUX
PROTECTION CORRECTION VENDANGES
CORRECT. ET STAB. DES VINS
FILTRATION DES VINS HYGIÈNE
AGENTS FILTRANTS
La filtration a beaucoup évolué en oenologie ces dernières décennies. Vinextase® Oenologie vous propose une gamme complète d’agents filtrants utilisés en tant qu’auxiliaires technologiques.
Les terres de filtration
• Les diatomées : diatomites ou kieselguhr qui sont issues de carrières de diatomées fossiles, lavées, broyées, calcinées et calibrées selon une granulométrie précise à l’origine de larges gammes de terres filtrantes (débit du filtre = perméabilité de 0,02 à 15 darcie).
Les terres de perméabilité lente (< 0,5 darcie) et par conséquent à fort pouvoir filtrant sont généralement roses.
• Les perlites : issues de roches volcaniques concassées, séchées, expansées et tamisées pour présenter des granulométries adaptées à différents usages oenologiques.
• Les capsules filtrantes : surface absorbante permettant une excellente élimination des colloïdes.
• Les plaques filtrantes et modules lenticulaires adaptés à la filtration en œnologie sont composés de fibres cellulosiques d’origine végétale, associées à des composés granuleux comme les diatomées ou les perlites.

• Les cartouches et membranes filtrantes sont polyvalentes : que vous souhaitiez traiter des petits batchs, préparer un vin brut à l’embouteillage, ou répondre à un cahier des charges préconisant une stérilité microbiologique, nous vous apportons des agents de filtration adaptés.
En complément, Vinextase® Matériel de Cave propose des filtres adaptés à nos agents (filtre à plaques, rotatifs, carter de filtration, et filtre tangentiel).
118 | AGENTS FILTRANTS
Terres de filtration
DIATOMÉES
Silice neutre de type sédimentaire, d’origine lacustre ou marine.
Diatomées
VINEXTASE CS 0
VINEXTASE CS 1
VINEXTASE CS 3
VINEXTASE CS 07
VINEXTASE CS 10
VINEXTASE CS 15
VINEXTASE CS 20
VINEXTASE CS 30
VINEXTASE CS 30
VINEXTASE CS 30
PERLITES
Agent
Perméabilité
Conditionnements
Références
De 0,025 à 0,050 Darcie Sac de 18 kg 13730318
De 0,090 à 0,16 Darcie Sac de 20 kg 13730420
De 0,16 à 0,30 Darcie Sac de 20 kg 13730520
De 0,05 à 0,10 Darcie Sac de 18 kg 13739318
De 0,90 à 1,30 Darcie Sac de 25 kg 13730625
De 0,80 à 1,80 Darcie Sac de 25 kg 13739225
De 1,4 à 2,6 Darcie Sac de 25 kg 13730725
De 2,4 à 4,0 Darcie Sac de 25 kg 13730225
De 2,4 à 4,0 Darcie Big-bag de 500 kg 137302B5
De 2,4 à 4,0 Darcie Big-bag de 650 kg 137302DJ
Perméabilité
Darcie Densité 90g/litre Sac de 14kg
à
225kg BB450kg
13730114 137301DK 137301BE
MF45 PREMIUM 4 Darcie Densité 105g/litre Sac de 13kg BB 290kg 19091513 190915X9

EXTRAFLOW 16
MF18 PREMIUM
1,4 à 1,8 Darcie Densité 130g/litre Sac de 16kg BB 270kg BB 500kg
13730016 137300DH 137300B5
1,45 à 1,75 Darcie Densité 120g/litre Sac de 16kg BB 325kg 19092116 190921V9
MF30 PREMIUM HD HAUTE DENSITÉ 2,5 à 4 Darcie Densité140g/litre Sac de 18kg BB 425kg 19092018 190920WI
MEDIAFLOW 50 3,8 à 4,8 Darcie Sac de 13kg 17432313
Spécificités gamme PREMIUM :
Avec la perlite MF30 PREMIUM Haute Densité, il est important de réduire le niveau de vide par rapport à l’utilisation de la diatomée (0,4 à 0,6 bar en moyenne selon la perméabilité du produit).

Les +
• La perlite de la gamme Vinextase® PREMIUM, utilisée sur filtre rotatif, permet de réduire le % d’agents filtrants, ce qui facilite l’encollage des filtres.
• La qualité MF 30 Vinextase® PREMIUM haute densité améliore le rendement des filtres et permet un allongement du cycle de filtration proche de celui que l’on peut obtenir avec une filtration sur diatomées.
• La gamme de Perlite Vinextase® PREMIUM offre un seuil de silice cristalline < 0,1 mg/litre, prévenant les risques écotoxicologiques lors de leur utilisation. De plus, ce seuil lui permet d’être apte au compostage dans le respect de la législation en vigueur.
AGRICULTURE BIOLOGIQUE Utilisable en
AGRICULTURE BIOLOGIQUE Utilisable en conformément au règlement CE 834/2007
filtrant à base de silice neutre d’origine volcanique. Filtration des moûts et des bourbes à l’aide de filtres à tambour rotatif ou filtres presses. Perlite
Densité non tassée Conditionnements Références MAXIFLOW 40 3,4
4,5
BB
| 119 TERRES DE FILTRATION
CAPSULES DE
Capsules de filtration
Les capsules filtrantes PREDEFLOW GF possèdent un média en microfibre de verre.
Elles sont régénérables à co-courant à l’eau froide ou l’eau tiède et sont spécialement conçues pour la préparation d’échantillons.
Elles se branchent directement au robinet dégustateur de la cuve ou à l’aide d’un adaptateur en raccord macon aux robinets de vidange de la cuve ou bien sous un réservoir de filtration de laboratoire.
Le poids du vin dans la cuve génère une pression suffisante pour la filtration (0,1 bar ou 1m de hauteur de liquide). Les seuils de filtration nominaux permettent une adéquation précise aux exigences de chaque application.
CARACTÉRISTIQUES TECHNIQUES
Matériaux de construction
Média : Microfibres de verre Support : Polypropylène: support, amont, embouts, aval, corps de capsule et noyau : 0,11 m²
Conditionnement(s)
Capsule PREDELFLOW GF100 (0,6 µm) pour les vins blancs et rosés réf. 131934
Capsule PREDELFLOW GF200 (1 µm) pour les vins rouges réf. 126010
Capsule PREDELFLOW GF300 (2 µm) pour les vins rouges réf. 126012
Les +
La capsule filtrante thermosoudée résiste remarquablement à la rupture et aux impacts. Sûr et d’emploi aisé, l’élément de filtration ne demande aucune manipulation. Une étiquette pratique permet d’inscrire la date d’installation et de renouvellement, ainsi que les initiales de l’utilisateur.
CARTOUCHES PREDELFLOW
Témoin non filtré (vin blanc en cours d’élevage)
Applications et doses
Conditions maximales d’utilisation
Dans le sens du débit (extérieur vers intérieur) : Liquide 5 bar à 40°C
Air/Gaz 4 bar à 40°C
• Stérilisation par autoclave

Les capsules PREDEFLOW GF peuvent passer à l’autoclave de manière répétitive : maximum 10 cycles de 30 minutes à 121°C.


• Sécurité biologique
Tous les matériaux utilisés sont conformes à la norme USP actuelle sur les plastiques de classe VI - 121°C et l’équivalence ISO10993.
Utilisation :

1/ Brancher la capsule à l’aide d’un tuyau à votre robinet dégustateur.
2/ Ouvrir le robinet dégustateur afin de commencer à filtrer le vin.
3/ Ouvrir la Purge 1 pour éliminer la bulle d’air puis refermer dès que le vin coule.
FILTRATION D’ÉCHANTILLON
Entrée Vin
Purge A
Purge B
Sortie Vin
Témoin filtré sur capsule GF100 (0,6 µm)
RÉGÉNÉRATION
Entrée Eau
Purge A
Purge B
Sortie Eau
Procédure de régénération de la capsule :
1/ Rincer le filtre à co-courant à l’eau froide jusqu’à ce que l’eau coule claire. Auparavant, ouvrir la Purge A pour éliminer la bulle d’air.
2/ Rincer le filtre à co-courant à l’eau tiède (40/50°C) pendant 10 à 15 minutes environ.
Conservation : Après toute utilisation, veillez à bien régénérer la capsule. Conserver alors la capsule dans une solution d’alcool dénaturé à 50% vol. ou solution sulfitée à 4%.
120 | AGENTS FILTRANTS
FILTRATION
Plaques de filtration
Pureté des celluloses et calibrage des kieselghürs nous ont permis de développer des plaques d’une qualité de rétention exceptionnelle et qui limitent au maximum les effets du relargage. Elles sont adaptées à toutes les étapes de la filtration : dégrossissantes, fines, pré-stériles ou stériles.
Conditionnement(s)
Désignation
Vinextase V2
Vinextase
Vinextase
Vinextase V7
Vinextase VS12
(g/m2) Épaisseur (mm)
(l/m2/h)
Les +
• Fabrication française de grande qualité : pureté des celluloses et calibrage des kieselguhrs.
Une gamme complète : dégrossissantes, clarifiantes, pré-stériles et stériles. 30 ans d’expérience en filtration



Vinextase VS15 1350 3,8
Vinextase VS30 1350 3,8
150-200
128486P2
2,5 128487P2
2,5 40 x 40 cm
formats
demande
150-200 0,5-0,8 1,2 183284P2
Vinextase VS40 1350 3,8 0,35 150-200 0,4-0,6 1,2 128491P2
Vinextase VS60 1370 3,8 0,36 100-200 0,2-0,4 1,2 128485P2
À PLAQUES
MODULES LENTICULAIRES
Le média filtrant des modules lenticulaires est de même nature que les plaques filtrantes. Il est constitué de «lentilles» superposées sur un tube central et sa dimension est adaptée au carter du filtre. Les modules lenticulaires sont régénérables. NOUS CONSULTER
Paquet de 25 plaques
Poids
Densité Vitesse filtration recommandée
Valeur de rétention (microns) ∆P admissible (bar) Formats Références
1000 3,8 0,26 500-700 8-18
autres
sur
V3 1200 3,8 0,32 500 7+15
V5 1250 3,8 0,33 500 5-12 1,5-2,5 128488P2
1300 3,8 0,34 350-500 3-7 1,5-2,5 128489P2
1350 3,8 0,35 350-500 1-3 1,5-2,5 128490P2
0,35
0,6-1,5 1,2 129654P2
0,35
AVEZ-VOUS PENSÉ À… FILTRE
40 X 40 30 plaques. réf. 135480 | 121 PLAQUES DE FILTRATION
Cartouches et Membranes de filtration Amazonfilters
L’utilisation de cartouches de filtration tubulaire permet :
• Une filtration propre et répétable
• Une filtration pour toutes les étapes : du dégrossissage jusqu’à la filtration prémise



Nous consulter Conditionnement(s)
Les +
• Nos cartouches Amazonfilters se composent également d’un média fibre de verre, permettant grâce à sa faible épaisseur, une surface plus importante de filtration, et des débits plus élevés.
• Elles ont une efficacité absolue (>99,98%) et nominale (> 99%).
• Composées de résines chargées positivement, elles sont très efficaces de par leur effet d’adsorption, et répondent aux problématiques de vins chargés en colloïdes.
• L’ensemble de la gamme répond aux exigences des principales normes européennes et américaines (FDA, IFS, BRC..), elles sont certifiées HALAL et KASHER et sont autorisées en BIO.
• Nous proposons un accompagnement technique sur le terrain.
• Délai d’approvisionnement : si non disponible sur stock, livraison en 4 semaines.
Les préconisations de Vinextase® Œnologie : Pour vos cartouches et membranes de filtration, choisissez vos types d’embouts :
AVEZ-VOUS PENSÉ À…
CARTER DE FILTRATION
réf. 126818
réf. 126819
1 cartouche
3 cartouches
122 | AGENTS FILTRANTS CARTOUCHES ET MEMBRANES DE FILTRATION
TYPE DESCRIPTION AVANTAGES UTILISATION
• débits élevés
SUPAPLEAT SUPAPORE PPG
SUPASPUN
SUPAGARD
• média polypropylène plissé ou média fibre de verre plissé
• rétention en surface
• média polypropylène Spun
• rétention en surface et en profondeur
• média polypropylène Spun
• rétention en surface et en profondeur
SUPAPORE VPW ET VPWS
• média polyéthersulfone plissé
• rétention en surface
• nettoyables
• disponible soit :
- filtration absolue (>99,98%)
- filtration nominale
• filtration absolue (>99,98%)
• de 0.3 à 180 µm

• densité variable pour une capacité de rétention maximale
• usage unique
• filtration nominale
• filtration économique
• excellents débits
• nettoyables, régénérables à contre-courant
• garantie de la stabilité microbiologique (levures et bactéries éliminées)
• test d’intégrité possible
• compatibles avec de nombreux modes de sanitisation (vapeur, eau chaude, agents chimiques)
• utilisées en préfiltration ou protection de membranes de filtration finale (également sur process eau de nettoyage et rinçage)
• utilisées en préfiltration sur application vinicoles ou sur process eau de process et de nettoyage
• utilisées en préfiltration sur application vinicoles ou sur process eau de process et de nettoyage

• filtration finale avant la mise en bouteilles
Filtration tangentielle
L’application actuellement la plus développée des filtres tangentiels est la préparation des vins au conditionnement. Par rapport à la filtration par alluvionnage, la microfiltration tangentielle permet en effet une simplification de la chaîne de traitement, en garantissant le respect de la qualité, tout en limitant la production de déchets.
Elle est également utilisée en filtration précoce des vins et comme procédé de stabilisation microbiologique, constituant dans ce cas une alternative à la flash-pasteurisation. De nouvelles configurations permettent la clarification de produits « chargés » en particules en suspension, comme les moûts, les bourbes et les fonds de cuve.
Le principe consiste à faire circuler le liquide à filtrer parallèlement à une membrane poreuse. Sous l’action de la pression, le liquide passe au travers de la membrane et se clarifie. Le flux tangentiel crée des turbulences qui limitent l’accumulation de particules à la surface de la membrane et retardent ainsi son colmatage.
AVEZ-VOUS PENSÉ À…
FILTRE TANGENTIEL
• Éléments de membrane PVDF à feuilles plates
• Débit système: 760-900 L / h Vin
• Pas de dissolution d’oxygène pendant la filtration
• Défaillance membranaire inexistante par rapport aux systèmes de fibre creux
• Conçu, testé et fabriqué aux États-Unis
• Pompe d’alimentation auto-amorçante
• Préfiltre en acier inoxydable - 200 microns
• Cadre monté sur roulettes
• Construction en acier inoxydable
NOUS CONSULTER
| 123
CARTOUCHES
ET
MEMBRANES
DE FILTRATION
INGÉNIERIE
SOURCING INSTALLATION S.A.V.

Nos solutions techniques clés en main
Les spécialistes Soufflet Vigne, véritables experts de la cave, proposent à leurs clients des solutions techniques clés en main, adaptées à leurs besoins de production. Soufflet Vigne est en mesure de procéder à l’installation du matériel et d’assurer un service après-vente de qualité sur l’ensemble du territoire national.
HYGIÈNE
126 | Homologation désinfectants sur micro-organismes du vin
| Plan d’hygiène sans chlore
| L’hygiène sans produits chimiques
| Décolmater en utilisant des solutions biologiques

| Plan d’hygiène chloré 142 | Produits d’hygiène
L’hygiène en œnologie se distingue de celle appliquée dans la plupart des industries agroalimentaires car le vin, du fait de sa composition (pH bas et teneur en alcool élevé), est un milieu hostile pour les germes pathogènes susceptibles de déclencher des toxi-infections alimentaires collectives comme les bactéries des genres Listeria sp. et Salmonella sp.
Vinextase® Œnologie a sélectionné pour vous différentes solutions pour l’hygiène de cave, en partenariat avec Diversey.
Pour ceux qui souhaitent utiliser des méthodes alternatives nous proposons aussi des méthodes et produits non chimiques. Nous commercialisons l’ensemble des équipements de protection individuelle et différents matériels d’application des produits, en version mobile ou fixe. Nous proposons des offres de services pour l’hygiène de caves avec nos solutions Vitivalor©
| 125
127
135
136
137
AMONT DE LA VINIFICATION
TANINS & DÉRIVÉS DU BOIS
PRODUITS DE COLLAGE
FERM. MALO.
FERM. ALCOOL.
BIO-PROTECT. DES MOÛTS
ENZYMES
PRODUITS SULFUREUX
PROTECTION CORRECTION VENDANGES CORRECT. ET STAB. DES VINS FILTRATION DES VINS HYGIÈNE
HYGIÈNE DE CAVE ET ŒNOLOGIE
Homologation désinfectants sur micro-organismes du vin
Le risque le plus important en oenologie, associé à un manque d’hygiène, concerne l’altération du produit et de ses qualités organoleptiques. Les micro-organismes d’altération du vin (Brettanomyces bruxelliensis, Acetobacter sp. et Gluconobacter sp., autres) sont présents tout au long du processus de vinification, de la récolte jusqu’à la mise en bouteille. Ils sont présents sur différentes surfaces, proliférant en cas de mauvaise hygiène.
Ainsi, le nettoyage permet d’éliminer les souillures adhérant à la surface. Il est réalisé par détergence, processus selon lequel ces souillures sont détachées de leur support et mises en solution ou en suspension.
La désinfection permet d’éliminer les micro-organismes d’altération du vin sur les supports au préalable nettoyés. Le résultat de cette opération est limité dans le temps. Une désinfection nécessitera toujours un nettoyage préalable s’il y a des souillures présentes.
Bactéricide
Homologation (ancienne ou nouvelle normes)
Homologué à 0,4% (5min, 20°C)
Homologué à 2% (5min, 20°C)
Homologué prêt à l’emploi (5min, 20°C)
Homologué à 0,05% (5min, 20°C)
Homologué à 5% (15 min à 20°C)
Homologué à 0,75% (5min, 20°C)
Homologué à 2% (5min, 20°C)
EN1276, 5min, 20°c 0,1% % 50% 0,02% 0,75% 1,5%
Fongicide (EN1650, 15 min, 20°C) 2% / 80% 1,5% 0,5% 3% Fongicide (EN1650, 15 min, 20°C) 0,35% 0,5% 50% 0,2% 1%
Acetobacter aceti (EN1276, 20 min, 20°C, saccharose)
Microorganismes d’altération du vin
Pediococcus parvius (EN1276, 20 min, 20°C, saccharose)
Brettanomyces bruxellensis (EN1650, 20 min, 20°C, saccharose
réalisé avec
réalisé avec
0,5% 0,5% 0,25% 0,5% (*) 1%
0,1% 1% 0,05% 0,1% (*) 1%
0,25% 0,5% 80% (**) 0,1% 0,1% (*) 1%
jus de raison + moût concentré rectifié en remplacement du saccharose.
avec albumine bovine en remplacement du saccharose.
 SANS CHLORE
AVEC CHLORE Divosan® Multiply Divosan® Omega HP
Divodes Etha plus Divosan® Trace Divosan® HS35 Deogen Divosan TC 86
SANS CHLORE
AVEC CHLORE Divosan® Multiply Divosan® Omega HP
Divodes Etha plus Divosan® Trace Divosan® HS35 Deogen Divosan TC 86
(*) Test
interférant
(**) Test
interférant
126 | HYGIÈNE
Plan d’hygiène sans chlore
Récolte -Vinification
Machines à vendanger, paniers, seaux, caisses, comportes, bennes, bacs, conquets de réception, vis, tapis, fouloirs, érafloirs, pressoirs pneumatiques, égouttoirs, extérieurs de cuves, foudres bois, remplisseuses, grilles, supports de plaques de filtres...
Nettoyage - Dérougissage Quotidien
Produit Fréquence Préparation (au dernier moment avant utilisation)
HD Plus foam+ Booster
Au moins une fois par jour
Enduro force Au moins une fois par jour
5% dans eau froide + Booster : 5% dans solution de HD Plusfoam
Application Temps de contact Rinçage
Par pulvérisation ou en mousse
20 à 40 min Jusqu’à disparition de la mousse (HD plusfoam légèrement moussant même en pulvérisation)
5% dans eau froide Mousse 20 à 30 min Jusqu’à disparition de la mousse
Rénovation de fin de vendanges (si opérations de nettoyage quotidiens)

Produit Fréquence Préparation (au dernier moment avant utilisation)
HD Plus foam+ Booster A la fin des vendanges ou des vinifications
Enduro force A la fin des vendanges ou des vinifications
5% dans eau froide + Booster : 5% dans solution de HD Plusfoam
Application Temps de contact Rinçage
Par pulvérisation ou en mousse
20 à 40 min Eventuellement au surpresseur jusqu’à disparition de la mousse
5% dans eau froide Mousse 20 à 30 min Jusqu'à disparition de la mousse
Une gamme large permettant des actions ciblées et efficaces à chaque étape du travail en cave
Depuis de nombreuses années, la sociéte Diversey a su adapter une gamme de produits d’hygiène spécifique au milieu viti-vinicole.
Grâce au pouvoir adhérant et pénétrant de la mousse, ce matériel est parfaitement adapté pour une hygiène absolue et plus particulièrement dans les endroits rebelles (matériel de récolte, matériel de réception à vendange, pressoirs, cuveries, extérieur de rinceuse et d’embouteilleuse, …).
La gamme proposée est très étendue et ciblée par rapport à l’action recherchée et à son efficacité dans toutes les étapes d’hygiène encadrant l’élaboration des vins (de la vendange à la mise en bouteilles), avec des protocoles bien adaptés avec et sans chlore.
Nous conseillerions l’utilisation des produits Diversey à un confrère, dans la mesure où il est prêt à vouloir adapter une hygiène précise, ciblée pour un matériel ou un circuit particulier.
Jean-Christophe Bourgeois - Responsable de cave, Domaine Henri Bourgeois (Chavignol-18)
| 127 PLAN D’HYGIÈNE SANS CHLORE
PLAN D’HYGIÈNE SANS CHLORE
Plan d’hygiène sans chlore
Cuves et Citernes
Inox, Polyester, Béton brut, Béton Verre, Céramique
Nettoyage - Dérougissage Quotidien
Produit Fréquence Préparation (au dernier moment avant utilisation)
Divosan Omega HP + Booster Après chaque utilisation 1 à 5% dans eau froide + Booster : 1 à 5% dans solution de Divosan Omega HP
Rénovation - Détartrage (tartre supérieur à 3 mm)
Produit Fréquence Préparation (au dernier moment avant utilisation)
Application Temps de contact Rinçage
En circuit fermé 10 à 20 min Jusqu'à test de rinçage négatif
Application Temps de contact Rinçage
Divoflow 50 Après chaque utilisation 5 à 20% en solution En circuit fermé 10 à 20 min Jusqu'à test de rinçage négatif
Divoflow 50 + Booster (si dérougissage nécessaire)
Après chaque utilisation 5 à 20 % dans eau froide + Booster : 1 à 5% dans solution de Divoflow 50
Rénovation - Détartrage (tartre supérieur à 7 mm)
Produit Fréquence Préparation (au dernier moment avant utilisation)
Breltak
Breltak + Booster (si dérougissage nécessaire)
Désinfection
Détartrage de cuve > 1 an 50 à 100g/L en solution
Détartrage de cuve > 1 an 5 à 20 % dans eau froide + Booster : 1 à 5% dans solution de Breltak
Produit Fréquence Préparation (au dernier moment avant utilisation)
Divosan Multiply Après chaque nettoyage 2% ou 20 g/L dans eau froide
Divosan HS 35 Après chaque nettoyage 5% ou 50 g/L dans eau froide
En circuit fermé 10 à 20 min Jusqu'à test de rinçage négatif
Application Temps de contact Rinçage
En circuit fermé 20 à 40 min Jusqu'à test de rinçage négatif
En circuit fermé 20 à 40 min Jusqu'à test de rinçage négatif
Application Temps de contact Rinçage
En circuit fermé 20 à 30 min Jusqu'à test de rinçage négatif bandelette peroxyde
En circuit fermé 20 à 30 min Jusqu'à test de rinçage négatif bandelette peroxyde
Elimination des calcaires et oxydes de fer (une fois par an) sur extérieur de cuves Inox UNIQUEMENT
Produit Fréquence Préparation (au dernier moment avant utilisation)
Application Temps de contact Rinçage
Pascal une fois par an 100g/L ou 10 % dans eau froide En pulvérisation ou mousse (avec ajout d'additif moussant ADD3 à 1%) mouiller le sol avant application pour éviter traces sur le sol
20 min Jusqu'à test de rinçage négatif
128 | HYGIÈNE
Cuves
Béton revêtues de Résine Epoxy
Nettoyage - Dérougissage Quotidien
Produit Fréquence Préparation (au dernier moment avant utilisation)
Divosan Omega HP + Booster Après chaque utilisation 1 à 5% dans eau froide + Booster : 1 à 5% dans solution de Divosan Omega HP
Détartrage (tartre supérieur à 1 mm)
Produit Fréquence Préparation (au dernier moment avant utilisation)
Application Temps de contact Rinçage
En circuit fermé 10 à 20 min Jusqu'à test de rinçage négatif
Application Temps de contact Rinçage
Divoflow 50 Après chaque utilisation 5 à 20% en solution En circuit fermé 20 à 40 min Jusqu'à test de rinçage négatif

Détartrage - Dérougissage Annnuel (tartre de 1 à 3 mm)
Produit Fréquence Préparation (au dernier moment avant utilisation)
Divoflow 50 + Booster (si dérougissage nécessaire)
Désinfection
Après chaque utilisation 5 à 20 % dans eau froide + Booster : 1 à 5% dans solution de Divoflow 50
Produit Fréquence Préparation (au dernier moment avant utilisation)
Divosan Multiply Après chaque nettoyage 2% ou 20 g/L dans eau froide
Application Temps de contact Rinçage
En circuit fermé 20 à 40 min Jusqu'à test de rinçage négatif
Application Temps de contact Rinçage
En circuit fermé 20 à 30 min Jusqu'à test de rinçage négatif bandelette peroxyde
Divosan HS 35 Après chaque nettoyage 5% ou 50 g/L dans eau froide En circuit fermé 20 à 30 min Jusqu'à test de rinçage négatif bandelette peroxyde
| 129
PLAN
D’HYGIÈNE SANS
CHLORE
PLAN D’HYGIÈNE SANS CHLORE
Plan d’hygiène sans chlore
Cuves
Acier revêtu
Détartrage
Produit Fréquence Préparation (au dernier moment avant utilisation)
Safeclean Annuel 10 à 100g/L dans eau froide ou à 50°C
Détartrage - Dérougissage
Produit Fréquence Préparation (au dernier moment avant utilisation)
Safeclean + Booster Après chaque utilisation 10 à 100g/L dans eau froide ou à 50°C + Booster : 1 à 5% dans solution de Safeclean
Application Temps de contact Rinçage
En circuit fermé 10 à 20 min Jusqu'à test de rinçage négatif
Application Temps de contact Rinçage
En circuit fermé 10 à 20 min Jusqu'à test de rinçage négatif
Foudres et Cuves en bois
Bois
Détartrage (tartre inférieur à 2 mm)
Produit Fréquence Préparation (au dernier moment avant utilisation)
Softsafe Avant Remplissage 10 à 30 g/L dans eau froide ou 50°C
Détartrage (tartre supérieur à 2 mm)
Produit Fréquence Préparation (au dernier moment avant utilisation)
Application Temps de contact Rinçage
En circuit fermé 10 à 20 min Rinçage abondant suivi immédiatement d'un application de Divosan Multiply
Application Temps de contact Rinçage
Breltak Avant Remplissage 10 à 100 g/L dans aau froide En circuit fermé 20 à 40 min Rinçage abondant suivi immédiatement d'un application de Divosan Multiply
Désinfection
Produit Fréquence Préparation (au dernier moment avant utilisation)
Divosan Multiply Après le détartrage 2 % ou 20 g/L
Application Temps de contact Rinçage
En circuit fermé 30 min Jusqu'à test de rinçage négatif
130 | HYGIÈNE
POUR VOS TESTS DE RINÇAGE

AVEZ-VOUS PENSÉ À… PAPIER PH
En rouleau de 5m. réf. 12040005
BANDELETTES PEROXYDE
Mesure de la teneur en peroxyde d’hydrogène : contrôle de la présence de désinfectant. réf. 114724

BANDELETTES PH 0-14 P100 réf. 189537p6
TESTEUR DE PH GONDO
Idéal pour mesurer le pH de l’eau à moindre coût. Compact et étanche, ce testeur mesure et affiche simultanément la valeur pH et la température. Le testeur est fourni en malette avec solution tampon pH4 - pH7. Plage de mesure : pH : 0 à 14 Température : 0 à 90°C Précision : +/-0,05 réf. 164331



| 131 PLAN D’HYGIÈNE
SANS CHLORE
PLAN D’HYGIÈNE SANS
Plan d’hygiène sans chlore
Futailles
Pièces, Barriques

Détartrage (tartre inférieur à 2 mm)
Produit Fréquence Préparation (au dernier moment avant utilisation)
Application Temps de contact Rinçage
Softsafe Avant Remplissage 10 à 30 g/L dans eau froide ou 50°C Par trempage bonde de côté 30 minutes à 2 jours
Détartrage (tartre supérieur à 2 mm)
Produit Fréquence Préparation (au dernier moment avant utilisation)
Rinçage abondant suivi immédiatement d'une application de Divosan Multiply
Application Temps de contact Rinçage
Breltak Avant Remplissage 5 g/L dans eau froide Par trempage bonde de côté 30 minutes à 2 jours
Désinfection
Produit Fréquence Préparation (au dernier moment avant utilisation)
Rinçage abondant suivi immédiatement d'une application de Divosan Multiply
Application Temps de contact Rinçage
Divosan Multiply Après le détartrage 2 % ou 20 g/L En circuit fermé 30 minutes Jusqu'à test de rinçage négatif
132 | HYGIÈNE
CHLORE
Divers
Tuyauterie, circuits, Manches, Intérieur de Remplisseuses, Filtres à alluvionement, Filtres à tambour rotatif, Pompes, Centrifugeuses, Installation de traitements thermiques,…
Détartrage - Dérougissage après utilisation
Produit Fréquence Préparation (au dernier moment avant utilisation)
Divoflow 50 + Booster Après chaque utilisation 5 à 20 % dans eau froide + Booster : 1 à 5% dans solution de Divoflow 50
Désinfection et Protection entre deux utilisations
Produit Fréquence Préparation (au dernier moment avant utilisation)
Application Temps de contact Rinçage
En circuit fermé 10 à 20 minutes Jusqu'à test de rinçage négatif
Application Temps de contact Rinçage
Divosan Omega HP Après détartrage dérougissage 1% dans eau froide Par trempage Permanent jusqu'à la prochaine utilisation
Nettoyage et Désinfection Externe des rinceuses et Remplisseuses
Produit Fréquence Préparation (au dernier moment avant utilisation)
Surefoam Quotidien 3%

Désinfection
Produit Fréquence Préparation (au dernier moment avant utilisation)
Jusqu'à test de rinçage négatif
Application Temps de contact Rinçage
Par pulvérisation ou en mousse 15 minutes Jusqu'à disparition de la mousse
Application Temps de contact Rinçage
Divosan Multiply Quotidien 2% ou 20 g/L dans eau froide En circuit fermé 20 à 30 minutes Jusqu'à test de rinçage négatif bandelette peroxyde
Divosan HS 35 Quotidien 5% ou 50 g/L dans eau froide En circuit fermé 20 à 30 minutes Jusqu'à test de rinçage négatif bandelette peroxyde Divosan Etha-Plus Quotidien Pur Par pulvérisation 15 minutes Homologué sans rinçage
AVEZ-VOUS PENSÉ À…
STATION VOYAGER
Nettoyage et désinfection de cuves, murs, sols et tuyauterie. Station mobile permettant un rinçage à une pression de 10 bars à 30 L/minute ou 20 bars à 40L/minute, l’application d’un détergent sous forme de mousse produit selon la méthode sans chlore. Large gamme d’accessoires et d’options disponibles.
DISPONIBLE À LA LOCATION
Les +
Utilisable avec les produits Diversey :
Booster ;
Aciclean ;
Pascal ;
Divosan Omega.
•
•
•
•
| 133 PLAN D’HYGIÈNE SANS CHLORE
PLAN D’HYGIÈNE SANS CHLORE
Plan d’hygiène sans chlore
Installation de filtration : Après accord du fabricant
Filtre Tangentiel
Nettoyage - Dérougissage - Décolmatage
Produit
Fréquence Préparation (au dernier moment avant utilisation)
Divos 123 Après prélavage à l'eau froide 2% dans eau à température ambiante + Booster : 1% dans solution de Divos 123 ajouté 15 min après
Divos 35 Après passage du mélange précédent
Nettoyage - Décolmatage
Produit
1 à 2% dans eau à température ambiante
Fréquence Préparation (au dernier moment avant utilisation)
Divos 123 Après prélavage à l'eau froide 0,5% à 2% de 20 à 50°C
Désinfection - Dérougissage
Produit
Fréquence Préparation (au dernier moment avant utilisation)
Divosan Multiply Après prélavage ou après décolmatage
0,2 à 0,5% à 20°C
Application Temps de contact Rinçage
En circuit fermé 10 à 20 minutes Jusqu'à test de rinçage négatif
En circuit fermé 10 à 20 minutes Jusqu'à test de rinçage négatif
Application Temps de contact Rinçage
En circuit fermé 10 à 20 minutes Jusqu'à test de rinçage négatif
Application Temps de contact Rinçage
En circuit fermé 20 à 40 minutes Jusqu'à test de rinçage négatif
En cas de colmatage difficile, utiliser Divos ADD3 en additif à la solution de Divos 123 à 0,2%
Surfaces diverses
Plafonds, Murs, Sols, extérieurs de cuves
Nettoyage - Décolmatage
Produit
Fréquence Préparation (au dernier moment avant utilisation)
HD Plusfoam + Booster Au moins une fois par jour 5% dans eau froide + Booster : 5% dans solution de HD Plusfoam
Traitement Fongicide préventif
Produit
Fréquence Préparation (au dernier moment avant utilisation)
Delladet toutes les 4 semaines 1 à 3 % dans eau froide
Application Temps de contact Rinçage
Par pulvérisation ou en mousse 20 à 40 minutes Jusqu'à test de rinçage négatif
Application Temps de contact Rinçage
Par pulvérisation ou en mousse 20 à 40 minutes Ne pas rincer
134 | HYGIÈNE
Sans
Détartrez et désinfectez vos cuves inox jusqu’à 100 hl


aussi
Les avantages
Grande facilité d’emploi
Plus de risque corrosif pour l’utilisateur
Pas de pollution atmosphérique de la cave
Consommation en eau d’environ 50 L/heure

Vapeur d’eau à env. 110°C en sortie
Détartrage très facile
Structure en acier inoxydable


Surpression maxi : 2.5 bar

Les +
• Disponibilité de la vapeur 2 minutes après la mise en service
• Détartrage à partir de 74°c et désinfection à 78°c, après un palier de 15/20 minutes
• Pas de produit chimique, uniquement de l’eau
• Sécurité de l’opérateur, la machine s’arrête toute seule en cas de défauts (eau, surpression, entartrage)
CARACTÉRISTIQUES TECHNIQUES
GEBHARDT TD 16 PUISSANCE 16,5 kw VOLUME DE VAPEUR 25 kg/h FUSIBLE 25 A LONGUEUR 750mm LARGEUR 310mm HAUTEUR 750mm


Protège
la chaleur
mains lors
chaudes
produits chimiques AVEZ-VOUS PENSÉ À… GANTS SCORPIO NEOPRENE 45CM 8 Gants spécifiques aux travaux avec
et vapeur.
les
de contacts intermittents avec des surfaces
jusqu’à 180°C. Taille 8 - réf. 19414108 Taille 10 - réf. 19414110 Modèles disponibles Quantité de vapeur disponible en kg/h Détartrage et désinfection cuve inox uniquement en hL Désinfection des becs de tireuses Détartrage & désinfection des barriques Références TD 13 20 60 à 80 9 2 180880 TD 16 25 80 à 100 12 2 183216 TD 23 35 120 à 150 16 3 180365 TD 33 50 150 à 200 24 4 184123 Avant détartrage Résultat finalTraitement vapeur
•
•
•
•
•
•
•
•
Utilisable
sur vos fûts et foudres
Tableau de commande de l’appareil Pour en savoir plus, consultez la vidéo de démonstration à partir du QR-code :
| 135
HYGIÈNE
SANS PRODUITS CHIMIQUES
EN UTILISANT DES SOLUTIONS BIOLOGIQUES
Utilisation de produits biologiques
EXTASYM CLEAN
Extasym Clean est une formulation d’enzymes non OGM d’Aspergillus niger très riche en activités secondaires de type cellulases et hémicellulases.

La FMS (fermentation en milieu solide)
EXTASYM Clean est issue de la FMS qui offre un spectre plus large d’activités secondaires en lien avec la structure plus complexe des milieux de fermentation qui suit le principe des 3S (Souche de fermentation –Système de fermentation – Substrat)
Ce procédé naturel est moins énergivore que la fermentation en milieu liquide permettant notamment une consommation d’eau moindre dans le process.
Applications et doses
Après 7 années d’études de test en collaboration avec un fabricant de filtre tangentiel pour bourbes, pendant la période des vendanges. Soufflet Biotechnologies (producteur français d’enzymes) a mis au point une préparation enzymatique permettant le décolmatage rapide des membranes céramiques.
· Permet la dissolution des polysaccharides colmatants
· Permet une réduction de la consommation de produits chimiques, · Diminue la consommation d’eau pendant le décolmatage
Ajouter Extasym Clean à 0.2 kg/100 Litres d’eau (dosage à ajuster en fonction du colmatage des membranes).
Dans un premier temps, ajuster le pH de l’eau entre 4 et 5 avec de l’acide citrique, le volume dépendant du volume mort du filtre. L’activité de ces enzymes est maximale autour de pH 4 et 5, et le produit plus efficace. Après vidange du filtre et rinçage à l’eau, faire circuler la solution enzymatique en circuit fermé, et maintenir la température à 40-45°C. Les enzymes sont inactivées au-dessus de 55-60°C. Assurez-vous que le système est correctement rempli et faire circuler jusqu’au décolmatage.
Conditionnement(s)
18713001
18713005
NOUVEAUTÉ
AVEZ-VOUS PENSÉ À…
KIT BONDE À BRETT
Pour plus d’informations, rendez-vous page 23
Conditionnement(s)
Barrique réf. 177406
Foudre réf. 192090
TANEX BARREL
Pour plus d’information, rendez-vous page 105
Conditionnement(s)
NOUS CONSULTER
1L réf.
5L réf.
FILTRATION TANGENTIELLE >> rendez-vous page 123 136 | HYGIÈNE DÉCOLMATER
Plan d’hygiène chloré
Cuves et Citernes Nettoyage - Dérougissage Quotidien
Inox, Polyester, Béton brut, Béton Verre, Céramique
Produit Fréquence Préparation (au dernier moment avant utilisation)
Application Temps de contact Rinçage
Deogen Après chaque utilisation 1 à 5% dans eau froide En circuit fermé 10 à 20 minutes Jusqu'à test de rinçage négatif
Détartrage - Dérougissage (tartre supérieur à 1 mm)
Produit Fréquence Préparation (au dernier moment avant utilisation)
Application Temps de contact Rinçage
Divosan TC 86 Après chaque utilisation 5% dans eau froide En circuit fermé 10 à 20 minutes Jusqu'à test de rinçage négatif Détartrage Annuel (tartre de 1 à 3 mm)
Produit Fréquence Préparation (au dernier moment avant utilisation)
Application Temps de contact Rinçage
Divoflow 50 5 à 20 % dans eau froide 5% dans eau froide En circuit fermé 20 à 40 minutes Jusqu'à test de rinçage négatif
Détartrage Annuel (tartre supérieur à 3 mm)
Produit Fréquence Préparation (au dernier moment avant utilisation)
Application Temps de contact Rinçage
Breltak Détartrage cuve > 1 an 50 à 100g/L dans eau froide En circuit fermé 20 à 40 minutes Jusqu'à test de rinçage négatif
Elimination des calcaires et oxydes de fer (une fois par an) sur extérieur de cuves Inox UNIQUEMENT
Produit Fréquence Préparation (au dernier moment avant utilisation)
Application Temps de contact Rinçage
Pascal Une fois par an 100g/L ou 10 % dans eau froide En pulvérisation ou mousse (avec ajout d'additif moussant ADD3 à 1%) mouiller le sol avant application pour éviter les traces sur le sol.
20 minutes Jusqu'à test de rinçage négatif
| 137 PLAN D’HYGIÈNE CHLORÉ
Plan d’hygiène chloré
Cuves
Bétons revêtues de Résine Epoxy et cuves Paraffinées

Désinfection - Dérougissage
Produit
Fréquence Préparation (au dernier moment avant utilisation)

Deogen Après chaque utilisation 1 à 5% dans eau froide
Application Temps de contact Rinçage
En circuit fermé 10 à 20 minutes Jusqu'à test de rinçage négatif
Divosan TC 86 Après chaque utilisation 5% dans eau froide En circuit fermé 10 à 20 minutes Jusqu'à test de rinçage négatif
Détartrage Annuel (tartre de 1 à 3 mm)
Produit Fréquence Préparation (au dernier moment avant utilisation)
Application Temps de contact Rinçage
Divoflow 50 5 à 20 % dans eau froide 5% dans eau froide En circuit fermé 10 à 20 minutes Jusqu'à test de rinçage négatif
Cuves
Acier revêtu
Désinfection - Dérougissage
Produit Fréquence Préparation (au dernier moment avant utilisation)
Application Temps de contact Rinçage
En circuit fermé 10 à 20 minutes Jusqu'à test de rinçage négatif Divosan TC 86 Après chaque utilisation 10 à 50 g/L dans eau froide (1 à 5%) En circuit fermé 10 à 20 minutes Jusqu'à test de rinçage négatif
Safeclean Après chaque utilisation 10 à 100g/L dans eau froide ou à 50°C
138 | HYGIÈNE PLAN D’HYGIÈNE CHLORÉ
POURQUOI CAP Vinicole hygiène de cave ?




Répondre à une demande croissante des metteurs en marché de la filière vin, liée aux forts enjeux de sécurité alimentaire, de certifications qualité demandées sur les marchés nationaux et internationaux.
Réduire l’impact de l’hygiène en cave sur les qualités organoleptiques finales du produit.
Les consultants Vitivalor® vous accompagnent pour mettre en place les démarches de certification, des validations des procédures d’hygiène au chai.
CAP Vinicole
Hygiène de cave, accompagnement à la mise en place de la démarche HACCP, certification IFS/BRC en conformité avec les cahiers des charges certifiants et environnementaux.
POUR QUELLES ACTIONS ?
Identification des points forts et des points sensibles sur chacune de vos étapes au chai.
Présentation d’un rapport de visite avec conseils pour la mise en place des actions correctives. Formation des salariés dans le cadre du cahier des charges et des actions correctives identifiées. Visites sur site : accompagnement à la mise en place de la traçabilité en cave, du plan d’hygiène et suivi des actions.
Vitivalor© Solutions, l’expertise Viti-Vinicole 360° E-mail : contact@vitivalor.com - www.vitivalor.com
WWW.VITIVALOR.COM | 139
Plan d’hygiène chloré
Surfaces diverses
Machines à vendanger, paniers, seaux, caisses, comportes, bennes, bacs, conquets de réception, vis, tapis, fouloirs, éra floirs, pressoirs pneumatiques, égouttoirs, extérieurs de cuves, de foudres bois, d’emplisseuse, grilles, supports de plaques de filtres...
Nettoyage - Dérougissage Quotidien
Produit
Fréquence Préparation (au dernier moment avant utilisation)
Divosan TC86 Au moins une fois par jour 5% dans eau froide
Application Temps de contact Rinçage
Par pulvérisation 15 à 20 minutes
Rénovation de fin de vendanges (si opérations de nettoyage quotidiens)
Produit
Fréquence Préparation (au dernier moment avant utilisation)
Enduro plus A la fin des vendanges ou des vinifications
Divers
10% dans eau froide. Renouveler l'opération après rinçage au surpresseur
Jusqu'à test de rinçage négatif
Application Temps de contact Rinçage
Par pulvérisation ou en mousse 20 à 40 minutes Eventuellement au surpresseur jusqu'à disparition de la mousse
Tuyauterie, circuits, Manches, Intérieur de Remplisseuses, Filtres à alluvionement, Filtres à tambour rotatif, Pompes, Centrifugeuses, Installation de traitements thermiques,…
Nettoyage- dérougissage Quotidien
Produit Fréquence Préparation (au dernier moment avant utilisation)
Application Temps de contact Rinçage
Deogen Après utilisation 1 à 5% dans eau froide En circuit fermé 10 à 20 minutes Jusqu'à test de rinçage négatif
Détartrage
Produit
Fréquence Préparation (au dernier moment avant utilisation)
Application Temps de contact Rinçage
Divoflow 50 Au moins une fois par jour 5% dans eau froide En circuit fermé 10 à 20 minutes Jusqu'à test de rinçage négatif
Nettoyage et Désinfection Externe des rinceuses et Remplisseuses
Produit Fréquence Préparation (au dernier moment avant utilisation)
Application Temps de contact Rinçage
Surefoam Quotidien 3% Par pulvérisation ou en mousse 15 minutes Jusqu'à disparition de la mousse
Désinfection des têtes de bouchage
Produit Fréquence Préparation (au dernier moment avant utilisation)
Divosan ETHA-Plus
Application Temps de contact Rinçage
Par
10 à 20 minutes Homologué sans rinçage
Quotidien Pur
Pulvérisation
140 | HYGIÈNE PLAN D’HYGIÈNE CHLORÉ
Installation de filtration : Après accord du fabricant
Filtre Tangentiel
Nettoyage - Dérougissage
Produit Fréquence Préparation (au dernier moment avant utilisation)
Divos 120 CL Après prélavage à l'eau froide 1 à 2% à 20°C
Application Temps de contact Rinçage
En circuit fermé 10 à 20 minutes Jusqu'à test de rinçage négatif
Divos 35 Après prélavage à l'eau froide 1 à 2% à 20°C En circuit fermé 10 à 20 minutes Jusqu'à test de rinçage négatif
Filtre à cartouche en Polysulfone, Nylon ou Polyether-sulfone
Nettoyage - Dérougissage
Produit Fréquence Préparation (au dernier moment avant utilisation)
Application Temps de contact Rinçage
Divos 120 CL Après prélavage à l'eau froide 0,5% à 1% de 20 à 50°C En circuit fermé 10 à 20 minutes Jusqu'à test de rinçage négatif
En cas de colmatage difficile, utiliser Divos ADD3 en additif à la solution de Divos 120 CL à 0,2%
Surfaces diverses
Plafonds, Murs, Sols, extérieurs de cuves
Rénovation
Produit Fréquence Préparation (au dernier moment avant utilisation)
Application Temps de contact Rinçage
Divosan TC86 Au moins une fois par jour 5% dans eau froide Par pulvérisation 20 à 40 minutes Jusqu'à test de rinçage négatif
Désinfection
Produit Fréquence Préparation (au dernier moment avant utilisation)
Application Temps de contact Rinçage
Divosan TC86 Hebdomadaire 1% dans eau froide Par pulvérisation 20 à 40 minutes Jusqu'à test de rinçage négatif
| 141 PLAN D’HYGIÈNE CHLORÉ
Détergents alcalins Produits d’hygiène
BRELTAK VC20 - 25kg 18264425 Poudre
BRELTAK PLUS - 25kg 11472625 Poudre
DIVOFLOW 50 VC99 20L : 18253320 200L : 182533U2 Liquide
SPECTAK G - 20LT 12662420 Liquide

DIVOS 123 - 25.6 KG 120968 Liquide
HD PLUS FOAM VF1 - 20L 18320620 Liquide Moussant
SAFECLEAN VK2 - 25kg 18414025 Poudre
SOFTSAFE VC19 - 20L 18413920 Liquide

ENDURO UNIPHASE - 20L 18046520 Liquide
Détergents & Désinfectants
Nom
DIVOSAN OMEGA HP VS42 - 20L 17583120 Liquide



SUREFOAM 22,4kg - 20L 180479 Liquide Moussant
DEOGEN VS7 - 20L 13566620 Liquide
DEOGEN VS7 - 950L 135666C3 Liquide

DIVOS 120CL - 20LT 12605820 Liquide
DIVOSAN TC 86 - 20L 14471020

dérougissant
Nom produit - conditionnement références aspect Chloré sans chlore code couleur etiq.
x x
x x
x x x
x x x
x x x
x x x
x x
x x x
x x
produit - conditionnement références aspect Chloré sans chlore code couleur etiq.
x x x
x x x
x x x
x x x
x x x
Liquide x x x
Nom produit - conditionnement références aspect Chloré sans code couleur Additif
142 | HYGIÈNE PRODUITS D’HYGIÈNE
Additif moussant
DIVOS
Désinfectants
DIVOSAN MULTIPLY
DIVOSAN QC VT50 - 20L
DIVOSAN HS 35 VT68 - 20L





DIVOSAN ETHA
-
0,75L
Détartrants membranes
Détergents acides
Autres produits
ELIFILM
Nom produit - conditionnement références aspect Chloré sans chlore code couleur etiq.
VT53
20LT 19117620 Liquide x x x
18798620 Liquide x x
188244C4 Liquide x x x
PLUS
: 185056CP 5L : 18505605 20 L : 18505620 Liquide x x
Nom produit - conditionnement références aspect Chloré sans chlore code couleur etiq. DIVOS 2 : 20LT 12823620 Liquide x x x DIVOS 35 : 20LT 12605920 Liquide x x x
Nom produit - conditionnement références aspect Chloré sans chlore code couleur etiq. ACICLEAN VK39 -20L 11472320 Liquide x x PASCAL VA5 - 20L 116210 Liquide x x x
Nom produit - conditionnement références aspect Chloré sans chlore code couleur etiq.
5 5KG : 19403205 20LT : 1940320 Liquide x x AF SILICON VB1 - 20L 13686220 Liquide x x x JONTEC COMBINET - 20L 13678920 Liquide x x
Nom produit - conditionnement références aspect Chloré sans chlore code couleur etiq.
ADD3 - 20.40KG 164414 Liquide x x x
| 143 PRODUITS D’HYGIÈNE
HYGIÈNE DE CAVE : Retrouvez dans les magasins Soufflet Vigne et auprès des conseillers et référents Vinextase® Oenologie vos matériels d’application, de stockage et Equipements de Protection Individuelle.







Direction de la publication
Patrice Lagarde - Soufflet Vigne
Responsables de la publication
Sandrine Berty, Guillaume Comte - Soufflet Vigne
Secrétariat de rédaction
Tatiana Duperon, Aude Lehner, Vincent Maffre - Soufflet Vigne
Conception/réalisation
Service marketing Soufflet Vigne
Crédit photos et références bibliographiques
Groupe Soufflet, Soufflet Vigne, Force-A, Allard Emballages, Amcor Flexibles, Amorim France, Antalis, Ebrocork, Microcell, O-I, PAPI, Rivercap France, Procork, Saverglass, Smurfit Kappa, Sparflex, Viallon Emballage, VSE Emballage, “P.Ertus, C.Jacob, P.Christine - HAL Id: hal-01599008“, Fotolia, iStockPhoto.
Remerciements
Les membres du Conseil Oenologique Vinextase : Marina Bely, Benoit Bach, Emmanuel Charpentier, Bertrand Chatelet, Yves Coutel, Pascal Henot, Michel Moutounet, Sébastien Pardaillé - Maison Mollex, Champagne Dosnon, Soufflet Biotechnologies, Vignobles de Larose, Stéphane Radoux, Cave Coopérative La Gaillarde, Stéphane Yerle, Dioenos Rhone, Domaine Henri Bourgeois - Chr. Hansen, Fermentis, Diversey.
Fabrication
JMVPub - Juillet 2019
PHOTOS ET DESCRIPTIFS PRODUITS NON CONTRACTUELS, INFORMATIONS SOUS RÉSERVE D’ERREURS TYPOGRAPHIQUES D’IMPRESSION ET ÉVOLUTIONS DES RÉFÉRENCES FOURNISSEURS.
www.vinextase.com














































 Voir page 49 [Fermentation Alcoolique]
Voir page 49 [Fermentation Alcoolique]

Densité trait plein ; Températures pointillés
Densité trait plein ; Températures pointillés






























 TÉLÉCHARGEZ
TÉLÉCHARGEZ




































































 SANS CHLORE
AVEC CHLORE Divosan® Multiply Divosan® Omega HP
Divodes Etha plus Divosan® Trace Divosan® HS35 Deogen Divosan TC 86
SANS CHLORE
AVEC CHLORE Divosan® Multiply Divosan® Omega HP
Divodes Etha plus Divosan® Trace Divosan® HS35 Deogen Divosan TC 86


































